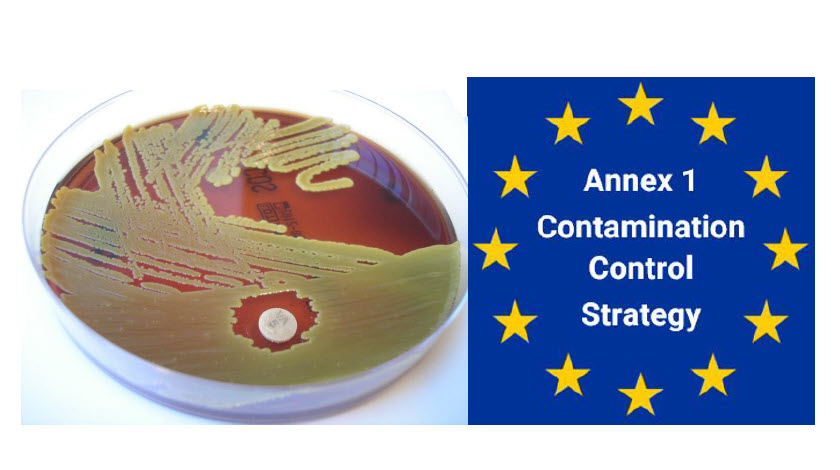
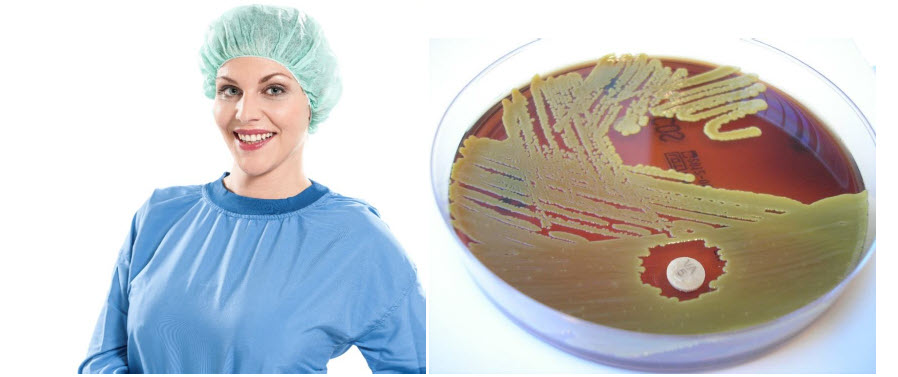
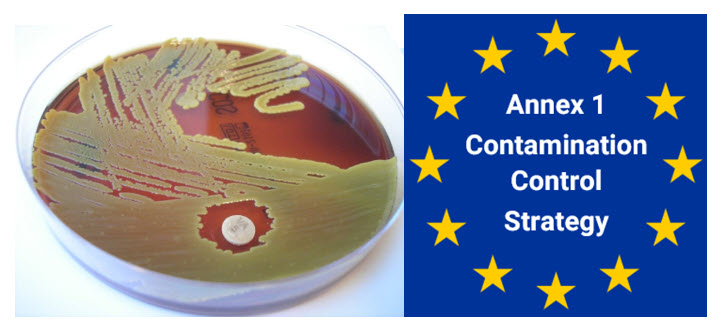
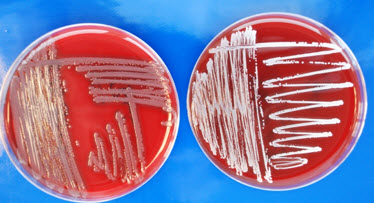
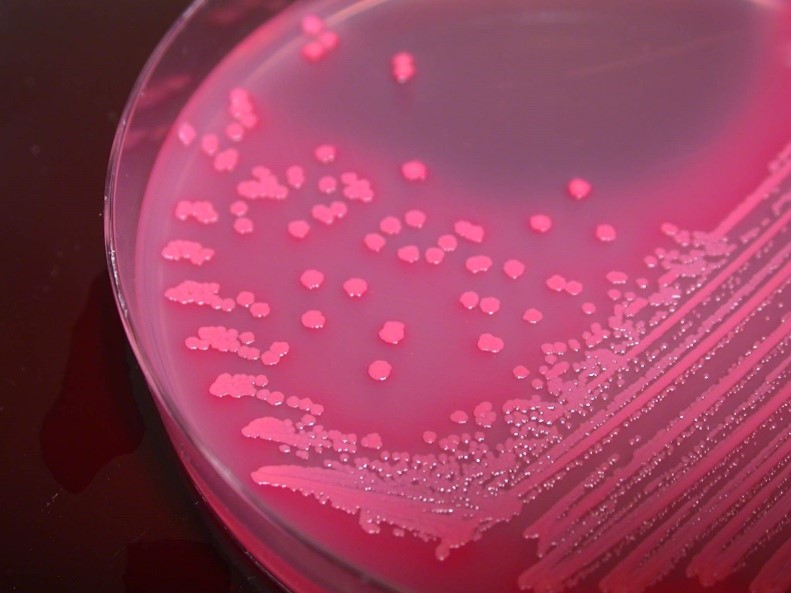
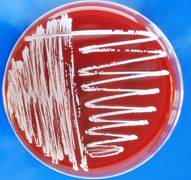

Blog
Inhouse-Schulung für die Mitarbeitenden einer Reinigungsfirma im Baselbiet
Im Rahmen der kontinuierlichen Qualitäts- und Hygienesicherung führte die Swiss Cleanroom Concept GmbH (Frank Zimmermann und Beatrice Tappenbeck) am 30. Juni eine Inhouse-Schulung für die Mitarbeitenden einer Reinigungsfirma im Baselbiet durch.
Reinräume neu gedacht: Warum ein Zelt besser sein könnte als eine teure Betonburg
Na klar, Reinräume sind die heiligen Hallen der Sauberkeit – hier werden nicht Erbsen gezählt, sondern Partikel. Alles muss stimmen, alles muss perfekt sein. Und wenn man an Reinräume denkt, kommen einem sofort diese sterilen, ultra-teuren Glas- und Stahlbauten in den Sinn. Doch was, wenn ein Zelt aus Stoff mindestens genauso gut ist wie die Betonburg? Ja, ganz genau – ein Zelt!
Inhouse Training im April und Juni 2026 Reinraum-Praxis
Inhouse Training am 22./24. April und 24./26. Juni 2026 Reinraum-Praxis. Über 80 Teilnehmer durfte Swiss Cleanroom Concept GmbH an diesen 4 Tagen schulen.
Reinraum-Expertice und Kapazitätserweiterung: NETZER GROUP setzt neue Standards in Pürgen
Das Vorarlberger Unternehmen NETZER GROUP, international bekannt für seine Kompetenz in Reinraumtechnik, hat erneut seine Stärke im Umgang mit anspruchsvollen Projekten unter Beweis gestellt. Am Standort Pürgen in Deutschland realisierte das Unternehmen einen neuen 151m² ISO7-Reinraum für die APM Technica AG, Spezialist für Klebe- und Oberflächentechnologie.
Exyte eröffnet neuen Standort in Lausanne
Ein weiterer Meilenstein für Exyte in der Schweiz: Mit der Eröffnung unseres neuen Büros in Lausanne stärken wir gezielt unsere Präsenz in einem der dynamischsten Life-Sciences-Märkte Europas.
Akkreditierung erreicht: Ellab Schweiz setzt neue Massstäbe im Kalibrierservice
Akkreditierung erreicht: Ellab Schweiz setzt neue Massstäbe im Kalibrierservice.
Sind Sie bereit für ein neues Level an Sicherheit und Compliance?
Kalibrierung bedeutet heute mehr als nur Präzision – entscheidend sind vor allem Nachvollziehbarkeit, Vertrauen und Audit-Sicherheit.
Wie eine 50 CHF Investition und wenige Minuten Aufwand tausende Probleme ersparen können
In der Welt der Partikelmessung entscheiden oft scheinbar unbedeutende Komponenten über die Qualität der Ergebnisse. Während wertvolle Messgeräte regelmässig gewartet und kalibriert werden, wird ein entscheidendes Element oft übersehen: der Bev-A-Line-Schlauch.
Energieeffizienter Reinraumbetrieb - Reduzierte Luftwechselrate im GMP-regulierten Umfeld
Wie lässt sich der Energieverbrauch im Reinraum nachhaltig senken, ohne regulatorische Anforderungen zu gefährden? Dieser Beitrag zeigt anhand eines Praxisbeispiels, wie die Einführung eines Absenkbetriebs umgesetzt werden kann – inklusive messbarer Ergebnisse und GMP-konformer Bewertung. Der zugrunde liegende Fachartikel erschien im März 2026 in Cleanroom & Processes und beleuchtet die temporäre Reduzierung der Luftwechselrate im Reinraum unter realen Bedingungen. Ein zentrales Ergebnis: Durch einen strukturierten, risikobasierten Ansatz ist es möglich, die Luftmengen gezielt zu reduzieren und gleichzeitig die Produktqualität sicherzustellen.
Inhouse Training am 27. und 28. Mai 2026 Annex 1 und CCS
Am 27. und 28. Mai 2026 führte die Swiss Cleanroom Concept GmbH bei einem führenden Pharmahersteller in der Nordwestschweiz zwei eintägige Inhouse-Schulungen zum Thema „EU GMP Annex 1 und Kontaminationskontrollstrategie (CCS)“ durch.
Seminartag: Datenintegrität in der GMP-Praxis
Am Mittwoch, den 6. Mai 2026 fand im Hotel Schützen in Rheinfelden das Seminar "Datenintegrität in der GMP-Praxis" statt.
LAUDA Ultratemp - Hochleistungs-Prozessthermostate für industrielle Temperieraufgaben
Die LAUDA Ultratemp Reihe steht für leistungsstarke und energieeffiziente Temperierung externer Verbraucher im Temperaturbereich von −5 bis +60 °C. Speziell entwickelt für anspruchsvolle Prozessumgebungen in der Biotechnologie und Industrie, gewährleisten die Systeme eine stabile Temperaturführung mit einer Regelgenauigkeit von bis zu ±0,5 K – auch bei grossen Applikationsvolumina.
Seminartag: GMP-Grundlagen für Neueinsteiger in der Pharma, Medtech und Spitalpharmazie
Am Donnerstag, den 30. april 2026 fand im Hotel Schützen das Seminar:"GMP-Grundlagen für Neueinsteiger in der Pharma, Medtech und Spitalpharmazie" statt.
Warum die Quarzmikrowaage weit über den Reinraum hinaus Massstäbe setzt
In der Reinraumtechnik ist Präzision kein Luxus, sondern die Existenzgrundlage. Doch während wir uns oft auf die Abwesenheit von Partikeln konzentrieren, eröffnet die Quarzmikrowaage (QCM) eine völlig neue Dimension der Kontrolle: die Messung von Massenänderungen im Nanogrammbereich. Das ist nicht nur für das Monitoring von Reinräumen entscheidend, sondern der Schlüssel für Innovationen in der Biotech- und Energieforschung.
Seminartag: Reinraum-Qualifizierung und Monitoring nach ISO 14644 in Wattwil
Am Mittwoch, den 29. April 2026 fand bei der Firma Particle Measuring Systems in Wattwil das Seminar "Reinraum-Qualifizierung und Monitoring nach ISO 14644" statt.
ESD im Reinraum: Risiken, Ursachen und Lösungen
ESD steht für „Electrostatic Discharge“ (elektrostatische Entladung) und bezeichnet den plötzlichen Ausgleich elektrischer Ladungen zwischen unterschiedlich geladenen Objekten. Solche Entladungen stellen insbesondere für empfindliche elektronische Bauteile ein erhebliches Risiko dar, da sie diese beschädigen oder vollständig zerstören können.
Akkreditierung erreicht: Ellab Schweiz setzt neue Maßstäbe im Kalibrierservice
Sind Sie bereit für ein neues Level an Sicherheit und Compliance?
Kalibrierung bedeutet heute mehr als nur Präzision – entscheidend sind vor allem Nachvollziehbarkeit, Vertrauen und Audit-Sicherheit.
Moderne Schimmelpilz-Identifizierung mit MALDI ToF-Massenspektrometrie
Die präzise und vor allem schnelle Identifizierung von Schimmelpilzen gewinnt zunehmend an Bedeutung, gleichzeitig stößt die klassisch-kulturelle Methode an ihre Grenzen. Um seinen Kunden weiterhin fundierte und zuverlässige Ergebnisse liefern zu können...
MySirius - Drahtloses Überwachungssystem von JRI
Die cloudbasierte Temperaturüberwachungslösung* ist für eine Vielzahl von Anwendungen geeignet. Wie die Überwachung von Reinräumen, Lagerräumen, Lagerhäusern, Kühlräumen, thermostatische oder klimatische Kammern, Kühlschränken, Gefrierschränken, Inkubatoren u.v.m.
Moqlero - Trending auf Knopfdruck
Warum jetzt der richtige Zeitpunkt zum Umdenken ist. Mit der Überarbeitung des EU GMP Annex 1 im Jahr 2022 ist systematisches Trending von Monitoring-Daten zur regulatorischen Pflicht geworden. Was lange als optionales Qualitätswerkzeug galt, ist heute ein zentrales Element der Compliance – und rückt damit in den Fokus von Qualitätssicherung, Produktion und Inspektionen gleichermaßen
30. Swiss Cleanroom Community Event
Am 27. April 2026 fand das 30. Swiss Cleanroom Community Event in Pratteln statt. Ein neuer Rekord bei den Anmeldungen wir erhielten mehr als 400 Anmeldungen. Diese vertraten über 210 Firmen.
Seminartag: Mikrobiologie im GMP-Umfeld
Am Mittwoch, 8. April 2026 fand im Hotel Schützen in Rheinfelden das Seminar "Mikrobiologie im GMP-Umfeld" statt.
Seminartag: Reinraum Basiswissen
Am Donnerstag, 9. April 2026 fand im Hotel Schützen in Rheinfelden das Seminar "Reinraum Basiswissen" statt.
Seminar Reinraumlufttechnik, Risikoanalyse und Qualifizierung
Am Donnerstag den 12. März 2026 fand in Unterägeri bei der Firma Camfil AG das Seminar Reinraumlufttechnik, Risikoanalyse und Qualifizierung statt.
Seminar Reinstwasser im GMP-Umfeld
Am Dienstag den 10. März 2026 fand bei der Firma BWT AQUA Pharma & Biotech in Aesch das Seminar Reinstwasser im GMP-Umfeld inkl. Werksbesichtigung statt.
Intensivseminar für Reinraum-Quereinsteiger
Am 03. und 04. März 2027 fand im Hotel Schützen das Intensivseminar für Reinraum-Quereinsteiger statt.
Einladung zum 30. Swiss Cleanroom Community Event
Herzlich willkommen zum 30. Swiss Cleanroom Community Event
Besuchen Sie dieses Event kostenlos am 27. April 2026 in Pratteln
Seminar: Anforderungen an die FvP im GMP-Umfeld
Am Donnerstag, 26. Februar fand im Hotel Schiff in Rheinfelden das Seminar Anforderungen an die FvP im GMP-Umfeld statt.
Seminar: Reinraumbau, Technik, Betrieb und Unterhalt
Am Mittwoch, 25. Februar fand im Hotel Schiff in Rheinfelden das Seminar Reinraumbau, Technik, Betrieb und Unterhalt statt.
Reinraum Praxisseminar
Am Dienstag, 24. Februar fand im Hotel Schiff in Rheinfelden und Reinraum der Firma avintos das Reinraum Praxisseminar statt.
Seminar: Anforderungen an die Dampfsterilisation im GMP-Umfeld
Am Mittwoch, 18. Februar fand im hotel Schützen in Rheinfelden das Seminar: Anforderungen an die Dampfsterilisation im GMP-Umfeld statt.
Dein Karriereportal für Pharma & Medtech
Du willst in der Pharma- oder Medtech-Industrie arbeiten und suchst nach einer Position, die wirklich zu deiner Expertise passt?
Unser spezialisiertes Job-Portal bringt dich direkt mit führenden Unternehmen, innovativen Start-ups und internationalen Konzernen aus Pharma und Medizintechnik zusammen.
Präzisionsmessungen in Life-Science-Reinräumen
Wie Vaisala Origo dort Kontrolle liefert, wo es am meisten zählt.
Wenn die Umgebungsbedingungen in einem Reinraum auch nur um einen Bruchteil eines Grades abweichen, können die Folgen schwerwiegend sein. In Life-Science-Reinräumen kann jeder kritische Umgebungsparameter wie Temperatur oder....
Seminar:Effizientes Projektmanagement bei Um- und Neubau von Reinräumen
Am Mittwoch, 04. Februar 2026 fand im Hotel Schiff in Rheinfelden das Seminar:Effizientes Projektmanagement bei Um- und Neubau von Reinräumen statt.
Seminar: Train the Trainer im GMP-Umfeld
Am Dienstag, 03. Februar 2026 fand im Hotel Schiff in Rheinfelden das Seminar: Train the Trainer im GMP-Umfeld statt.
Plair SA extends its distribution network by partnering with Merck to bring Rapid-C+ to 100+ countries worldwide!
Following the signing of an exclusive distribution agreement with MBV AG for Switzerland, Germany, and Austria (DACH region), Plair SA is thrilled to announce its partnership with Merck to bring Rapid-C+, a real-time viable particle counter, to 100+ countries worldwide.
Newsletter Winter 2025/26
In der Stille und Geduld des Winters liegt die Kraft für das Neue. (Monika Minder).
Nutzen Sie die Zeit zum Lesen unseres Winters-Newsletters.
Das Swiss Clearnoom Concept-Team wünscht Ihnen viel Spass beim lesen.
Auf Ihr Feedback mit unserer Kommentar- und Like-Funktion sind wir gespannt.
Seminar: Reinigungs- und Desinfektionsstrategie für reine Räume
Am Donnerstag, den 4. Dezember fand das Seminar: Reinigungs- und Desinfektionsstrategie für reine Räume in Rheinfelden statt.
Hygiene Knowledge at a Glance
Ein Überblick über zentrale Aspekte der Reinraumhygiene
Die mikrobiologische Qualifizierung von Reinräumen und kontrollierten Bereichen bildet einen...
KI-unterstützte Dienstleistungen im GMP-regulierten Umfeld
gempex und msg industry advisors kooperieren im Bereich KI-unterstützte Dienstleistungen im GMP-regulierten Umfeld
- GxP- und IT-Expertise für zukunftsweisende Lösungen
- Qualitätssicherung: effizienter, zielgerichteter und sicherer
Inhouse Schulung von über 90 Mitarbeitern
Vom Montag den 22. bis Donnerstag 27. November inkl. Montag den 1. Dezember durften wir mit Inhouse Schulungen über 90 Mitarbeiter im Rahmen des jährliche GMP Refreshers schulen.
Inhouse-Schulung zum Thema Reinraum - Praxis
Am Freitag, den 28. November durften wir von Swiss Cleanroom Concept GmbH bei einem grossem Reinraum Reinigungsdienstleister eine Inhouse-Schulung zum Thema Reinraum – Praxis durchführen.
Wie risikobasierte CQV-Services Effizienz steigern & Compliance sichern
Sie wollen Validierungsprozesse beschleunigen, Ressourcen sparen und gleichzeitig GMP-konform arbeiten? Mit risikobasierten CQV-Services erreichen Sie genau das – durch gezielte Risikoanalysen, effiziente Prozesse und eine belastbare Dokumentation.
Seminar Computervalidierung und Datenintegrität
Am Donnerstag den 20. November 2025 fand im Hotel Schiff in Rheinfelden das Seminar Computervalidierung und Datenintegrität statt.
Seminar Smoke Studies und Computersimulationen in der Reinraumtechnik
Am Mittwoch den 19. November 2025 fand im Hotel Schützen in Rheinfelden das Seminar Studies und Computersimulationen in der Reinraumtechnik statt.
Seminar Erfolgreiche Teamführung im Reinraum
Am Dienstag den 18. November 2025 fand im Hotel Schützen in Rheinfelden das Seminar Erfolgreiche Teamführung im Reinraum statt.
Seminar GMP-Aufbauwissen
Am Mittwoch den 13. November 2025 fand im Hotel Schiff in Rheinfelden das Seminar GMP-Aufbauwissen statt.
Aktuelle Vorgabedokumente für Hygiene in reinen Räumen
Für Betreiber von reinen Räumen und Qualitätsicherungsverantwortliche Personen ist es von entscheidender Bedeutung zu wissen, welche Vorgabedokumente, Normen und Guidance, weltweit relevant sind, wenn es um «Hygiene in reinen Räumen» (Cleanrooms) geht. Wir geben Ihnen nachfolgend eine Übersicht der wichtigsten Neuerungen, mit Fokus auf regulatorische und normative Entwicklungen.
Seminar Anforderungen an Excel im GMP-Umfeld
Am Dienstag den 11. November 2025 fand im Hotel Schützen in Rheinfelden das Seminar Anforderungen an Excel im GMP-Umfeld statt.
Seminar Reinigungsvalidierung im GMP-Umfeld
Am Mittwoch den 05. November 2026 fand im Hotel Schützen das Seminar Reinigungsvalidierung im GMP-Umfeld statt.
Newsletter Herbst 2025
Herbstzeit ist Erntezeit - die Natur schenkt uns Fülle und erinnert uns an die Zyklen des Lebens.
Für diesen Herbstnewsletter haben wir viel ernten dürfen, damit Sie liebe Leser, wieder auf dem neusten Stand sind.
Das Swiss Clearnoom Concept-Team wünscht Ihnen viel Spass beim lesen.
Auf Ihr Feedback mit unserer neuen Kommentar- und Like-Funktion sind wir gespannt.
29. Swiss Cleanroom Community Event
Bereits ist das 29. Swiss Cleanroom Community Event in Pratteln wieder Geschichte.
Wir durften uns über 56 Aussteller und über 370 Teilnehmern von über 180 Firmen an diesem Frühlingsevent freuen.
Filtergängige Bakterien - Risiko bei der aseptischen Herstellung
Unter bestimmten Bedingungen können selbst intakte und validierte Sterilfilter mikrobiologische Durchgänge zulassen – ein Phänomen, das in der aseptischen Herstellung häufig unterschätzt wird. Diese filtergängigen Bakterien stellen...
Intensivseminar für Reinraum-Quereinsteiger
Am 28. und 29. Oktober 2025 fand im Hotel Schiff in Rheinfelden das Intensivseminar für Reinraum-Quereinsteiger statt.
Seminar Monitoring in reinen Räumen
Am Donnerstag, 23. Oktober 2025 fand im Hotel Schützen in Rheinfelden das Seminar Monitoring in reinen Räumen statt.
Seminar GMP-Basiswissen
Am Mittwoch, 22. Oktober 2025 fand im Hotel Schützen in Rheinfelden das Seminar GMP-Basiswissen statt.
Schluss mit wiederholten Gefrierschrank-Studien: TrackSense Frigo UX Sky
Gefrierschrank-Qualifizierungen und Revalidierungen sind oft zeitaufwendig. Eine einzige fehlgeschlagene Studie – oft erst am Ende einer mehrtägigen Messreihe entdeckt – kann Projekte um Tage oder Wochen verzögern.
Mini-Industriesauger für brennbaren Staub und gefährlichen Staub
Nilfisk VHS010 und VHS011 Z22 EXA: Mini-Industriesauger für brennbaren Staub und gefährlichen Staub in der Zone Z22
Seminar Anforderungen an pharmazeutische Gase
Am Dienstag14. Oktober 2025 fand im Hotel Schützen in Rheinfelden das Seminar "Anforderungen an pharmazeutische Gase" statt.
Seminar Anforderungen an die Qualifizierung im GMP-Umfeld
Am Donnerstag 16. Oktober 2025 fand im Hotel Schützen in Rheinfelden das Seminar "Anforderungen an die Qualifizierung im GMP-Umfeld" statt.
Inhouse Training in einem der grössten Spitälern in der Schweiz
Am 24. und 25. September 2025 durften wir von Swiss Cleanroom Concept in einem der grössten Spitälern in der Schweiz die Reinigung und die Spitalpharmazie schulen.
Inhouse Training von über 150 Personen
Im August durften wir von Swiss Cleanroom Concept über 150 Personen bei einem grossen Hersteller von Medical Devices im Rahmen von Inhouse Trainings schulen.
Why loop calibration is the best way to ensure sensor accuracy
Production in cleanrooms and dry rooms requires accurate sensors to guarantee product quality and ensure regulatory compliance. That means regular calibration is a must. Loop calibration is a way to...
Seminar: Audits und Inspektionen erfolgreich bestehen
Am 11. September 2025 fand im Hotel Schützen in Rheinfelden das Seminar: Audits und Inspektionen erfolgreich bestehen statt.
Reinraum Intensivseminar
Am 09. und 10. September 2025 fand im Hotel Schützen in Rheinfelden das Reinraum Intensivseminar statt.
Seminar Sicherer Umgang mit Zytostatika
Am 04. September 2025 fand in Allschwil bei der Firma Skan AG das Seminar Sicherer Umgang mit Zytostatika statt. Der Seminartag begann mit Frank Zimmermann von der Firma Swiss Cleanroom Concept mit den Themen: Was ist Zytostatika und Parenteralia
Seminar Anforderungen an Single use Systeme
Am 02. September 2025 fand im Hotel Schützen in Rheinfelden das Seminar Anforderungen an Single use Systeme statt.
Seminar Annex 1 Kontaminationskontrollstrategie sinnvoll umsetzen
Am Donnerstag, 28. August 2025 fand im Hotel Schützen das Seminar Annex 1 Kontaminationskontrollstrategie sinnvoll umsetzen statt. Den Seminartag eröffnete Frank Zimmermann
Seminar: Qualifizierung von Anlagen und Utilities im GMP-Umfeld
Am Mittwoch, 27. August 2025 fand im Hotel Schützen in Rheinfelden das Seminar: Qualifizierung von Anlagen und Utilities im GMP-Umfeld statt.
Reinraum Praxisseminar
Am Dienstag, 26. August 2025 fand im Hotel Schützen das Reinraum Praxisseminar statt. Der Seminartag startete mit dem Thema Schutzkonzepte für...
Particle Measuring Systems zieht von Boulder nach Niwot, Colorado um
Niwot, Colorado – 21. August 2025 – Particle Measuring Systems gibt stolz die Eröffnung
Reinraumkontrolle: Wie Sie Compliance sichern & Risiken senken
Haben Sie Ihren Reinraum wirklich unter Kontrolle? Frühwarnzeichen wie Sensorabweichungen oder Kalibrierverzögerungen bleiben oft unbemerkt. Lesen Sie, wie eine nachhaltige Reinraumkontrolle gelingt.
Wir wünschen Ihnen einen schönen Nationalfeiertag am 1. August
"Vom Gipfel der Alpen gleicht die Schweiz einem Garten; vom Gipfel des Denkes gleicht die Schweiz einer Erzählung." Théodore Simon Jouffroy
How to Help Mitigate Contamination in Pharmaceutical Cleanrooms
In the pharmaceutical industry, contamination control efforts often focus on eye-level, hand-level, and operational areas. While these visible spaces receive significant attention, a major oversight persists in floor-level contamination.
Praxis-Schulungen neu im Reinraum in Rheinfelden
Neu können wir (Swiss Celanroom Concept GmbH) unsere Reinraum-Seminare, bei denen wir den Teiilnehmern praxtische Einblicke beim Ein- und Ausschleusen, Verhalten, Reinigung und Desinfektion im Reinraum geben, im Reinraum der Firma avintos AG, in Rheinfelden durchführen.
8 Ways to Keep Your Cleanroom Free of Contamination
Keeping your cleanroom free of contaminants is an important part of your operation, regardless of your industry. Implementing a solid contamination control strategy (CSS) is your best defense against the costly risks of tainted products and reputation damage.
Sichere Luftdesinfektion für Reinräume
Automatisiert. Validiert. BPR-konform.
Automatisierte Luftdesinfektionssysteme sind ein entscheidender Bestandteil zur Gewährleistung mikrobiologischer Sicherheit in Reinräumen, Laboren und sensiblen Produktionsbereichen
Biofilme, die unsichtbare Gefahr
und wie man diese effektiv mit antimikrobiellem blauem Licht (abl) der Spectral Blue™ Geräte bekämpfen kann.
Aktive mikrobielle Luftkeimsammlung der nächsten Generation
Mit dem MAS-100 Sirius® führt die MBV AG den Nachfolger des MAS-100 NT® ein – dem weltweit meistverkauften aktiven Luftkeimsammler.
Der agarbasierte Luftkeimsammler setzt einen neuen Standard in der Überwachung mikrobieller Luftkontamination von nicht kontrollierten sowie kontrollierten Umgebungen wie pharmazeutischen Reinräumen.
Newsletter Sommer 2025
Das Leben ist wie Eiscreme. Geniess es, bevor es dahinschmilzt.
Wir haben Ihnen einen bunten Sommer-Newsletter zusammengestellt.
Viel Spass beim Lesen wünscht Ihnen, Ihr
Swiss Cleanroom Concept-Team
gempex China stärkt globale Pharma-Expansion
Seit 2005 ist gempex zum Thema GMP-Compliance in China aktiv, seit 2014 mit einer hundertprozentigen Tochter-gesellschaft. 23 Jahre fundierte Erfahrung stehen damit an den wichtigsten Standorten – Deutschland, Schweiz und China – länderübergreifend zur Verfügung.
LS-pedia für Kunden - seit einem Jahr kostenloser Zugriff auf mikrobiologisches Fachwissen
Die Mikrobiologen von Labor LS entwickelten 2020 die Wissensdatenbank LS-pedia – ein stetig wachsendes Nachschlagewerk für typische Keime der (Bio-)Pharmaindustrie.
9 Tips to Improve Your Contamination Control Strategy (CCS)
A Contamination Control Strategy (CCS) is a systematic approach designed to minimize contamination risks across various environments, particularly in biotechnology, food production, healthcare and pharmaceutical manufacturing industries.
Eine zweite Woche mit Temperaturen im mittleren 30er Bereich
Unseren Technikern der Firma Imtech Steri AG ist dies nicht heiss genug, daher Arbeiten sie mit Autoklaven.
ABN Cleanroom Technology introduces StepIn
Cleanroom infrastructure often requires significant upfront investment. Something not every company can (or wants to) take on.
Seminar Datenintegrität im Fokus der Behörde
Am Mittwoch, 04. Juni 2025 fand im Hotel Schützen in Rheinfelden das Seminar Datenintegrität im Fokus der Behörde statt.
1. Swiss Cleanroom Symposium am 7. September 2026
Aufgrund der grossen Nachfrage, noch intensiver Themen rund um den Reinraum in einem grösseren Fachkreis zu diskutieren, werden wir nächstes Jahr am 7. September 2026 das 1. Swiss Cleanroom Symposium durchführen.
ATP-basierte Prüfung auf Sterilität bei Labor LS
Um seinen Kunden stets maßgeschneiderte Lösungen und zeitgemäße Analysen bieten zu können, arbeitet Labor LS bereits seit über 15 Jahren kontinuierlich an der Einführung und Validierung von neuen alternativen mikrobiologischen Schnellmethoden (RMM).
Verlässliche Probenlogistik für Schweizer Kunden - Labor LS erweitert Aktivitäten
Als eines der größten unabhängigen Auftragslabore in Europa bietet Labor LS über 1.000 Kunden analytische Dienstleistungen nach cGMP-Standards in den Bereichen Mikrobiologie, Biochemie, Molekularbiologie sowie chemisch-physikalische Analytik.
Sommer-Mapping-Studien für pharmazeutische Integrität
Die Integrität und Wirksamkeit von temperaturempfindlichen Produkten stehen während der heißen Sommermonate auf dem Spiel. Deshalb ist es entscheidend, sich rechtzeitig auf Sommer-Mapping-Studien zu konzentrieren, um...
Newsletter Frühling 2025
Frühling ist, wenn die Seele wieder bunt denkt.
Wir haben mit Ihren Beiträgen einen bunten Frühlings-Newsletter zusammengestellt.
Viel Spass beim Lesen wünscht Ihnen , Ihr Swiss Cleanroom Concept-Team
Buchen Sie jetzt Ihre Inhouse Schulung
Sie und Ihr Team suchen nach einer Inhouse Schulung, wo die Themen behandelt werden, die Sie für den Erhalt der Qualität benötigen. Oder Sie hatten eine Abweichung oder sogar einen Inspektionsmangel, den Sie dringend beheben müssen.
Kein Problem. Sie wählen die Themen, setzen Schwerpunkte, und wir bringen Sie und Ihr Team sicher an das gewünschte Ziel.
Seminar Reinraum Qualifizierung und Monitoring nach ISO 14644
Am Mittwoch, 23. April 2025 fand in Wattwil bei der Firma Particle Measuring Systems AG das Seminar Reinraum Qualifizierung und Monitoring nach ISO 14644 statt.
Seminar Reinraum-Basiswissen
Am Donnerstag, 10. April 2025 fand im Hotel Schützen in Rheinfelden das Seminar Reinraum-Basiswissen statt.
Dienstleistungen der ESTERIL AG
in diesem Beitrag möchten wir Ihnen die Dienstleistungen der ESTERIL AG vorstellen,
28. Swiss Cleanroom Community Event
Bereits ist das 28. Swiss Cleanroom Community Event in Pratteln wieder Geschichte.
Wir durften uns über 56 Aussteller und über 370 Teilnehmern von über 180 Firmen an diesem Frühlingsevent freuen.
Seminar Mikrobiologie im GMP-Umfeld
Am Donnerstag, 03. April 2025 fand im Hotel Schützen in Rheinfelden das Seminar Mikrobiologie im GMP-Umfeld statt.
Seminar Reinstwasser im GMP-Umfeld
Am Dienstag 18. März 2025 fand im Seminarraum der Firma BWT Schweiz AG in Aesch mit Besichtigung der Produktionshalle das Seminar Reinstwasser im GMP-Umfeld statt.
Seminar Anforderungen an die QA-Oversight
Am Mittwoch 19. März 2025 fand im Hotel Schützen in Rheinfelden das Seminar Anforderungen an die QA-Oversight statt.
Seminar Risikomanagement - ICH Q9 in der Pharmaindustrie
Am 11. März 2025 fand im Hotel Schützen in Rheinfelden das Seminar Risikomanagement – ICH Q9 in der Pharmaindustrie statt.
Ellab neu definiert: Ihr Life-Science-Compliance-Partner
Die Neuausrichtung von Ellab markiert unseren Schritt zu einem globalen Anbieter für End-to-End-Compliance-Lösungen – und verändert die Art und Weise, wie wir mit der Life-Science-Branche zusammenarbeiten.
Intensivseminar für Reinraum-Quereinsteiger
Am 5. und 6. März 2025 fand in Rheinfelden im Hotel Schützen das Intensivseminar für Reinraum-Quereinsteiger statt.
Seminar Anforderungen an die Sterilisation
Am 27. Februar 2025 fand das Seminar Anforderungen an die Sterilisation im Hotel Schützen in Rheinfelden statt.
Seminar Anforderungen an die Dampfsterilisation
Am 26. Februar 2025 fand das Seminar Anforderungen an die Dampfsterilisation im Hotel Schützen in Rheinfelden statt.
Seminar Schutzkonzepte für Mitarbeiter in der Pharma-Industrie
Am 25. Februar 2025 fand zum fand zum ersten Mal das Seminar Schutzkonzepte für Mitarbeiter in der Pharma-Industrie mit Praxisteil bei der Firma Praevena AG in Rheinfelden statt.
Seminar Learnings durch den neuen Annex 1
Am Dienstag, 04. Februar 2025 fand im Hotel Schützen in Rheinfelden mit 16 Teilnehmern das Seminar Learnings durch den neuen Annex 1 statt.
ZETAs modulares Buffer Inline Conditioning System
Die ZETA Gruppe ist mit rund 1200 Beschäftigten und 27 Standorten weltweit auf das Design, den Bau, die Automatisierung, die Digitalisierung und die Qualifizierung kundenspezifischer biopharmazeutischer Anlagen für aseptische Prozesslösungen spezialisiert.Dabei agiert ZETA als One-Stop-Shop, der neben dem Anlagenengineering auch die Planung der HVAC-, Reinraum- und Gebäudetechnik unter einem Dach vereint.
Newsletter Winter 2024/25
Es ist nicht wenig Zeit, die wir haben, sondern es ist viel Zeit, die wir nicht nutzen.
Nutzen Sie die Zeit zum Lesen unseres Winters-Newsletters.
Ihr Swiss Cleanroom Concept-Team wünscht Ihnen dabei viel Neugier
Monitoringsystem für das Stammzell- und -Immunlabor des Universitätsklinikum Tübingen
In diesem Projekt wurde ein umfassendes Upgrade eines Monitoringsystems durchgeführt, das für die Überwachung kritischer Umgebungsparameter wie Druck und Feuchtigkeit zuständig ist.
Cleanroom disinfection - press a button get a clean room
Cleanroom disinfection with the autonomous disinfection robot, aseptobot. very fast process time, fully automatic, easy-to-operate and with a automatically generated GMP documentation.
Energieeffizienter Reinraumbetrieb -Messtechnik & Compliance
Die Verbesserung des Energieverbrauchs in Reinräumen ist von zentraler Bedeutung für die Nachhaltigkeit und die Steigerung der Energieeffizienz in der pharmazeutischen Industrie.
Nachfolgeregelung bei der Durrer Technik AG
Nachfolgeregelung bei der Durrer Technik AG ab 1.1.2025
Warum GMP-konforme Funk-Monitoringsysteme eine smarte Wahl sind
Die Überwachung kritischer Umgebungsparameter wie Temperatur, Luftfeuchte oder Differenzdruck spielt in der pharmazeutischen Industrie eine zentrale Rolle. Ob bei der Lagerung empfindlicher Produkte oder der Einhaltung regulatorischer Anforderungen – zuverlässige Monitoringlösungen sind essenziell.
Happy new year
Das Swiss Cleanroom Concept-Team wünscht allen einen guten Rutsch in ein erfolgreiches 2025.
Es weihnachtet sehr...
Liebe SCC-Partner und liebe SCC-Community
… und es sind nicht die Geschenke die Weihnachten ausmachen,
Präzises Monitoring leicht gemacht - mit TrackView Pro
Mit dem TrackView Pro Monitoring System von Ellab haben Sie Ihre kritischen Umgebungsparameter wie Temperatur, Luftfeuchtigkeit und CO2 stets im Blick – in Echtzeit und absolut zuverlässig.
Seminar Smoke Studies und Computersimulationen in der Reinraumtechnik
Am 27. November 2024 fand im Hotel Schützen das Seminar Studies und Computersimulationen in der Reinraumtechnik statt.
Seminar Teamführung im Reinraum
Am 26. November 2024 fand im Hotel Schützen das Seminar Teamführung im Reinraum mit 13 Teilnehmern statt.
15 Jahre Swiss Cleanroom Concept GmbH
Swiss Cleanroom Concept GmbH feiert sein 15 jähriges Jubiläum. Erfahren Sie mehr über uns in unserem neuen Erklärvideo.
Seminar Effizientes Projektmanagement bei Reinraum Um- und Neubau
Am 14. November 2024 fand im Hotel Schützen das Seminar Effizientes Projektmanagement bei Reinraum Um- und Neubau statt.
Seminar Audits und Inspektionen erfolgreich bestehen
Am 12. November 2024 fand im Hotel Schützen das Seminar Audits und Inspektionen erfolgreich bestehen statt.
27. Swiss Cleanroom Community Event
Bereits ist das 27. Swiss Cleanroom Community Event in Pratteln wieder Geschichte.
Wir durften uns über 56 Aussteller und 370 Teilnehmer von über 160 Firmen an diesem Herbstevent freuen.
Newsletter Herbst 2024
"Der Herbst ist eine zweite Chance, um die Schönheit der Natur zu bewundern". (Unbekannt)
Schön und bunt ist der Herbst, so wie auch dieser Herbst-Newsletter...
Intensivseminar für Reinraum-Quereinsteiger
Am 30. und 31. Oktober 2024 fand im Hotel Schützen das Intensivseminar für Reinraum Quereinsteiger statt.
Seminar Monitoring in reinen Räumen
Am Donnerstag, 24. Oktober 2024 fand bei der Firma Bioexam AG in Luzern das Seminar Monitoring in reinen Räumen statt.
Seminar GMP-Basiswissen
Am 23. Oktober 2024 fand im Hotel Schützen in Rheinfelden das Seminar GMP-Basiswissen statt. Die Seminarteilnehmer bekamen einen vollen Themenkorb vermittelt.
Seminar Anforderungen an die Reinraum-Lufttechnik
Am Dienstag, 22. Oktober 2024 fand bei der Firma Camfil AG am Unterägeri See mit 14 Teilnehmern das Seminar Anforderungen an die Reinraum-Lufttechnik statt.
Seminar Reinraumbau, Technik Betrieb und Unterhalt
Am Dienstag, 16. Oktober 2024 fand im Hotel Schiff mit 16 Teilnehmern das Seminar Reinraumbau, Technik Betrieb und Unterhalt statt.
Reinraum Intensivseminar
Am 10. und 11. September 2024 fand im Hotel Schützen in Rheinfelden das 2-tägige Reinraum Intensivseminar statt.
Seminar Sicherer Umgang mit Zytostatika
Am 05. September 2024 fand in Allschwil bei der Firma Skan AG das Seminar Sicherer Umgang mit Zytostatika statt. Die korrekte Handhabung von Zytostatika stellt uns vor große Herausforderungen – die Wirkstoffe sind hochaktiv und ihr Gefahrenpotential am Arbeitsplatz nimmt stetig zu.
Seminar Anforderungen an Single use Systeme
Am 04. September 2024 fand im Hotel Schützen in Rheinfelden das Seminar Anforderungen an Single use Systeme statt. Das Thema Single use Systeme entwickelt sehr start, lesen Sie weiter, was die Teilnehmer am Seminar alles an Informationen erfahren durften.
Reinraum Praxisseminar
Am 29. August 2024 fand im Hotel Schützen in Rheinfelden das Reinraum Praxisseminar statt. Die Seminarteilnehmer konnten unter anderem die verschiedenen Reinraumkleidern im Praxisteil die Vor- und Nachteile hautnah erfahren.
Seminar Qualifizierung von Anlagen und Utilities im GMP-Umfeld
Am 28. August 2024 fand im Hotel Schützen in Rheinfelden das Seminar Qualifizierung von Anlagen und Utilities im GMP-Umfeld statt. Die Seminarteilnehmer bekamen ein vollen Themenkorb vermittelt.
Effektive Reinrau-Dekontaminaition mit Wasserstoffperoxid
Um sicherzustellen, dass der Herstellungsprozess den geltenden gesetzlichen Vorschriften und Richtlinien sowie dem aktuellen Stand der Wissenschaft und Technik entspricht, sind sterile Produkte besondere Produktions- und Umgebungsanforderungen unterworfen.
Der Zweck dieses Fachartikels ist es...
Änderung in der Geschäftsleitung der MBV AG
Per 1. Juli 2024 ergänzt Lea Bachmann als Chief Client Officer die Geschäftsleitung der MBV und übernimmt die Verantwortung für den weiteren strategischen Ausbau der Kundenbeziehungen. Roland Durner, Chief Strategy Officer, tritt aus dem Unternehmen aus. Als neues Mitglied in der Geschäftsleitung begrüssen wir herzlich Lea Bachmann.
Produktionsräume für schnelllebige Konsumgüter
Reinraum-Projektmanagement, für schnelllebige Konsumgüter im regulierten Umfeld
Die Fast Moving Consumer Goods (FMCG) Industrie umfasst Tabakprodukte, Lebensmittel, Getränke, Haushaltswaren und Körperpflegeprodukte, die schnell verkauft und konsumiert werden.
Dynamic Speed Interface
During this summer period, we thought it would be a good time to feature one of the most valuable building blocks that is configured in our cleanroom solutions via ADAPTUS: Dynamic Speed Interface (DSI).
Partikelverluste in Transportleitungen
Sterile Produkte und aseptische Prozesse erfordern eine Partikelüberwachung.
Newsletter Sommer 2024
«Lebenskünstler ist, wer seinen Sommer so erlebt, dass er ihm noch den Winter wärmt.» (Alfred Polgar)
Erleben Sie nun Neuigkeiten, Innovationen etc. im neuen Sommer-Newsletter.
Laborwassersysteme und TOC Messgerät
Seit Firmengründung vertreibt die Sagamo AG erfolgreich die TOC Messgeräte von membraPure in Reinstwasseranlagen. Neu liefern wir auch die Laborwassersysteme.
Neuer Massstab im Umgebungsmonitoring
Plair SA führt den Rapid-C+ ein, ein Echtzeit-Luftkeimpartikelsammler in Kombination mit einem Luftkeimsammler für die aseptische Produktion sowie für Reinräume
Seminar GMP-Aufbauwissen
Am Mittwoch 5. Juni 2024 fand im Hotel Schützen das Seminar GMP-Aufbauwissen statt. Die grosse Anzahl der Teilnehmer zeigte den Bedarf an diesem Thema an.
LS-pedia - die Enzyklopädie der gel(i)ebten Mikrobiologie
Ab 3. Juni 2024 bietet Labor LS seinen Kunden einen neuen Service an. Die von den Mikrobiologen des GMP-Labors entwickelte Onlinedatenbank LS-pedia wird mit Identifizierungsergebnissen verknüpft, sodass ab sofort zu jedem Identifizierungsergebnis tiefgehende Hintergrundinformationen kostenfrei abgerufen werden können.
Seminar: Kontaminationskontrollstrategie sinnvoll umsetzen
Am 30. Mai 2025 fand im Hotel Schützen das Seminar: Annex 1 - Kontaminationskontrollstrategie sinnvoll umsetzen statt.
Seminar Train the Trainer im GMP-Umfeld
Am 15. Mai 2024 fand in Rheinfelden im Hotel Schützen das Seminar Train the Trainer im GMP-Umfeld statt.
Seminar Reinraum-Basiswissen
Am 24. April fand im Hotel Schützen in Rheinfelden das Seminar "Reinraum-Basiswissen" statt.
26. Swiss Cleanroom Community Event
Bereits ist das 26. Swiss Cleanroom Community Event in Pratteln wieder Geschichte.
Wir durften uns über 54 Aussteller und 300 Besucher von 150 Firmen an diesem Frühlingsevent freuen.
Seminar Mikrobiologie im GMP-Umfeld
Am 10. April fand im Hotel Schützen in Rheinfelden das Seminar "Mikrobiologie im GMP-Umfeld" statt.
Seminar Anforderungen an pharmazeutische Gase
Am 9. April fand im Hotel Schützen in Rheinfelden das Seminar "Anforderungen an pharmazeutische Gase" statt.
Newsletter Frühling 2024
Der Frühling ist die beste Zeit des Jahres, etwas Neues zu beginnen.
Starten wir das neue Newsletter Jahr mit vielen Neuigkeiten unserer SCC-Partner.
GMP und Hygienic Design Schweissfachbetrieb nach EN 1090
Die MORATH SOLUTIONS - Lösungen aus Edelstahl bietet Ihnen GMP und Hygienic Design Schweissfachbetrieb nach EN 1090 und hat grosse Branchenerfahrung in Pharma-, Food- und Health Care
Medizintechnik: Wirtschaftlicher Validierungsansatz für umfangreiche Produktionsbereiche
Medizintechnik: Wirtschaftlicher Validierungsansatz für umfangreiche Produktionsbereiche
GMP-Monitoringsystem: Virtueller Server vs. Hardwareserver
Bei dem Betrieb eines GMP-Monitoringsystems stellt sich häufig die Frage, ob ein Hardwareserver oder ein virtueller Server die bessere Lösung ist. Wir haben beiden Varianten näher betrachtet und die Vor- und Nachteile gegenübergestellt.
Seminar: Monitoring-Systeme in reinen Räumen
Am 13. März fand im Hotel Schützen in Rheinfelden das Seminar Monitoring-Systeme in reinen Räumen statt.
Seminar Reinstwasser im GMP-Umfeld bei BWT Aqua AG
Am 12. März fand bei der Firma BWT Aqua AG in Aesch das Seminar Reinstwasser im GMP-Umfeld statt.
Seminar Anforderungen an die Quality bzw. QA-Oversight
Am 7. März fand im Hotel Schützen in Rheinfelden das Seminar Anforderungen an die Quality bzw. QA-Oversight statt.
1. März 2024 - Andy Cowan wird zum Präsidenten von Particle Measuring Systems ernannt
Andy Cowan wurde zum Präsidenten von Particle Measuring Systems (PMS) ernannt.
Seminar Reinigungsvalidierung im GMP-Umfeld
Am Donnerstag, 1. Februar 2024 fand im Hotel Eden im Park das Seminar Reinigungsvalidierung im GMP-Umfeld statt.
Seminar Der neue Annex 1
Am Mittwoch, 31. Januar 2024 fand im Hotel Eden im Park das Seminar "Der neue Annex 1" statt.
Intensivseminar für Reinraum Quereinsteiger
Am 24. und 25. Januar 2024 fand im Hotel Schützen das Intensivseminar für Reinraum Quereinsteiger statt.
Reinraum Monitoring Case Study
Für den Neubau der Apotheke des Universitätsklinikums des Saarlandes wurde im GMP-Herstellbereich sowie für den Unit-Dose-Bereich zur Überwachung der Umgebungs- und Prozessparameter ein Reinraum-Monitoringsystem benötigt. Außerdem wurde ein Temperaturmapping
Bearbeitung, mechanische Anfertigungen und Elektroerosion
Wir stellen Ihnen unsere Kompetenzen in den Bereichen mechanische Bearbeitung, Unterstützung in der Lohnfertigung sowie bei elektroerosiven Verfahren zur Verfügung.
Newsletter Winter 2023/24
Du musst genau das machen, wovon Du glaubst: das kann man nicht machen (Zitat: Eleanor Roosevelt)
Die Wichtel haben für diesen Newsletter wieder viele Neuigkeiten für Sie gesammelt.
Happy New Year
"Gib jedem neuen Jahr die Chance das Schönste Deines Lebens zu werden!" Mark Twain
Kinderaugen zum Leuchten bringen: Stiftung für Kinder in der Schweiz
25.Swiss Cleanroom Community Event: Kinderaugen zum Leuchten bringen.
Wir begrüssen Spenocon als neuen SCC-Partner
The following services can be offered: GMP Consulting, Technics, Validation, Technologies Pharma and Technologies MedTech
Wir begrüssen General Filter Italia als neuen SCC-Partner
General Filter Italia is a multinational leader in the field of filtration and indoor air quality. Over 50 years of presence on the market, the strong propensity for Research and Development and the investments in productivity carried out in recent years, have allowed us to acquire the competitive strength necessary to grow the company on international markets.
Wir begrüssen ABN Cleanroom Technology als neuen SCC-Partner
ABN Cleanroom Technology wurde im Jahr 1996 gegründet, um den wachsenden Bedarf der Pharma- und Biowissenschaftsbranche zu decken. Im Laufe der Jahre haben wir eine stolze Tradition aufgebaut, innovative Lösungen anzubieten, um die Reinraumanforderungen unserer Kunden zu erfüllen. Unsere Reise begann mit...
Seminar Computervalidierung und Datenintegrität
Am Mittwoch, 15. November 2023 fand in Rheinfelden im Hotel Schützen das Seminar Computervalidierung und Datenintegrität in Rheinfelden statt.
Seminar Audits und Inspektionen erfolgreich bestehen
Am Dienstag,, 14. November 2023 fand in Rheinfelden im Hotel Schützen das Seminar Audits und Inspektionen erfolgreich bestehen in Rheinfelden statt.
Perfekte Dosierung dank unseres VisoTec Sortiments
Wir von der Aseptconn AG freuen uns Ihnen mitteilen zu können, dass wir die Produkte von ViscoTec in unser Sortiment aufgenommen haben und künftig vertreten werden.
Seminar Anforderungen an die Sterilisation
Am 9. November fand im Hotel Schützen in Rheinfelden das Seminar Anforderungen an die Sterilisation statt.
Reinraum ISO Klasse 7 zum Verkauf
Die Firma Sentec AG hatte bis vor kurzem den nachfolgenden Reinraum ISO Klasse 7 in Betrieb. aufgrund von Produktionsänderungen wird dieser nicht mehr benötigt.
25. Swiss Cleanroom Community Event
Bereits ist das 25. Swiss Cleanroom Community Event (Jubiläumsevent) in Pratteln wieder Geschichte.
Wir durften uns über 51 Aussteller und knapp 300 Besucher von 150 Firmen an diesem speziellen Jubiläumsevent freuen.
Intensivseminar für Reinraum-Quereinsteiger
Am 30. und 31. Oktober fand im Hotel Schützen in Rheinfelden das Intensivseminar für Reinraum-Quereinsteiger statt.
Seminar Monitoring in reinem Räumen
Am Donnerstag, 26. Oktober 2023 fand in Luzern bei der Firma Bioexam das Seminar "Monitoring in reinem Räumen" statt.
Seminar GMP-Basiswissen
Am Mittwoch, 25. Oktober 2023 fand in Rheinfelden im Hotel Schützen das Seminar GMP-Basiswissen Seminar in Rheinfelden statt.
Reinraum Display - Alles im Blick, alles unter Kontrolle
Ein Grafikdisplay bietet im Reinraum hohe Flexibilität für Planer und Nutzer. Der Betreiber hat stets die volle Kontrolle und kann bei Bedarf umgehend reagieren.
Analyse von pharmazeutischen Gasen
Druckluft und andere sterile und nicht-sterile pharmazeutische Gase unterliegen hohen Anforderungen an die Reinheit, da jegliche Verunreinigungen in Hinblick auf die Arzneimittelsicherheit mit hohen Risiken verbunden sind.
Qualifizierung von Standardgeräten
Qualifizierung ist in der GMP-regulierten Industrie beständig ein Thema, denn die Aufgaben sind vielfältig, das „Wie“ nicht eineindeutig reguliert und der Weg zum Ziel in nahezu beliebig viele Einzelschritte aufteilbar. Dies alles macht die Qualifizierung für viele Unternehmen zu einer Aufgabe, die zeit-, kosten- und personalintensiv ist.
Newsletter Herbst 2023
«Der Frühling ist zwar schön; doch wenn der Herbst nicht wär’, wär’ zwar das Auge satt, der Magen aber leer.» (Friedrich von Logau)
Wir sind nun dafür besorgt, dass Sie mit unserem Herbstnewsletter mit den vielen Neuigkeiten satt werden.
Validierungen im GMP- und Reinraum-Bereich
Am Donnerstag, 19. Oktober 2023 fand in Rheinfelden im Hotel Schützen das Seminar Validierungen im GMP- und Reinraum-Bereich statt..
Seminar Reinraumbau, Technik, Betrieb und Unterhalt
Am Mittwoch, 18. Oktober 2023 fand in Rheinfelden im Hotel Schützen das Seminar Reinraumbau, Technik, Betrieb und Unterhalt statt..
Seminar Anforderungen an die Dampfsterilisation
Am Dienstag, 17. Oktober 2023 fand in Rheinfelden im Hotel Schützen das Seminar Anforderungen an die Dampfsterilisation statt.
Seminar Anforderungen an Single use Systeme
Am Dienstag,, 05. September 2023 fand in Rheinfelden im Hotel Schützen das Seminar Anforderungen an Single use Systeme statt.
Seminar Persönliche Schutzausrüstung (PSA) in reinen Bereichen
Am Donnerstag den 31. Augsust 2023 fand in den Räumlichkeiten der Firma Skan AG in Allschwil das Seminar "Persönliche Schutzausrüstung (PSA) in reinen Bereichen" statt.
Seminar Sicherer Umgang mit Zytostatika
Am Dienstag den 29. Augsust 2023 fand in den Räumlichkeiten der Firma Skan AG in Allschwil das Seminar "Sicherer Umgang mit Zytostatika" statt.
Seminar GMP-Aufbauwissen
Am Mittwoch,, 23. August 2023 fand in Rheinfelden im Hotel Schützen das Seminar GMP-Aufbauwissen statt.
Reinraum Monitoring Case Study
Monitoringsystem für den Neubau einer zentralen Sterilherstellung
Für die zentrale Sterilherstellung der Firma Medipolis Produktion GmbH im Pharmapark Jena wurde ein Reinraum Monitoringsystem zur Überwachung und Dokumentation des TOX und NON-TOX Herstellungsbereiches benötigt. Mit der Zentralisierung der Produktion an einem Standort in Jena wurde die Herstellfläche deutlich vergrößert und die Arbeitsabläufe optimiert. Deutschlandweit arbeiten bei Medipolis mittlerweile über 500 Mitarbeitende und an zwei festen Standorten.
Monitoring-Software: Ereignis-Filter - mehr als nur ein Audit-Trail
In einem Monitoringsystems werden im Laufe der Zeit sehr viele Ereignisse generiert und im Audit-Trail gespeichert. Wenn der Anwender nun ein spezielles Ereignis sucht, sind detaillierte Filtereinstellungen notwendig, um möglichst schnell und effizient die gewünschten Informationen zu finden.
Bei einer guten GMP Reinraum Monitoring-Software sind die Funktionen Audit-Trail und Alarm-Log integraler Bestandteil des Softwarepakets. Zum Teil sind diese auch miteinander kombiniert.
Willkommen als neuer SCC-Partner: PPT - Pharma Process Technology
PPT – Pharma Process Technology – Pharma & Compliance Experten für die Schweiz
Warum ein Dummy für Filtergehäuse verwenden?
Warum ein Dummy für Filtergehäuse verwenden?
Sparen Sie Zeit und Reinigungsmittel, wenn Sie Ihre Filterreinigung, indem Sie einen Dummy verwenden, der speziell für Ihr Filtergehäuse angefertigt wurde.
Willkommen als neuer SCC-Partner: Computare AG
Unser Hauptanliegen ist es, Ihnen den bestmöglichen Service zu bieten. Wir arbeiten eng mit unseren Kunden zusammen, um individuelle Lösungen zu designen, die perfekt auf die zu überwachenden Elemente abgestimmt sind.
Willkommen als neuer SCC-Partner: EFAFLEX Swiss GmbH
Individuelle Lösungen für individuelle Anforderungen
Im Schnelllauftorsektor steht EFAFLEX für Geschwindigkeit und Sicherheit
Beratherm feiert 60-jähriges Firmenjubiläum
Wir von der Beratherm AG in Pratteln sind seit 60 Jahren der Spezialist für chemisch-technische Oberflächenbehandlung.
Willkommen als neuer SCC-Partner: TQM Technical Quality Management GmbH
Die TQM GmbH, mit Sitz in Bütschwil SG, ist ein erfahrenes Unternehmen im Bereich Reinraummesstechnik, Sterillufttechnik und Anlagenbau.
Single-Sourcing-Strategie für Referenzkalibrierung in GxP-regulierten Branchen
Was ist bei der Implementierung einer Single-Sourcing-Strategie für Referenzkalibrierungen in GxP-regulierten Bereichen zu beachten?
Willkommen als neuer SCC-Partner: DELTA 2000
Always looking for Quality is the premise for a successful differentiation of products, but also it becomes a fundamental principle, because Quality COMPANIES attract Quality PEOPLE
Das Swiss Cleanroom Concept Team wünscht: ä schönä 1. Ougschtä
"Trittst im Morgenrot daher .... "
Newsletter Sommer 2023
"Es ist nicht wichtig, was Du betrachtest, sondern was Du siehst." (Henry David Thoreau)
Betrachten oder Sehen Sie sich den neuen Sommer-Newsletter gemütlich an.Spannende Neuigkeiten, Rückblicke und einen besondern Ausblick erwartet Sie.
Sie vernehmen nun im Sommer-Newsletter das Neuste vom Neusten von unseren SCC-Partnern und von uns.
Viel Spass beim Lesen
Die 5 Steps zum Reinraum-Reiniger
In der pharmazeutischen Industrie wird oft die Reinraum-Reinigung outgesourct. Der Grund ist wie immer das liebe Geld. Leider ist sich dabei der Auftraggeber nicht immer bewusst, welche wichtige Arbeit er dabei vergibt. Da die Reinraum-Reinigung wenn falsch oder nicht professionell ausgeführt wird, die Qualität der Produkte welche im Reinraum gefertigt werden negativ beeinflussen kann.
Der Schaden...
Wie soll die Durchgängikeit in einem KMU stufenweise erhöht werden
2020 wurde Pharmatronic für den Ersatz einer bestehenden EAM-Software (EAM: Entreprise Asset Managment) mit folgenden kritischen Anforderungen (nicht erschöpfend) beauftragt:
Durchdachte Bodenwahl schont Ressourcen und Budgets
Nachhaltigkeit und der sorgfältige Umgang mit Ressourcen werden in der produzierenden In-dustrie immer wichtiger. Dies hat nicht nur Einfluss auf die Fertigungsprozesse an sich, son-dern wirkt sich auch auf die Gestaltung von Reinräumen und GMP-Bereichen aus. Bei der Auswahl von Bodenbelägen sind in eine ganzheitliche Betrachtung verschiedene Faktoren einzubeziehen: die Eigenschaften der Produkte, ihre Nutzung bzw. die Performance im Bau-teil Reinraum sowie die ökologischen Auswirkungen auf das Gesamtbauwerk.
AM Instruments solutions to new Annex 1 challenges
AM Instruments is focused on contamination control in cleanroom environments.
Seminar Teamleiter im Reinraum
Am Donnerstag,, 22. Juni 2023 fand in Rheinfelden im Hotel Schützen das Seminar Teamleiter im Reinraum statt.
24. Swiss Cleanroom Community Event
Liebe Aussteller, liebe Besucher
Schwups und schon ist das 24. Swiss Cleanroom Community Event wieder Geschichte. 52 Aussteller und über 230 Besucher traten in rege Gespräche über Neuigkeiten, Innovationen, Partnerschaften.
Reinraum Intensivseminar
Am 06. Und 07 Juni 2023 fand in Rheinfelden, im Hotel Schützen, das 2-tägige Reinraum Intensivseminar statt. Frank Zimmermann, Geschäftsführer von der Firma Swiss Cleanroom Concept GmbH, durfte 18 Teilnehmer(innen) begrüssen.
Produktneuheit: Sailer Hygienic Design Magnet jetzt auch für die Reinräume der Branchen Optik, Halbleiter und Mikroelektronik verfügbar
In der Pharma- und Lebensmittelbranche hat sich der Sailer Hygienic Design Magnet als innovative Montage-Lösung für Reinräume bereits durchgesetzt und erleichtert bei unzähligen Anwendern die Wandbefestigungen jeder Art von Einrichtungsgegenständen enorm. Es muss nicht mehr gebohrt werden.
Temperaturüberwachung von Kühl-/Gefriergeräten
Der Schutz von temperatursensiblen Produkten und Waren in Kühlschränken/Gefrierschänken ist enorm wichtig, um den Reinraumbetreiber vor finanziellen Schäden zu bewahren.
Particle Measuring Systems erhält EcoVadis-Silbermedaille für Fortschritte im Bereich Nachhaltigkeit
Particle Measuring Systems erhält EcoVadis-Silbermedaille für Fortschritte im Bereich Nachhaltigkeit
Seminar: Der neue Annex 1
Am Dienstag, 02. Mai 2023 fand in Rheinfelden im Hotel Schützen das Seminar "Der neue Annex 1" statt.
Seminar Reinraum-Qualifizierung und Monitoring nach ISO 14644
Am Donnerstag, 27. April 2023 fand in Wattwil in dem Seminarraum der Firma Particle Measuring Systems AG das Seminar Reinraum-Qualifizierung und Monitoring nach ISO 14644 statt.
Seminar Anforderungen an die Reinraumlufttechnik
Am Mittwoch, 26. April 2023 fand in Unterägeri, im Seminarraum der Firma Camfil AG, das Seminar Anforderungen an die Reinraumlufttechnik statt.
Seminar Reinraum Basiswissen
Am Donnerstag, 20. April 2023 fand in Rheinfelden im Hotel Schützen das Seminar Reinraum Basiswissen statt.
Seminar Train the Trainer im GMP-Umfeld
Am Mittwoch, 19. April 2023 fand in Rheinfelden im Hotel Schützen das Seminar Trainer im GMP-Umfeld statt.
Seminar Mikrobiologie im GMP-Umfeld
Am Mittwoch,, 12. April 2023 fand in Rheinfelden im Hotel Schützen das Seminar Mikrobiologie im GMP-Umfeld statt.
Seminar Anforderungen an pharmazeutische Gase
Am Dienstag, 11. April 2023 fand in Rheinfelden im Hotel Schützen das Seminar Anforderungen an pharmazeutische Gase statt.
Newsletter Frühling 2023
Im Frühling erwacht die Natur rund um uns herum wieder zu neuem Leben. Auch die neuen Düfte von frischem Gras und warmer Luft steigen uns in die Nase. Frühling, ja du bist es! Dich habe ich vernommen! Sagte auch einst Eduard Mörike.
Sie vernehmen nun im Frühlingsnewsletter das Neuste vom Neusten von unseren SCC-Partnern und von uns.
Viel Spass beim Lesen
Wir wünschen unseren SCC-Partner ein frohes Osterfest
Endlich ist es soweit ...
Führungswechsel bei Testo Industrial Services AG
Testo Industrial Services AG bei Egg nähe Zürich freut sich Ihnen den neuen Geschäftsführer vorzustellen zu können!
Turnkey Fill/Finish-Lösung für Vials mit integrierter Barrierelösung
Flexicon Liquid Filling, Experte für Fill/Finish-Lösungen sowie Teil von Watson-Marlow Fluid Technology Solutions (WMFTS) und die Franz Ziel GmbH, Spezialist für Barrieretechnologie, präsentieren Cellefill™ – ein Turnkey-System zum Befüllen und Verschliessen von Vials mit integrierter Barrierelösung.
Integrierte Lösung zur schnellen Markteinführung von Zell-, Gen- und biologischen Therapien
Flexicon Liquid Filling, Experte für Fill/Finish-Lösungen sowie Teil von Watson-Marlow Fluid Technology Solutions (WMFTS) und die Franz Ziel GmbH, Spezialist für Barrieretechnologie, präsentieren Cellefill™ – ein Turnkey-System zum Befüllen und Verschliessen von Vials mit integrierter Barrierelösung.
Seminar Herstellung von hochaktiven sterilen Substanzen
Am Donnerstag, 30. März 2023 fand in Allschwil am Hauptsitz der Firma Skan AG das Seminar Herstellung von hochaktiven sterilen Substanzen statt.
Seminar Datenintegrität im Fokus der Behörden
Am Mittwoch, 29. März 2023 fand in Rheinfelden im Hotel Schützen das Seminar Datenintegrität im Fokus der Behörden statt.
Seminar Wasser im Spitalbereich am 28. März 2023
Am Dienstag, 28. März 2023 fand bei der BWT AQUA AG in Aesch das Seminar Wasser im Spitalbereich statt.
SKAN Service Update 2023
Möchten Sie wissen, wie unsere Dienstleitungen Ihre Arbeitssicherheit im Labor, Reinraum und in der Produktion erhöhen?
Die Vorzüge von PFA gegenüber PTFE
Um den hohen Qualitätsstandards der Pharmaindustrie gerecht zu werden, bieten wir qualitativ hochwertige Produkte an, die strengen Konformitätstests unterzogen werden
Seminar Reinstwasser im GMP-Umfeld bei BWT Aqua AG
Am Dienstag, 14. März 2023, fand in Aesch bei der Firma BWT Auqa AG das Seminar "Reinstwasser im GMP-Umfeld" statt.
Seminar Reinraum Hygiene Praxis am 1. März 2023
Am Mittwoch, 1. März 2023 waren wir mit unserem Seminar Reinraum Hygiene Praxis, bei DELTA Zofingen AG zu Gast.
Wechsel im Verwaltungsratspräsidium der MBV AG
Hans Zingre verabschiedet sich mit der Vollendung des 70. Lebensjahres in den Ruhe-stand und ist im Januar 2023 als Verwaltungsratspräsident der MBV AG zurückgetreten. Zu seinem Nachfolger wurde einstimmig Daniel Weltin gewählt.
Seminar Reinigungsvalidierung im GMP-Umfeld am 2. Februar 2023
Das Seminar Reinigungsvalidierung im GMP-Umfeld fand am Donnerstag, den 2. Februar 2023 im Hotel Schützen in Rheinfelden statt. Den Seminarteilnehmern wurde das Thema von unseren Experten Dr. Sabine Paris, Senior GMP Expert vom GMP-Verlag Peither AG; Jörg Koppenhöfer, Senior Consultant bei gempex GmbH und Frank Zimmermann, Geschäftsführer Swiss Cleanroom Concept GmbH präsentiert.
Reinraum: Absenkbetrieb als Baustein einer Nachhaltigkeitsstrategie
Durch Reduzierung der Luftwechselraten oder geänderte Grenzbereiche einer Lufttemperatur-/Luftfeuchteregelung können die Betriebskosten eines Reinraumes deutlich gesenkt werden.
Wir machen die Flächendesinfektion grün
Sie möchten Nachhaltigkeit ohne Mehrkosten? Jetzt mit schülke.
Der Wasserstoffperoxid-Rechner für Biodekontaminationsprozesse
Mit diesem Rechner für verdampftes Wasserstoffperoxid können Sie Biodekontaminationsprozesse in geschlossenen und offenen Systemen oder unter freien Verdampfungsbedingungen simulieren. Wählen Sie einfach das Verfahren und Eingabeparameter wie Phasendauer, Temperatur, Injektionsraten, H2O2-Flüssigkeitskonzentration und...
Sie wollen Ihre Prozesse, Mitarbeiter und Standorte schützen?
Testen Sie unser kontinuierliches Monitoring System.
Mit unserem neuen Monitoring System für die biopharmazeutische Industrie halten Sie die geltenden Regularien ein und haben die Möglichkeit, Ihre Anlagen zu optimieren.
Intensivseminar für Reinraum-Quereinsteiger 25./26.Januar 2023
Am 25./26.Januar 2023 durften wir 13 Teilnehmer am Intensivseminar für Reinraum-Quereinsteiger in Rheinfelden schulen.
Newsletter Winter 2022/23
Ein neues Geschäftsjahr ist wie das Meer, manchmal ist es still und ruhig, manchmal laut und wild.
Aber am Ende ist es immer wundervoll, wenn man seine Ziele erreicht hat.
In diesem Newsletter erfahren Sie, was unsere SCC-Partner zu berichten haben und wie vielfältig wir unterwegs sind.
Wir wünschen Ihnen einen guten Rutsch ins neue Jahr
Swiss Cleanroom Concept lässt es knallen. Im Jahr 2023 bekommen Sie noch mehr Wissen von uns.
Wir haben 10 neue Seminare für Sie auf dem Programm. Insgesamt dürfen Sie...
MiniCapt®Pro: Ferngesteuerter mikrobiellen Luftprobennehmer
Particle Measuring Systems veröffentlicht vollständig konformen, ferngesteuerten mikrobiellen Luftprobennehmer mit flexibler Installation und einfacher Integration von Umgebungsüberwachungssystemen
Frohe Weihnachten
Wir sagen von Herzen DANKE und wünschen frohe Weihnachten
Sterile Tücher für den Reinraum
Sterile Tücher für den Reinraum, auch sterile Reinraumtücher genannt, gibt es vorgetränkt oder ungetränkt sowie aus verschiedenen Stoffarten und Materialien. Wie die Sterilisation funktioniert, welche Arten steriler Tücher es gibt und wo diese eingesetzt werden, erfahren Sie in diesem Beitrag.
Elektrische Membranpumpen
Die Pharma-Branche ist strikt und sehr reglementiert.
23. Swiss Cleanroom Community Event
Liebe Aussteller, liebe Besucher
Schwups und schon ist das 23. Swiss Cleanroom Community Event wieder Geschichte. 46 Aussteller und über 230 Besucher traten in rege Gespräche über Neuigkeiten, Innovationen, Partnerschaften.
Die neuen Volumenstromregler CELERIS und TRACCEL
Die weltweit erfolgreichsten, schnellsten und genauesten Laborlüftungssysteme von Phoenix Controls für die grössten und neuesten Laborgebäude der Schweiz.
FDA-konformer Wägetisch komplett aus Edelstahl
Präzises Arbeiten steht in der Pharma-Produktion an erster Stelle – dazu gehört auch das hoch genaue Abwiegen kleinster Produkt- oder Wirkstoffmengen.
vH2O2- Dampfkonzentration und Kondensationspunkt
Dieser Blog ist der vierte in einer Reihe mit vier Beiträgen, in der wir beschreiben, wie Prozessparameter die Anwendungen zur Biodekontamination mit verdampftem Wasserstoffperoxid beeinflussen.
Newsletter Herbst 2022
Lebe die Jahreszeiten, wie sie kommen. Atme ihre Luft, trinke ihre Getränke, schmecke ihre Früchte und überlasse dich ihren Einflüssen (Henry David Thoreau). Herbstzeit, ist durchaus keine Ruhezeit. Plannungen fürs nächste Jahr sind schon überall voll im Gange. Wir haben aber noch ein Highlight in diesem Jahr:
SLPM Zertifizierung für das MAS-100 Regulus Digitalanemometer
Für die aktive mikrobielle Luftüberwachung ist es am besten, standardisierte Luftströme zu verwenden, unab-hängig von Temperatur und Druck.
Novatek International heissen wir als neuer SCC-Partner herzlich willkommen
Novatek International bietet eine neue Art von allumfassenden, prozessgesteuerten LIMS- und anderen Softwarelösungen, die auf die pharmazeutische, biotechnologische und andere Gesundheitsbranche abzielen
Rosin Entreprise heissen wir als neuer SCC-Partner herzlich willkommen
Der Partner für Ihre Projekte: Reinräume - Labore - Kühlräume
Vergleich: Messverfahren für die Differenzdruckmessung im Reinraum
Messung von Raum zu Raum vs. Messung gegen einen Referenzpunkt - Virtuellen Sensoren in der Monitoring-Software kombinieren die Vorteile beider Verfahren
Druckluftqualität - warum der Taupunkt bzw. Drucktaupunkt so wichtig ist
Im Reinraum befinden sich meistens spezielle Mediensäulen mit endständigen Filtern für Prozessluft und Stickgasen wie Stickstoff als Zapfstellen, welche bei kritischen Anwendungen den Anforderungen an Qualität gemäss ISO 8573-1:2010 entsprechend der Klassen [2:2:1] oder [2:1:1] oder [1:1:0] liegen sollte. Diese Anforderungen variieren jedoch nach Anwendungen (VDMA 15390:2018) nicht verbindlich vorgeschrieben und nach Umgebungstemperaturen je nach Zonen und Gas.
Produktionseffizienz im Reinraum sicherstellen
In immer mehr Industriezweigen wird in Reinräumen produziert – nicht nur in der Pharma- und Kosmetikbranche, sondern auch im Elektronikbereich oder in der Automobilindustrie. Denn durch die Entfernung von schädigenden Partikeln und Mikroorganismen aus der Luft wird eine deutlich höhere Qualität und Sicherheit für Produkte und Prozesse erreicht.
Reinraum Monitoring: Prozesse optimieren und automatisieren mit Schnittstellen
Mit Schnittstellen (Modbus, Profinet, ...) lassen sich Prozesse bei der Produktion im Reinraum optimieren, vereinfachen und automatisieren.
icotek (swiss) AG heissen wir als neuer SCC-Partner herzlich willkommen
Kabeldurchführung & Kabelmanagement für die Reinraumtechnik
Particle Measuring Systems feiert 50 Jahre
23. February 2022, Boulder, CO – Particle Measuring Systems (PMS) gibt den 50. Jahrestag seiner Gründung bekannt. PMS wurde 1972 als Cloud-Mikrophysik-Unternehmen gegründet und hat sich zu einem führenden Anbieter von Lösungen und Vordenkern für die Überwachung und Kontrolle von Kontaminationen in sauberen Produktionsanlagen in Einrichtungen auf der ganzen Welt entwickelt.
Antimikrobielle Oberflächen
Zum Schutz vor Viren und Bakterien sind seit einiger Zeit verschiedene Beschichtungsmittel für Oberflächen sowie anti-mikrobielle Oberflächen resp. Folien auf dem Markt erhältlich.
Temperatur, Kondensationspunkt und maximal erreichbare vH2O2-ppm bei der Biodekontamination
Dieser Blog ist der dritte in einer Reihe mit vier Beiträgen, in der wir beschreiben, wie Prozess-parameter die Anwendungen zur Biode-kontamination mit verdampftem Wasserstoff-peroxid beeinflussen.
ESD Einmalhandschuhe
Unter ESD versteht man die die elektrostatische Entladung, welche man beispielsweise beim Berühren von Gegenständen spürt.
Testo Industrial Services feiert 15 Jahre Firmenjubiläum
Besser hätte man ein Jubiläum nicht begehen können!
Haben Sie Probleme mit Lecks?
Haben Sie Probleme mit Lecks und/oder Verunreinigungen in Ihren Produktionsanlagen?
Unter Druck noch besser
Die MBV AG bringt den neuen Druckgas-Keimsammler MAS-100 Atmos® auf den Markt.
bardusch AG errichtet neues Kompetenzzentrum für Reinraumtextilien
bardusch AG, führender Wäschereidienstleister für die Industrie und das Gesundheitswesen in der Schweiz, eröffnet im Herbst eine Hightech-Reinraumwäscherei in Selzach (SO).
Reinraum Monitoring: Reports für einzelne Chargen
Chargen-Reporting eröffnet eine Vielzahl an neuen Möglichkeiten. Reports für einzelne Chargen lassen sich so komfortabel erstellen und automatisieren.
Newsletter Sommer 2022
Lebe das Leben, wie einen Spaziergang am Meer; leicht, glücklich und mit dem Blick nach vorn. Geniessen Sie die Sommerzeit, auch mit Lesen dieses vielfältigen und spannenden Sommer-Newsletter.
Es sind zum Glück nicht 36 Grad, sondern spannende 27 Seiten, welche heisse und spannende Themen für Sie bergen.
MPL-Mikrobiologisches Prüflabor GmbH, heissen wir herzlich als neuer SCC-Partner willkommen.
Grias-enk, hoast auf tirolerisch: Ich grüsse euch.
Schluss mit Material-Chaos beim Umgebungsmonitoring
Schluss mit Material-Chaos beim Umgebungsmonitoring - die MPL Monitoring Box sorgt für Entlastung
22. Swiss Cleanroom Community Event
Liebe Aussteller, liebe Besucher
Schwups und schon ist das 22. Swiss Cleanroom Community Event wieder Geschichte. 45 Aussteller und 200 Besucher trotzten den warmen Temperaturen und traten in rege Gespräche über Neuigkeiten, Innovationen, Partnerschaften und natürlich das Wetter.
Fittinge und Tri-Clamp Verbindungen
Fittinge und Tri-Clamp Verbindungen werden vor allem im Arbeitsbereich eingesetzt, wo ein hohes Mass an Hygieneanforderungen erforderlich ist.
ITT Membran-Ventile
Die Pharma-Branche ist sehr stark reguliert und viele Gesetzen unterworfen. Daher ist es wichtig, dass alle verwendeten Materialien von höchster Qualität aufweisen. Aus diesem Grund empfehlen wir Ihnen nur Membran-Ventile von höchster Qualität zu verwenden.
Schweissnähte aus Kunststoff
PVDF wird in der Pharmaindustrie immer häufiger verwendet. aufgrund seiner vielen Vorteile bieten wir Ihnen deshalb unseren Service für Kunststoffschweissarbeiten an.
Vermeiden Sie Montagefehler durch eindeutige Identifizierung jeder Komponente
Stellen sie Jederzeit sicher, zu welcher Produktionslinie jdes Teil gehört, indem Sie vorher die Identifikationsnummer mit einem Laser eingravieren.
gempex - THE GMP-EXPERT hat 20-jähriges Firmenjubiläum
Die gempex GmbH ist ein unabhängiges, international ausgerichtetes Dienstleistungsunternehmen, das sich auf Beratung und Umsetzung von GMP-Anforderungen in der Life Sciences Industrie spezialisiert hat. Hauptsitz der gempex ist Mannheim, weitere Standorte sind Sisseln, Schweiz, und Guangzhou, China. 2002 mit einem Team von 15 Experten gegründet, unterstützen heute mehr als 80 Mitarbeiter weltweit bei der Einführung, Optimierung und Aufrechterhaltung von Qualitätssicherungssystemen.
Schläuche und Schlauchverbindungen im Bereich steriler Flüssigkeitstransfertechnik
Die Pharma-Branche ist sehr stark reguliert und viele Gesetzen unterworfen. Daher ist es wichtig, dass alle verwendeten Materialien von höchster Qualität sind. Deshalb haben wir flexible Schläuche und Verbindungen entwickelt, die Ihren Anforderungen entsprechen.
Sonderanfertigungen bei steriler Flüssigkeitstransfertechnik
Unsere Engineering-Abteilung erfüllt alle Ihre Anforderungen für Ihre massgeschneiderten Produkte.
Massgeschneiderte Produkte
Aseptconn, ein führender Anbieter von Komponenten und Produkten im Bereich sterilerFlüssigkeitstransfertechnik, stellt Ihnen seinelangjährige Erfahrung im Pharmabereich zurVerfügung.
Reinraum Monitoring: Reports für einzelne Chargen
Chargen-Reporting eröffnet eine Vielzahl an neuen Möglichkeiten.
Reports für einzelne Chargen lassen sich so komfortabel erstellen und automatisieren
Watson-Marlow AG, willkommen als neuer SCC-Partner
Die Watson-Marlow AG in Zollikon (ZH) ist die Vertriebsniederlassung der Watson-Marlow Fluid Technology Solutions (WMFTS) in der Schweiz. WMFTS mit Hauptsitz in Falmouth (Grossbritannien) ist der Ansprechpartner für den gesamten Fluid-Path.
Connectors Verbindungstechnik AG - Willkommen als neuer SCC-Partner
Als innovative Mitdenker, Planer und Partner ...
Wechsel in der Geschäftsführung der Beratherm AG
Sehr geehrte Kunden
Herr Dr. Marco Pickel hat sich entschieden die Beratherm AG auf Ende Juni 2022 zu verlassen.
Ab Mitte Mai 2022 wird Herr Urs Haller die Geschäftsführung der Beratherm AG übernehmen. Herr Haller ist Diplomierter Chemiker HTL der Ingenieurschule beider Basel. Er startete seine berufliche Laufbahn als Design und Product Engineer bei einem grossen Schweizer Anlagebauer und war später im Internationalen Verkauf eines bekannten Schweizer Chemieproduzenten tätig. Bis vor kurzem arbeitete Urs Haller als Geschäftsführer bei einem mittelgrossen Pharmalieferanten.
Warum ein Dummy für Filtergehäuse verwenden?
Sparen Sie Zeit und Reinigungsmittel, wenn Sie Ihre Filter reinigen, indem Sie einen Dummy verwenden, der speziell für Ihr Filtergehäuse angefertigt wurde.
SKAN wird offizieller Distributor für PSA von DuPont Tyvek® in der Schweiz
Individuelle Bekleidungskonzepte für Reinraum und Produktion
Technische Installation einfach gemacht
Wussten Sie, dass es ein Tool gibt, mit dem Sie ganz einfach den passenden Standard für Ihre Verbindung finden können?!
Abluft mit Wärmerückgewinnung und deren Auswirkung im Reinraumdesign bei Doppelcontainment
Die Abluft beinhaltet eine beachtliche Wärmemenge ...
Verhältnis der H2O2-Lösungskonzentration, Kondensationspunkt und max. erreichbares vH2O2
Dieser Blog ist der zweite in einer Reihe mit vier Beiträgen, in der wir beschreiben, wie sich Prozessparameter auf Kondensation und die maximal erreichbare Konzentration von Wasserstoffperoxiddampf-ppm bei Biodekontaminationsanwendungen aus-wirken.
Seminartag GMP und Monitoring bei der Kosmetikherstellung
Heute ist Seminartag beim Gastgeber Bioexam in Luzern.
Newsletter Frühling 2022
Mit uns behalten Sie den Überblick. Heben Sie einfach mal einen Moment ab. Kreisen Sie über unseren Frühjahrsnewsletter und landen da, wo Sie die beste Beute finden. Dies in Form von Neuigkeiten, Seminarausschreibungen … Eventeinladung.
Pilatus Flugzeugwerke - wussten Sie schon?
Was fliegen und Reinraum gemeinsam haben?
Novapura AG, willkommen als neuer SCC-Partner
Die NOVAPURA AG (www.novapura.com) mit Sitz im zugerischen Rotkreuz, ist eines der führenden Unternehmen, das Lösungen im Bereich der Bio-Dekontamination, Desinfektion und Hygiene anbietet. Das Produkte-Portfolio besteht zum grossen Teil aus Eigenentwicklungen. Seit der Gründung im Jahr 2006 hat Novapura umfassendes Know-how in der Formulierung und Herstellung von Desinfektionslösungen erworben. Gemeinsam mit unseren Partnern haben wir Desinfektionsmittel für Vernebelungsanwendungen, antimikrobielle Beschichtungen und antimikrobielle Additive entwickelt.
Zu Besuch bei Eurofins BioPharma Product Testing Switzerland AG in Schönenwerd und willkommen als neuer SCC-Partner
Gestern war Swiss Cleanroom Concept GmbH auf Besuch bei Eurofins BioPharma Product Testing Switzerland AG in Schönenwerd.
Seminartag "Reinraum Qualifizierung und Monitoring"
Der heutige Seminartag "Reinraum Qualifizierung und Monitoring"
Feuchte, Kondensationspunkt und maximal erreichbares vH2O2
Dieser Blog ist der erste in einer Reihe mit vier Beiträgen, in der wir beschreiben, wie sich Prozessparameter auf Kondensation und die maximal erreichbare Konzentration von Wasserstoffperoxiddampf bei vH2O2-Biodekontaminationsanwendungen auswirken.
Clean up day 2021 - bardusch Kader macht mit
Am 17. und 18. September 2021 haben sich zum neunten Mal Tausende von Helferinnen und Helfern versammelt, um die Schweiz von Littering zu befreien.
Wofür sind Ersatzteil Kits gedacht?
Möchten Sie bei der Bestellung von Ersatzteilen für Ihre Skid- und Produktionsanlagen Zeit sparen?
Wir haben die Lösung!
UV-C-Entkeimung und UV-C-Desinfektion
Die Firma PMI Labortechnik GmbH in Wettingen ist ein Laborausrüster, spezialisiert auf die UV-C Entkeimung. Sie hat das grösste Sortiment für die UV-C Entkeimung in Europa.
Qualität, Compliance und Datenintegrität sicherzustellen
LSNE (ein PCI Pharma Services-Unternehmen) nutzt Digitalisierung, um Qualität, Compliance und Datenintegrität sicherzustellen.
Particle Measuring Systems feiert 50 Jahre
Anlässlich des 50-jährigen Jubiläums von Particle Measuring Systems blicken wir auf ein halbes Jahrhundert voller Innovationen und Wachstum zurück.
Der erste echte CMR- und Zytostatika-Isolator
skanfog® pure ist der erste Isolator, der nach DIN 12980 zertifiziert ist.
Reinraum Inhouse Schulung bei SteriMedTec AG und Bürki AG
Reinraum Inhouse Schulung bei SteriMedTec AG und Bürki AG
Die neue Geschäftsstelle der Pfennig Reinigungstechnik AG hat ihre Pforten geöffnet
Im Sommer diesen Jahres war die Entscheidung gefallen: Unsere Schweizer Kollegen stellen die Weichen für neues Wachstum und vergrößern sich.
Newsletter Winter 2022
Erneut ist ein Jahr voller Ereignisse zu Ende gegangen. Hindernisse und Schwierigkeiten sind Stufen, auf denen wir in die Höhe steigen, sagte einst Friedrich Nietzsche. Kein Hindernis ist uns zu gross, um es nicht flexibel und schnell bewältigen zu können. Manchmal braucht es einen Schockmoment um etwas Neues und Besseres zu finden.
2-Tages Intensivseminar für Reinraum-Quereinsteiger
Was ist ein Reinraum? Warum braucht es einen Reinraum?
Wachstum im Betrieb - Enge in den Umkleiden? Pharmatronic hilft eine Lösung zu finden.
Wächst ein Pharmabetrieb, wird meist die Produktionskapazität vergrößert und gleichzeitig der Materialfluss optimiert. So weit so gut. Das Mehr an Maschinen und bewegtem Material bedingt meist, dass es mehr Mitarbeitende braucht.
Swiss Cleanroom Concept wünscht ...
Wieder geht ein spezielles Jahr zu Ende.
Boxenhandschuhe sind nicht für den Reinraum geeignet
Latex- oder Nitrilhandschuhe aus der Spenderbox sind nicht für den Reinraum geeignet, da schon allein durch die Karton-Verpackung zu viele Partikel abgegeben werden. Die bessere Lösung für den Reinraum sind Nitrilhandschuhe oder Handschuhe aus einem anderen Material wie etwa Latex, die von Hause aus doppelt in sogenannten PE-Schutzbeuteln verpackt sind, also durch Polyethylen-Folie vor Kontaminationen geschützt sind.
Particle Measuring Systems erweitert Produktlinie von Single Use-Produkten für die mikrobielle Probenahme auf 100 LPM-Anwendungen
Particle Measuring Systems erweitert Produktlinie von Single Use-Produkten für die mikrobielle Probenahme auf 100 LPM-Anwendungen. BioCapt® Single-Use Luftkeim-Impaktoren ab jetzt für neue Anwendungen, einschließlich Fehlersuche bei Kontaminationen
Reparatur und Renovierung von Tanks
Vermeiden Sie lange Stillstandzeiten Ihrer Produktionsanlagen durch regelmässige Wartung.
Chemische Verträglichkeitstabelle für Dichtungen
Finfen Sie die chemisch am Besten verträgliche Dichtungen für Ihre Anlagen.
Herzlich willkommen Condair AG als neuen SCC-Partner
In der Schweiz ist die Condair AG das Pionier-Unternehmen mit über 70 Jahren Erfahrung. Mit drei regionalen Verkaufs- und Servicestandorte in Pfäffikon/SZ, Bulle/FR und Basel decken wir den Schweizer Markt optimal ab.
Heute wieder Seminartag: Mikrobiologie im GMP Umfeld
Bei mikrobiologischen Abweichungen im Monitoring in der Pharma-, der Medizintechnik und der Biotechnikproduktion
21. Swiss Cleanroom Community Event
Liebe Aussteller, liebe Besucher
44 Firmen und über 200 Besucher durften wir am 21. Swiss Cleanroom Community Event, vom 8. November, in der neuen Location, im Haus der Wirtschaft in Pratteln begrüssen.
Regen Austausch fand unter den Ausstellern und Besuchern über...
Partnerschaft zwischen abovo und pure11
Zwischen dem schweizerischen Fach-Grosshändler für Reinraumprodukte abovo und dem deutschen Reinraumprodukte-Händler pure¹¹ besteht eine enge und langjährige Partnerschaft, die auch den Kunden in der Schweiz grosse Vorteile bringt.
Colorex - Der Hightech Vinylboden für Reinräume
Colorex ist ein High-Tech-Vinylboden, besonders geeignet für die Anwendung in Reinräumen, in ESD- und Klinikbereichen sowie in der Industrie. Dieser hochdruckverpresste Bodenbelag erfüllt aufgrund seiner Materialzusammensetzung höchste Qualitätsanforderungen und garantiert lebenslange Leitfähigkeit.
Seminartag: Sicherer Umgang mit Zytostatika
Der heutige Seminartag war: "Sicher Umgang mit Zytostatika" beim Gastgeber SKAN AG in Allschwil.
Herzlich willkommen Forbo-Giubiasco SA als neuer SCC-Partner
Forbo Flooring Systems ist ein globaler Anbieter hochwertiger Bodenbeläge.
Seminar: Anforderungen an die H2O2-Begasung
Am 13. Oktober 2021 fand unser Seminar "Anforderungen an die H2O2-Begasung" statt.
2-Tages Intensivseminar für Reinraum-Quereinsteiger
Am 11. und 12. Oktober 2021 fand unser zweitägiges Intensivseminar für Reinraum--Quereinsteiger in Rheinfelden statt.
Herzlich willkommen CAD Computer GmbH&Co.KG als neuer SCC-Partner
Die CAD-Computer GmbH & Co. KG ist seit über 30 Jahren ein leistungsfähiges Unternehmen aus dem Messtechnikbereich und haben uns seit der Gründung der Messdatenerfassung verschrieben.
Nitrilhandschuhe versus Latexhandschuhe
Warum der Trend zu Nitril geht.
Immer mehr Einkäufer steigen beim Einkauf von Reinraum-Handschuhen von Latexhandschuhen auf Nitrilhandschuhe um. Warum sich Nitrilhandschuhe so grosser Beliebtheit erfreuen und auch wir in unserem Onlineshop zunehmend Latexhandschuhe mit Nitrilhandschuhen ersetzen, erfahren Sie im folgenden Beitrag.
Newsletter Herbst 2021
Liebe Leserinnen und Leser
Bei uns lernen Sie nie aus!
Die Eule gilt in der Antike als Hüterin des Wissens und gilt als Symbol der Weisheit.
Was ist neu am Annex 1?
Sind Sie schon auf dem neusten Stand, was der Annex 1 betrifft?
Augrund grosser Nachfrage, wird dieses Web-Seminar am 22. November wiederholt.
Erfahren Sie mehr.
Zu Besuch im neuen Zuhause von SKAN AG in Allschwil
Herzlich empfangen bei SKAN AG
Zu Besuch bei Aseptconn AG
Aseptconn ist ein führender Anbieter von Komponenten, Systemen und Dienstleistungen für die flüssige Steriltechnik wie sie vor allem in der pharmazeutischen und biopharmazeutischen, sowie auch in weiteren kritischen Industrien verwendet werden. Unsere innovativen Produkte, in Verbindung mit fachkundiger Beratung tragen dazu bei, die Prozesse unserer Kunden nachhaltig zu verbessern. Die Kombination eines umfassenden Portfolios in Verbindung mit diversen Dienstleistungen macht Aseptconn zum präferierten Anbieter vieler namhafter internationaler Pharmaunternehmen.
Testo Industrial Services - Reinraumprüfung Filterlecktest
Die Durchführung von Filterlecktests gehört zu den Reinraumprüfungen, die unser GxP-Services-Team regelmässig für unsere Kunden durchführt. Daher erwartete das Team die aktualisierte Norm 14644-3:2020-08 mit grossem Interesse.
EU-MDR - Für die Medizintechnik-Industrie beginnt eine neue Zeitrechnung
Für Akteure im Bereich Medical Devices – Hersteller, Lieferanten, Händler, Importeure – gilt seit 26. Mai eine neue Zeitrechnung
Wir heissen Aseptconn AG herzlich willkommen als neuer SCC-Partner
Ihr Lösungsanbieter für flüssige Steriltechnik
Newsletter Sommer 2021
Liebe Leserinnen und Leser
Warum immer in die Ferne reisen…
Wann wird es endlich wieder Sommer…
Der Strandkorb ist nicht immer besetzt, weil wir auch in der Sommer-Urlaubszeit für Sie erreichbar sind.
Lehnen Sie sich gemütlich zurück und lesen Sie die spannende und leichte Sommerlektüre unserer SCC-Partner.
20. Swiss Cleanroom Community Event
20. Swiss Cleanroom Community Event
Wir wollten, wir durften und wir taten!
Noopli Schweiz Cleanrooms Best heissen wir in unserer SCC-Community herzlich willkommen.
Ihr Spezialist für Kontaminationskontrolle
GAP Analyse - wie kann ein Projekt während der Pandemie neu aufgegleist werden
Können Ansatzsysteme und Abfüllanlagen für die Steril-Produktion einfach nachgerüstet werden oder müssen übergeordnete technische, bzw. organisatorische Massnahmen (Containment) umgesetzt werden?
Pharmatronic durfte 2021 für ein Krebsforschungszentrum, welches vor dem Covid Ausbruch eine neue GMP-Produktionsstätte errichtet hat, eine GAP Analyse ausführen und neue Massstäbe setzen.
Seminartag "Anforderungen an die Reinraum-Lufttechnik" bei Unifil AG Filtertechnik
Endlich wieder ein Face to Face Seminar....
Valtria Swiss AG war heute zu Besuch bei uns
Valtria Swiss AG - Massgeschneiderte Reinräume für kontrollierte Umgebungen, Biosicherheits-Einrichtungen und prozessorientierte, schlüsselfertige Lösungen
Zu Besuch bei Camfil AG
Swiss Cleanroom Concept durfte heute bei Camfil Schweiz vorbeischauen. Ziel, für Sie, ein gemeinsames Seminar zu planen fürs 2022. Seien Sie gespannt!
Lieben Dank an Reto Candrian und Pascal Kaufmann für ihre Gastfreundschaft.
Corona Stories 2021
Swiss Cleanroom Concept durfte einen informativen und spannenden Tag am FHNW Campus Muttenz erleben. Ein grosser Dank geht an Skan AG (Giuseppe Cirillo), für die tolle Organisation! Es war schön, wieder einmal "Face to Face" Kontakt zu haben.
Wenn das Runde ins Eckige soll... dann ist wieder die Fussball-EM
Die D-A-CH-Elfer starten diese Woche in die Fussballeuropameisterschaft.
Kaiser engineering GmbH im neuem Besitz
Wir, das Kaiser-Team, freuen uns sehr auf unsere neue Herausforderung und hoffen, dass wir weiterhin auf Ihr Vertrauen und Ihre Treue zählen dürfen!
Unsere Blogbeiträge haben nun den Social Media Touch
Neu können Sie unsere Blogbeiträge analog Social Media:
- Ein «Like» geben
- Einen Kommentar erfassen
- Ebenso sehen Sie, welche Beiträge speziell beliebt sind und daher am meisten Besuche aufweisen.
Neuer Drying-Tunnel für B.Braun
Neuer Drying-Tunnel für B.Braun zur schnellen und effizienten Trocknung von Infusionsflaschen.
Für die neue Produktions-Anlage der Infusionsflaschen Ecoflac-Plus ® bei B.Braun haben die Verantwortlichen - neben vielen weiteren Kriterien - für die Trocknung der Flaschen zwischen dem Sterilisations-Autoklaven und der Flaschen-Etikettierung eine zeitliche Optimierung des Prozesses, eine kurze Umsetzungs-Phase und eine signifikante Reduktion der Betriebskosten gefordert
Identifikationen von Keimen aus dem Reinraum-Monitoring ... in Sekundenschnelle
Bei der Reinraum-Produktion von Heilmitteln und Medizinprodukten müssen umfassende und strenge Richtlinien befolgt werden, um ein sicheres Produkt zu erhalten. Besonders wenn eine terminalen Sterilisation des Produktes nicht möglich ist, wird ein besonderes Augenmerk auf das Umgebungsmonitoring gelegt. Ein Umgebungsmonitoring-Programm muss in der Lage sein, ungünstige mikrobiologische Bedingungen rechtzeitig zu erkennen, damit wirksame Korrektur- und Vorbeugemassnahmen eingeleitet werden können
Benutzerverwaltung bei Monitoringsystemen
Eine Benutzerverwaltung für das Monitoringsystem ist wesentlicher Bestandteil der normativen Grundlagen. Zum einen wird damit der Zugriff auf das System für einen bestimmten Kreis von Personen reguliert und zum anderen können darüber die unterschiedlichen Berechtigungsstufen umgesetzt werden. Dabei ist generell immer zwischen Lese- und Schreibrechten zu unterscheiden. Bei Systemen...
20. Swiss Cleanroom Community Event vom 21. Juni 2021
Das 20. Swiss Cleanroom Community Event findet neu am 5. Juli 2021statt
Einweg (Single-use) -Technologie und deren Peripherie-Produkte für die Life Science Branche
Die avintos AG ist ein führender Systemlieferant im Bereich der Fluidtechnik und bietet Gesamtlösungen zur Absperrung, Regelung, Transfer und Probenahme von Flüssigkeiten, Gasen und Feststoff en in der Prozesstechnik an.
Zu Besuch bei bioexam AG
Wir, Swiss Cleanroom Concept, (Frank Zimmermann und Beatrice Helene Tappenbeck) durften gestern einen Blick in die Labore unseres neuen SCC-Partners von Bioexam in Luzern werfen. Michael Meier, Geschäftsführer von Bioexam AG, zeigte uns die verschiedenen Geschäftsbereiche (Pharma, Kosmetik, Medizintechnik usw.) auf. Wir planen unsere Zusammenarbeit mit neuen Seminaren, für die Kosmetik und Pharmabranche, mit Besichtigung bei Bioexam auszubauen. Seien Sie gespannt, wir halten Sie auf dem Laufenden.
Markteinführung des Lasair® Pro Airborne Partikelzählers
12. Mai 2021 Boulder, CO – Particle Measuring Systems (PMS) verkündet die Veröffentlichung des neuen Lasair® Pro Airborne Partikelzählers.
Investis erwirbt Rohr AG
Investis erwirbt Rohr AG und baut Segment Real Estate Services weiter aus
Remote-Partikelzähler der nächsten Generation
Particle Measuring Systems bringt Remote-Partikelzähler der nächsten Generation mit benutzerdefinierter Flexibilität raus
Das anpassungsfähige neue IsoAir® Pro-Plus ist eine weitere Option in den anpassbaren Reinraumüberwachungslösungen von Particle Measuring Systems.
Digitale Prozessoptimierung für Industrie & Mittelstand 4.0
Die SAMSON AKTIENGESELLSCHAFT und die InfraServ GmbH Co. Wiesbaden KG haben einen wichtigen Meilenstein im Rahmen einer Kooperation für digitale Transferlösungen in Richtung einer Industrie 4.0 erreicht. SAMSON ist ein führender Anbieter von System- und Produktlösungen für die Steuerung und Regelung von Medien aller Art mit mehr als 110 Jahren Kernkompetenz in der Stellventiltechnik.
EU-MDR - Stichtag am 26. Mai 2021 - Für eine Branche tickt der Countdown
Für Akteure im Bereich Medical Devices – Hersteller, Lieferanten, Händler, Importeure – gilt seit 26. Mai eine neue Zeitrechnung
150 Jahre Bardusch
Ettlingen, 5. Mai 2021 – 2021 wird der Textildienstleister Bardusch 150 Jahre alt. Selbstverständlich hatten sich alle Verantwortlichen das Jubiläumsjahr anders vorgestellt – und gewünscht.
Systemlösungen - Spezialisierte Lösungen rund um den Reinraum
Produkt-Recherche einmal anders: Neu können DELTA-Kunden in unserem interaktiven Reinraum auf Entdeckungsreise gehen: shop.delta-zofingen.ch/reinraum-kompetenz
Reinraumtücher "CELOS Wiper" jetzt bei abovo - welche sind wofür?
Der Onlineshop für Reinraum- und ESD-Produkte abovo hat jetzt auch «CELOS Wiper»-Reinraumtücher im Programm. Von den «CELOS Wiper»-Tüchern gibt es zurzeit über zehn verschiedene Ausführungen. Welches Modell für den jeweiligen Einsatzzweck und Reinraumtyp am besten geeignet ist, erfahren Sie in diesem Artikel.
Gut behütete Kunstwerke: mit Hilfe der BRIEM-Monitoring-Software (BMS)
Das Schlossmuseum in Linz gibt auf über 10.000 m² Ausstellungsfläche einen umfangreichen Einblick in die Natur-, Kultur- und Kunstgeschichte Oberösterreichs vom Beginn des Lebens bis ins 21. Jahrhundert.
Die Dauerausstellungen, im historischen Schloss sowie im neuen Südtrakt, sind breit gefächert. Sie reichen von der Erdgeschichte bis zur Zeitgeschichte.
pH-neutrales Derougen - Jetzt auch ohne Schutzgas möglich
Auch bei der Chemie gehen wir auf Nummer Sicher, weshalb wir Ihnen gerne unser neustes Mitglied des DIRU-Produktesortiments vorstellen.
Gesucht Projektingenieur-/in (Pharma) 100%
Wir Ingenieure von QPS Engineering bieten Ihnen servicegerechte und qualitativ hochwertige Projektlösungen in den Bereichen Engineering, Consulting, Projektmanagment, Prozessoptimierung und Mapping an. Unsere Kompetenzfelder: Biotechnik, Pharmatechnik, Lebensmitteltechnik und Kunststofftechnik.
Bioexam heissen wir als neuen SCC-Partner herzlich willkommen
Als akkreditiertes (ISO/IEC 17025, STS 268), unabhängiges, GMP-zertifiziertes und FDA-registriertes Labor verfügt die Bioexam AG über das gesamte Spektrum der pharmazeutischen Industriemikrobiologie und ist Ihr Partner für Reinraumanalytik.
Newsletter Frühling 2021
Hurra, der Lenz ist da
Auch dieses Jahr haben wir wieder ein reichhaltig gefülltes Osternest-Menü für Sie zusammengestellt. Nur die feinsten Zutaten haben wir dafür verwendet. Die ausgereiften Seminare werden durch unsere erfahrenen Referenten vollendet. In smarten Webinaren lernen Sie, in Kürze liegt die Würze, zu schätzen. Das mehrgängige und variable Inhouse Schulungsmenü bringen wir direkt zu Ihnen vor Ort.
Das Sahnehäubchen zum Ende des Quartals, erleben Sie als Besucher, am Swiss Cleanroom Community Event vom 21. Juni 2021.
Sailer Hygienic Design Magnet jetzt mit umfangreichem Zubehörprogramm
Nach dem Erfolg des Sailer Hygienic Design Magneten bringt die Friedrich Sailer GmbH nun eine umfangreiche Produktreihe passenden Zubehörs zur Befestigung am Magneten auf den Markt. Viele clevere Spender, Halter und Adapter wurden entwickelt, um den Kunden noch mehr Einsatzmöglichkeiten für diese innovative Befestigungslösung für Reinräume zu bieten.
Erfüllt Ihr Händedesinfektionsmittel die EN1500-Norm und ist es als Biozid zugelassen?
Erfüllt Ihr Händedesinfektionsmittel die EN1500-Norm und ist es als Biozid zugelassen?
Mit Schülke-Produkten zu hervorragenden Ergebnissen.
Wir bieten Ihnen qualitativ hochstehende Desinfektionsprodukte für Hände und Flächen. Sei es im Pharma- und Life Science- Bereich oder in der Lebensmittelproduktion.
Aero-Pro GmbH heissen wir als neuen SCC-Partner herzlich willkommen
Die Aero-Pro GmbH unterstützt verschiedene Einrichtungen bei der Umsetzung von Hygienekonzepten und ist fokussiert auf hocheffiziente Luftfiltration im Premium-Bereich. Wir sind Schweizer Generalimporteur der Produkte von SiDOPA Care. Unsere hochkarätigen Lösungen werden hergestellt in Baden-Württemberg, Deutschland und stehen für nachhaltige und innovative Filter- und Medizintechnik. Der Hersteller verfügt über eine 20-jährige Expertise in unterschiedlichen Branchen und greift daher auf ein umfassendes Know-how zurück.
Cleanroom safety from D to A
triple packaging
sterile from D to A
safe with bag-in-bottle: vacuum for maintained sterility
Produktionshygiene, die Plus macht
Produkte schützen Menschen und Materialien in der Pharmaindustrie vor Kontaminationen und Übertragungsrisiken während des gesamten Produktionsprozesses. Personal- und Produktionshygiene sowie Anlagenhygiene sind wichtige präventive Massnahmen, die eine entscheidende Rolle zur Vorbeugung von Keimbefall spielen
Raumluftreinigung Covid19 Durrer Krantz Virusprotect
Der Hersteller Krantz bietet hierzu eine Möglichkeit den Virusprotect Live Online kennen zu lernen:
Nächste Live Online Demonstration am 05.03.2021um 10.00 Uhr!
Bitte hierzu folgenden Link verwenden oder das beiliegende Outlook-Element in den eigenen Kalender kopieren:
Join meeting using StarLeaf app
https://meet.starleaf.com/4916407379/app
Dicht ist nicht gleich dicht
Endlich besteht die Möglichkeit, bereits bei der Planung von Reinräumen und Containments auf geprüft dichte Komponenten zugreifen zu können.
Wir heissen REUPLAN GmbH als neuen SCC-Partner herzlich Willkommen
Wir freuen uns Ihnen REUPLAN GmbH als neuen SCC-Partner vorstellen zu können.
Wir heissen Friedrich Sailer GmbH als neuen SCC-Partner herzlich Willkommen
Friedrich Sailer GmbH – Spezialist für Reinraumeinrichtungen
Newsletter Winter 2021
In der Stille und Geduld des Winters liegt die Kraft für das Neue
Durch das vergangene spezielle Jahr wurde man dazu ermuntert, innovativ und kreativ sein, sich weiter zu entwickeln. Diese Chance haben wir genutzt und um diverse Geschäftszweige anzupassen und zu verbessern. Mehr dazu, im Laufe dieses Newsletters
Wir sehen uns, am nächsten Swiss Cleanroom Community Event vom 19. April 2021 in Pratteln, oder an einem unserer Seminaren. Jetzt wünschen wir Ihnen viel Freude beim Lesen unserer News.
Ihr Swiss Cleanroom Concept Team
MBV AG und MERCK KGaA
MBV AG und MERCK KGaA erneuern weltweite Vertriebsvereinbarung für marktführende Geräte zur mikrobiellen Luftüberwachung
5 Märchen über Reinraum-Handschuhe
Eines der häufigsten Missverständnisse bei Einweghandschuhen ist:
Ein ungewöhnliches und herausforderndes Jahr geht zu Ende.
Ein ungewöhnliches und herausforderndes Jahr geht zu Ende.
Wir wünschen Ihnen frohe Festtage und sagen DANKE
Liebe Freunde und Geschäftspartner
Das Jahr 2020 ist ein Jahr, welches uns allen sicher in Erinnerung bleiben wird.
Wir mussten lernen, mit ungeahnten Einschränkungen umzugehen. Liebgewordene Gewohnheiten und menschliche Nähe waren plötzlich keine Selbstverständlichkeit mehr.
Herzlich Willkommen Splendida Services AG, als neuer SCC-Partner.
Glänzende Aussichten
Partikelmessung über WLAN
Entdecken Sie neue Möglichkeiten beim Reinraum-Monitoring
REGULATORY CONSULTING - wie sattelfest sind Sie bei Audits und Inspektionen?
Der aktuelle COVID-19-Ausbruch führt zu einer dringenden Nachfrage nach Impfstoffen, welche die stufenweise Immunisierung der Bevölkerung ermöglichen.
Qualität für Ihr Gebäude
Die Rohr AG transformiert sich aufgrund von veränderten Kundenbedürfnissen.
Plair und MBV unterzeichnen eine Kooperationsvereinbarung
Plair und MBV unterzeichnen eine Kooperationsvereinbarung zur Entwicklung von Lösungen der nächsten Generation für den schnellen Nachweis von Mikroorganismen.
Visionen für den klimaschonenden Reinraumbetrieb
Für viele Reinraumanwendungen ist keine definierte Luftdichtheit erforderlich, insbesondere wenn die Einhaltung des Produktschutzes oder des Umgebungsschutzes dies nicht verlangen.
STZ EURO: Zukunftssicher Ressourcen schonen auf Basis der VDI 2083-19
GDP-Mapping von Räumen und Geräten
Räumlichkeiten oder Geräte in denen temperaturabhängige pharmazeutische Produkte gelagert oder transportiert werden, müssen dafür geeignet sein. Ein Mapping bringt den notwendigen Nachweis, und ist ein elementarer Baustein in der Qualifizierung Ihrer Räume oder Geräte.
Neues Mitglied in der Geschäftsleitung bei MBV AG
Die MBV wächst und erweitert die Geschäftsleitung um Norbert Schorpp. Als neues Mitglied der Geschäftsleitung übernimmt Norbert Schorpp als Chief Operating Officer (COO) die komplette Verantwortung der internen Wertschöpfungskette.
Als ausgewiesener Fachmann mit langjähriger Führungserfahrung verfügt Norbert Schorpp über ideale Voraussetzungen, die kontinuierliche Weiterentwicklung der MBV auf unsere Kunden fokussiert mitzugestalten.
Swiss Cleanroom Concept hat Verstärkung bekommen
Liebe Community.
Ich bin Beatrice Tappenbeck und ab sofort für Swiss Cleanroom Concept tätig. Meine Haupttätigkeiten werden das Marketing und Business Development und die Entlastung des Geschäftsführers sein.
Als Quereinsteigerin in der Pharmabranche freue ich mich auf diese Herausforderungen. Mein branchenspezifisches Wissen dazu, erlange ich selbstverständlich durch die Seminare. Sie haben Fragen, Anregungen und Wünsche? Dann zögern Sie nicht ...
Dichtheitsprüfung S3-Labor unter Extrembedingungen
Die VDI-Richtlinie 2083-19, zur Dichtheit von Reinräumen, berücksichtigt bereits in der Planungsphase alle relevanten Aspekte der Raumdichtheit und kann somit Labor- und Reinraumbetreiber vor bösen Überraschungen bewahren. Denn das Nachrüsten bestehender Labore und Reinräume ist oft mit aufwändigen Arbeiten verbunden, wie das STZ EURO am Beispiel eines Labors mit der biologischer Schutzstufe 3 zeigt.
Newsletter Herbst 2020
Mit uns stranden Sie nicht!
Wir bringen Sie sicher in den nächsten Hafen. Bleiben Sie mit uns auf Erfolgskurs. Unsere Know-how-Träger helfen Ihnen die Klippen und Riffe sicher zu umschiffen.
Wir sehen uns, am nächsten Swiss Cleanroom Community Event vom 2. November 2020 in Pratteln, oder an einem unserer Seminaren. Jetzt wünschen wir Ihnen viel Freude beim Lesen unserer News.
Ihr Swiss Cleanroom Concept Team
19. Swiss Cleanroom Community Event
Es ist eingetroffen, was wir uns so nicht gewünscht haben. Der Bundesrat (höhere Gewalt) hat entschieden, dass Veranstaltungen mit nur noch max. 50 Personen durchgeführt werden dürfen. Aus diesem Grund sehen wir uns gezwungen, das Event leider absagen zu müssen. Wir bedauern diesen Entscheid und hoffen, Sie im kommenden Jahr wieder am Event am 21. Juni oder 8. November 2021 dabei zu haben.
Neumitglied der SCC: complean gmbh, Affoltern am Albis
Die Ingenieure/-innen der complean gmbh sorgen für zuverlässige Projektausführungen im GMP-pflichtigen sowie regulierten Umfeld und unterstützen ihre Kundschaft bei Neu- oder Umbauten von Rein- und Reinsträumen sowie von Produktionstätten. Seit Oktober 2020 ist die complean gmbh («complean») neues Mitglied der Swiss Cleanroom Community.
Das Team freut sich bereits, spätestens am 2. November während des 19. SCC-Events bisherige Mitglieder kennenzulernen und sich mit vielen Fachkräften auszutauschen. Sie sind überzeugt, dass auch sie die Community bereichern und einige Beiträge leisten werden.
Besuchen Sie uns am 19. Swiss Cleanroom Community Event
Hier trifft sich die Cleanroom Community! am Montag, 02. November 2020 in Pratteln. 36 Firmen präsentieren mit eigenem Stand und kompetenten Mitarbeitern ihre Produkte und Dienstleistungen. Die rund 200 Teilnehmer des Events kommen ihrerseits aus über 130 Firmen. Melden Sie sich jetzt kostenlos an.
Seminare unter Einhaltung eines Schutzkonzeptes sind möglich
Wir, Swiss Cleanroom Concept, konnten die Seminare, unter Einhaltung eines Schutzkonzeptes, endlich wieder aufnehmen. Ein grosses Dankeschön an die Teilnehmer der letzten paar Tage und Ihr Vertrauen in uns. Wir freuen uns, Ihnen wieder Wissen vermitteln zu dürfen.
Lieferengpässe bei Vlies-Einweg-Hygienebekleidungen!
Corona Pandemie verursacht Lieferengpässe bei Vlies-Einweg-Hygienebekleidungen! Die Alternative heisst Micromesh und Micromesh «Plus» von Solida AG
Die Corona Pandemie hat zu einer nie dagewesenen, weltweiten «Mundschutz» Nachfrage geführt. Die Folge war eine massive Verknappung von Polypropylen Vliesmaterial.
Tipps beim Kauf von Reinraumtüchern
Wissen Sie, worauf Sie bei diesem grossen Angebot von Reinraumtüchern in verschiedenen Aufmachungen und Materialien - zu verschiedenen Preisen - achten müssen? Nachfolgend finden Sie Vergleichskriterien von Reinraumtüchern, um Ihnen die Entscheidung zu erleichtern..
Reinraumtücher bestehen aus Materialien, die einen guten Oberflächenkontakt aufweisen müssen, damit die Partikel von der zu reinigenden Oberfläche weggedrückt werden können. Die Tücher dürfen die...
Methodik zur Strömungsvisualisierung endlich klar geregelt
GMP- und FDA-Inspektoren fordern zur Qualifizierung von Reinräumen seit Jahren den Nachweis der Luftströmungen über eine Visualisierung mit Rauch, auch Smoke Studies genannt. Der Umfang der Strömungsvisualisierung, das jeweilige Reporting und die Eckdaten zur Qualifizierung waren jedoch nicht konkret geregelt. Mit der neu überarbeiteten VDI-Richtlinie 2083 Blatt 3, wurde diese Lücke seit Februar dieses Jahres geschlossen.
Showroom von DELTA Zofingen AG ist wieder offen!
Wir freuen uns sehr, unsere Kundenberatungsgespräche wieder in unserem Showroom in Zofingen durchführen zu dürfen – natürlich unter den gebotenen Hygienemassnahmen. Speziell in dieser Zeit unterstützen wir Sie mit individuellen Systemlösungen rund um Hygiene, Sauberkeit und Sicherheit.
Corona-Monitoring
Corona-Monitoring als wichtiger Bestandteil Ihres Personalhygiene-Konzeptes. Die letzten Monate haben Ihnen sicher ebenso wie uns viel abverlangt. Die zahlreichen zusätzlich implementierten Hygieneregeln erforderten eine Vielzahl von Prozessanpassungen. Speziell die Änderungen der individuellen Verhaltensregeln sowie das Ausbleiben der zahlreichen internen und externen Kundenbesuche änderten Ihren und unseren Geschäftsalltag eindrücklich. Es gibt aber auch eine gute Nachricht für Sie...
Wir suchen eine/n Stellvertretender Niederlassungsleiter (m/w)
Sie unterstützen den Niederlassungsleiter im operativen Betrieb sowie wirken Sie bei anspruchsvollen Projekten und in der Auftragsakquisition mit. Von der Idee über die Konzeptionierung, Planung und Umsetzung bis hin zur Übergabe sind Sie zuständig für einen reibungslosen Ablauf. Als Ansprechperson für Kunden, Behörden, Unternehmer und Partner sind Sie in Zusammenarbeit mit dem Niederlassungsleiter zuständig für die optimale Koordination und Kommunikation.
Sommer Newsletter 2020
Um bei Ihnen kein Sommerloch entstehen zu lassen, haben unsere Partnerfirmen viele Neuigkeiten, innovative Lösungen, Wissenswertes, Tipps und Anregungen geliefert. Daraus ist nun ein gemixter feiner Sommer-Cocktail-Newsletter entstanden.
Natürlich schauen wir jetzt schon nach Vorne in den Herbst und wollen Ihnen heute schon den Swiss Cleanroom Community Event vom 2. November in Pratteln schmackhaft machen.In diesem Sinne, gemäss unserem Sommermotto: «Das Sommerloch kennen wir nicht, wir arbeiten für für Sie weiter» wünschen wir Ihnen eine erholsame Sommerzeit,
Unsere Mission in Life Sciences: Patientensicherheit
In enger Partnerschaft mit unseren Kunden trägt Agidens zur Sicherheit von Patienten und Verbrauchern bei.
Mit mehr als 25 Jahren Erfahrung im Life Science Bereich, unserer einzigartigen Kombination aus Automatisierungslösungen sowie Validierungs- und Compliance-Unterstützung, bieten wir unseren Kunden technische Beratung und nachhaltige Lösungen.
Newsletter Sommer 2020
Um bei Ihnen kein Sommerloch entstehen zu lassen, haben unsere Partnerfirmen viele Neuigkeiten, innovative Lösungen, Wissenswertes, Tipps und Anregungen geliefert. Daraus ist nun ein gemixter feiner Sommer-Cocktail-Newsletter entstanden.
Natürlich schauen wir jetzt schon nach Vorne in den Herbst und wollen Ihnen heute schon den Swiss Cleanroom Community Event vom 2. November in Pratteln schmackhaft machen.In diesem Sinne, gemäss unserem Sommermotto: «Das Sommerloch kennen wir nicht, wir arbeiten für für Sie weiter» wünschen wir Ihnen eine erholsame Sommerzeit,
Kampf gegen Viren und Krankheitskeime
Einhaltung der Hygienekette - Polytex Textilautomaten im Kampf gegen Viren und Krankheitskeime. Hygiene ist in der Corona-Pandemie wichtiger denn je. Auch die Ausgabe von Arbeitskleidung erreicht eine hohe Brisanz als Folge der Verbreitung des neuartigen Coronavirus. Die Ausgaberäume stellen eine Herausforderung dar, da sie stark frequentiert sind. Mit Polytex Kleiderausgabeautomaten kann jede Klinik die RKI-Richtlinien und den RABC Standard EN 14065 (Risk Analysis and Biocontamination Control) erfüllen. Der hygienische Kreislauf bleibt sichergesellt
Lamsystems CC feiert 20. Gründungstag
Lamsystems CC wurde im Jahr 2000 gegründet und hat einen dynamischen Entwicklungspfad bekommen. Heute verfügt das Unternehmen über eine leistungsstarke Produktionsbasis, die mit modernen Werkzeugmaschinen und Geräten ausgestattet ist. Das Unternehmen beschäftigt hochqualifizierte Spezialisten, die über besonderen Technologien für die Herstellung hochpräziser Geräte verfügen. Die Geräte erfüllen alle modernen Anforderungen, notwendigen für die Ausstattung von Labors, Forschungszentren, den Bau von Reinräumen und Reinräumzonen.
18. Swiss Cleanroom Community Event
Lange waren wir nicht sicher, ob wir das 18. Swiss Cleanroom Community Event durchführen dürfen. Zum Glück hat sich dann die Lage entspannt und wir konnten, unter Berücksichtigung eines Schutzkonzeptes, das Event durchführen. Die vielen positiven Rückmeldungen der Besucher und Aussteller, wieder den Schritt zurück in die Normalität einzuleiten, haben uns sehr gefreut.
Schön wars...wir sehen uns am 2. Nov. 2020
Zusammenkunft ist ein Anfang. Zusammenhalt ist ein Fortschritt. Zusammenarbeit ist der Erfolg. In diesem Sinne bedanke wir uns bei allen Referenten, Austellern und Besuchern für das erfolgreiche 18. Swiss Cleanroom Community Event. Wir freuen uns jetzt schon, euch alle am kommenden Event vom 2. November 2020, wieder willkommen zu heissen.
Besuchen Sie uns am 15. Juni 2020
Wir freuen uns Sie am 18. Swiss Cleanroom Community Event am Montag, 15. Juni 2020 in Pratteln begrüssen zu dürfen.
Dieses Event mit Kleinmesse-Charakter bietet der GMP – und Reinraumbranche das optimale Ambiente für einfaches und erfolgreiches Networking. Nutzen Sie diese face-to-face experience und generieren Sie hochwertige Leads!
Spatenstich für neues Pharmaverpackungswerk
Mit dem ersten Spatenstich hat der Spezialglashersteller SCHOTT an seinem Standort Müllheim den Startschuss für den Bau einer neuen Produktion für sterile pharmazeutische Primärverpackungen aus Polymer gegeben. Das mit Unterstützung von IE Plast geplante und zu realisierende topmoderne Werk soll bis 2022 mit einem Investitionsvolumen im dreistelligen Millionenbereich errichtet werden und dann 100 zusätzliche Arbeitsplätze bieten.
Erfolgreiche Projektübergabe für Roche-Immobilie LSL in Kaiseraugst
Freudige Gesichter beim Drees & Sommer-Projektteam für das Büro- und Produktionsgebäude LSL der F. Hoffmann-La Roche AG in Kaiseraugst bei Basel: Am 5. April 2019 konnte die Immobilie termingerecht an den Kunden übergeben werden. Dafür gab es lobende Worte von Roche-Projektleiter Hans Tanner und vom Nutzer-Verantwortlichen Frans Hoeks. Bereits 2012 wurde Drees & Sommer als Generalplaner beauftragt.
Neue Fallstudie von Jobst Willers Engineering AG
Wenige Gehminuten von unserem Berner Standort gelegen, entwickelte unser Team als Fachingenieure HLK und Gebäudeautomation das Energiekonzept und koordinierte die gesamte Gebäudetechnik des sitem-insel. Die ersten Nutzer haben ihre Flächen im Verlauf des Frühlings 2019 bezogen. Die letzte grössere Nutzerfläche für den Ausbau, ein Biosicherheitslabor, wird gerade vorbereitet. Die geplante Übergabe...
Ecolab offers insights into the latest Annex 1 updates
The latest draft of EudraLex Vol. 4, Annex 1 (v.12), features updates to the guidelines following the public consultation feedback on the 2017 draft. Ecolab have carried out a thorough review to assess the changes relating to cleaning and disinfection and the implications for end users.
Verlieren Sie keine Zeit bei der optimalen Reinigung von Produktionsanlagen!
Sprechen Sie mit uns! Wir begeistern Sie mit integrierten deconex® Lösungen für die anspruchsvolle Reinigung im GMP-Umfeld.
Regelwerke fordern eine kontinuierliche Verbesserung des Reinigungsprozesses nach dem Life Cycle Ansatz. Die Borer Chemie AG übernimmt die Entwicklung optimaler Reinigungsprozesse. Diese sind auf die Anlagen und Produkte des Kunden angepasst. Unsere Lösungen sind wirksam und wirtschaftlich.
Die Firma Vaisala stellt den neuen Indigo Messwertgeber vor
Der jahrzehntelange Erfolg von Vaisala als beliebtester Hersteller von Feuchtemesswertgebern auf dem Markt setzt sich mit dem neu eingeführten Messwertgeber Indigo 520 fort. Dieser kombiniert modernste Technologie und herausragende neue Funktionen. Der Messwertgeber hat Platz für bis zu zwei Sonden gleichzeitig. Er sorgt selbst in rauesten industriellen Messumgebungen für mehr Komfort, Kompatibilität und kontinuierliche Genauigkeit.
Sie benötigen Unterstützung von Automationsspezialisten?
Aktuell sind wir auf der Suche nach einem Projekt für unsere Automationsspezialisten im Bereich Siemens und/oder Ifix.
Sie benötigen Automationsunterstützung im regulierten Bereich wo GAMP5 und GMP kein Fremdwort ist, dann lassen Sie uns dies wissen.
Konformität schafft Vertrauen
NEU bei CRT - Thermische Prozessqualifizierung
Die CRT Cleanroom-Technology AG bietet nun auch Anlagen- und Prozessqualifizierungen im regulierten Umfeld der Fertigung, der Forschung oder dem Gesundheitswesen an. Diese Dienstleistung ist elementarer Bestandteil von Qualität, denn temperaturrelevante Prozesse sind auf Konformität zu prüfen, um so ihre Sicherheit und Zuverlässigkeit zu maximieren.
Ein Blick auf die Uhr genügt
NFC ist die Abkürzung für „Near Field Communication“. Mit diesem Funkstandard lässt sich zum Beispiel mit dem Smartphone kontaktlos bezahlen oder der Zugang zu Gebäuden kontrollieren. Diese Technik ermöglicht es aber auch, schnell und sicher Messwerte zu übertragen.
abovo-Onlineshop für Reinraum- und ESD-Produkte nun auch auf französisch
Die Angebote im abovo-Onlineshop für ESD- und Reinraum-Produkte stehen den Webseiten-Besuchern jetzt auch in französischer Sprache zur Verfügung. Damit richtet sich abovo insbesondere an die Interessenten in der Romandie.
Newsletter Frühling 2020
Dieser Frühling steht unverkennbar unter dem Zeichen von Corona. Eine Situation, die vor wenigen Wochen undenkbar gewesen wäre, ist eingetreten. Unser gewohntes Leben hat eine drastische Wende erfahren.
Gleichzeitig tun sich ungeahnte Möglichkeiten auf. Der Shut-Down schenkt vielen von uns die Zeit, das Bisherige zu reflektieren und neue Ideen für die Zukunft anzudenken.
Nutzen wir die Corona Situation als Chance
Aufgrund der aktuellen Verordnungen des Bundes ist es uns nicht möglich, Seminare live abzuhalten. Einen Teil der geplanten Weiterbildungen haben wir in den Herbst verschoben. Die neuen Daten finden Sie auf der Webseite. Das Basisseminar für Reinraummitarbeiter werden wir aber wie geplant abhalten. Absolut keimfrei und konform im Rahmen eines Webinars.
Überwachung von Umgebungsparametern in reinen Räumen
Das Vaisala viewLinc Überwachungssystem ist eine vielfach bewährte Lösung für die kontinuierliche Überwachung in der Biowissenschaft und anderen anspruchsvollen Branchen. Mit dem viewLinc Überwachungssystem können Sie die Produktqualität für Anwendungen sicherstellen, in denen eine kontinuierliche Überwachung von entscheidender Bedeutung ist...
Kennen Sie Ihre PDE-Werte?
Die Anforderungen an die Festlegung von Grenzwerten für die Reinigungsvalidierung haben sich mit der Revision des Anhangs 15 zum EU-GMP-Leitfaden grundlegend geändert. Gefordert wird nun eine wissenschaftliche, substanzspezifische Begründung für die Grenzwertberechnung für Wirkstoff- und Reinigungsmittelrückstände.
Sichern Sie sich jetzt noch kurzfristig einen Seminarplatz am 5. März
Rückblick auf das Intensivseminar für Reinraum Quereinsteiger
Das Intensivseminar für Reinraum Quereinsteiger mit fast 20 Teilnehmern Ende Januar war wieder ein toller Anlass. Praxisnahe Referate zu verschiedenen Themen, gespickt mit Workshops und interessante Gespräche, gaben den Teilnehmern einen guten Einblick in die GMP Welt.
Kühles Blut bewahren
Ein Erythrozyten-Konzentrat ist eine aus roten Blutzellen, den Erythrozyten, bestehende Blutkonserve. Damit diese keinen Schaden nimmt, ist sie mit einer genau definierten Temperatur im Kühlschrank zu lagern. Durch häufiges Öffnen und Schließen kann diese jedoch über- oder unterschritten werden. Ein Monitoring-System muss sicherstellen, dass bestimmte Grenzwerte eingehalten werden, damit der Anwender frühzeitig reagieren kann.
Wir investieren in Ihre Sicherheit
Roxtec hat vor gut einem Jahr ein neues Brandversuchslabor in Betrieb genommen.
Das Labor befindet sich am Hauptsitz von Roxtec in Karlskrona, Schweden.
Es spielt eine Schlüsselrolle bei der Produktentwicklung und beim Zertifizierungsprozess.
Energie Optimierung in Laboreinrichtungen und im Reinraum
Wo ist die Wertschöpfung bei einem zweistufigen Ansatz der Luftwechselzahl je nach Schichtmodell? Soll der Betriebsmodus (Tag versus Nacht) bereits in der Planungsphase bei Neubauten berücksichtigen werden? Lohnt sich später eine Investition in der Lüftungsoptimierung bei einem laufenden Betrieb?
Newsletter Winter 2020
Ein neues Jahr hat seine Pforte geöffnet. Wir hoffen, Sie haben fröhliche und erholsame Festtage erlebt und wünschen Ihnen einen beschwingten Start in ein gesundes, erfolgreiches, in jeder Hinsicht erfreuliches 2020.
Auch wir sind gespannt, was es bringen wird, welche Neuerungen uns erwarten. Unser Ziel ist es, vorauszuschauen, damit wir Sie mit unseren über 50 Referenten immer aktuell an den Seminaren informieren können. Gerne unterstützen wir Sie auch mit Recruiting & Coaching, E-Learning, Lunch and Learn. Unsere SCC-Partner stehen Ihnen tatkräftig bei Ihren Projekten zur Seite.
Innovative Services von SKAN Pure Solutions...
... erhöhen die Arbeitssicherheit und schaffen Vertrauen. Regelmässige Wartungen sind elementar um die Schutzfunktion von Sicherheitswerkbänken, Laborabzügen und reinen Bereichen aufrecht zu erhalten. Der Servicebereich von SKAN Pure Solutions bietet immer wieder Innovationen zum Wohl der Anwender.
Schlanke Qualifizierung
Formalismus senken, Nutzen fördern – Effiziente GMP-Compliance für Neu- und Umbauprojekte
Den Aufwand der Qualifizierung abspecken. Mit Maß und Umsicht. Der GMP-Dienstleister gempex GmbH bietet hier Unterstützung - „Schlanke Qualifizierung“. Auf Wunsch wird nicht nur die Konzeption der Qualifizierung übernommen, sondern auch...
Reinraum Service - Textile Dienstleistungen für Reinräume
Mit dem Reinraum Service bedient bardusch die besonderen Qualitätsansprüche der Pharmaindustrie, der Medizinaltechnik und der Mikroelektronik. Zum Schutz der Produkte vor einer Kontamination durch das Personal offeriert bardusch Reinraum-Mehrwegkleidung für die ISO-Raumklassen 5 und 7. Als spezialisierter Dienstleister für Reinräume, unterstützen wir Sie mit der professionellen Wiederaufbereitung und einer lückenlosen Logistikkette dabei, die Rahmenbedingungen für hochsensible Produktionsprozesse zu erfüllen.
Advents-Special
Advent, die Zeit der Adventskalender und des Türchen Öffnens.
Werfen wir gemeinsam einen Blick hinter eine ganz besondere Türe:
Die Türe zu sich selbst.
Gesucht Projektingenieur Versorgungstechnik - Reinmedien
Wir Pharmaplan AG suchen zum nächstmöglichen Zeitpunkt für unser Büro in Basel und unsere Projektstandorte in der Deutschschweiz einen
Projektingenieur Versorgungstechnik - Reinmedien (m/w) – Vollzeit (100%)
17. Swiss Cleanroom Community Event
Am 4. November durften wir das 17. Swiss Cleanroom Community Event durchführen. Nahezu 200 Teilnehmer, die über 130 Firmen vertraten, folgten unserer Einladung. Die tolle Stimmung und die vielen guten Gespräche hallen immer noch nach.
17. Swiss Cleanroom Community Event am 4. November
Dieses Event mit Kleinmesse-Charakter bietet der GMP – und Reinraumbranche das optimale Ambiente für einfaches und erfolgreiches Networking. Nutzen Sie diese face-to-face experience und generieren Sie hochwertige Leads!
Update ohne grossen Aufwand!
Vorgesetzte stehen häufig vor dem Dilemma, dass sie einerseits ihre Mitarbeitenden fördern und entwickeln möchten, andererseits schwer auf deren Arbeitskraft verzichten können, wenn diese an einer Weiterbildung teilnehmen möchten.
Über neue Regulatorien Bescheid wissen, sich auf technischem Gebiet auf dem Laufenden zu halten, ist für die GMP- und Reinraumszene trotzdem essentiell.
Wie bekommen Sie alle Bedürfnisse unter einen Hut?
Haben Sie Ihre Datenintegritätsanforderungen im Griff?
Die Datenintegritätsanforderungen in der pharmazeutischen Industrie steigen stetig an. Grund sind unter anderem „Findings“ der Aufsichtsbehörden aber auch die Komplexität der heutigen Datenflut.. Sichern Sie sich jetzt noch einen Platz am Seminar "Datenintegrität im GMP Umfeld" vom 16. Oktober
Newsletter Herbst 2019
Der Sommer verabschiedet sich nun langsam. Der Herbst kehrt ein und die bunten Wälder zeigen sich in ihrer farbigen Pracht. Seien Sie gespannt was Ihnen unsere SCC-Partner an Möglichkeiten aufzeigen, wie Sie das ein oder andere Problem locker mit deren Support lösen können.
Wir nutzen die Herbstzeit, um für Sie unser Angebot zu erweitern und zwar mit Recruiting & Coaching, E-Learning, Lunch and Learn oder neuen Seminaren.
Abdichtungssysteme für Labore der Sicherheitsstufen 1-3
Im März 2019 wurde der neue Dienstsitz des Landeslabors Berlin- Brandenburg (LLBB) am Standort Adlershof schlüsselfertig übergeben. Als moderner Dienstleister führt das LLBB Untersuchungen und Begutachtungen von Lebensmitteln, Kosmetika, Medikamenten, Gewässern aber auch Chemikalien und Tierseuchen durch. Der neue Komplex verfügt über mehrere Labore der Sicherheitsstufen 1-3.
Reinigung und Desinfizieren
Der Entwurf für den EU-GMP-Leitfaden zur Guten Herstellungspraxis, Anhang 1, wird aktuell breit diskutiert. In vielerlei Hinsicht ist dies begrüßenswert, da so Interesse, Engagement und Einbindung entstehen. Nachteilig ist allerdings die Tatsache, dass so auch unrichtige Informationen verbreitet werden könnten. Daher sollten Arzneimittelhersteller gebührende Sorgfalt walten lassen, bevor sie Verfahren ändern..
Seminar Umgang mit hochaktiven Substanzen bei SKAN
Hochaktive Substanzen in der pharmazeutischen Herstellung gewinnen immer mehr an Bedeutung.
Bis zum Jahr 2022 wird jede zweite Substanz in der Bio – Pharmazeutischen Herstellung als hochaktiv eingestuft.
Kann die Digitalisierung Kosten einsparen?
• Ist die Digitalisierung ein Trend?
• Welchen qualitativen und wirtschaftlichen Nutzen hat die Digitalisierung?
• Welche Vor- und Nachteile, bzw. Chancen und Risiken bringt die Digitalisierung?
Viele Fragen über das Thema Digitalisierung, doch was ist die richtige Antwort?
MBV AG bietet neu ein akkreditiertes Kalibrierlabor
Noch mehr Sicherheit und Service mit dem akkreditierten Kalibrierlabor.
Mit ihren hochwertigen Luftkeimsammlern steht die MBV AG seit jeher für höchste Präzision und Effizienz bei der Bestimmung der mikrobiellen Verunreinigung von Luft. Doch auch das beste Gerät muss von Zeit zu Zeit gegen internationale Standards kalibriert werden, damit die einwandfreie Funktionsweise gewährleistet werden kann.
Keine neuen Mitarbeiter finden - was tun?
Von Geschäftsführern der Branche hören wir immer wieder, wie schwierig es ist, neue, geeignete Mitarbeiter zu finden. Der Markt sei ausgetrocknet, die Leute verfügten nicht über das erforderliche Wissen. Sie stehen immer wieder vor der Herausforderung, Lösungen für dieses Problem zu finden, zumal die Aufträge da sind und erledigt werden wollen.
Newsletter Sommer 2019
Der Sommer startet jetzt richtig. Für die einen wird es jetzt vermutlich zu heiss und sie sind froh, wenn sie in den gekühlten Reinraum gehen dürfen. Wir nutzen die Sommerzeit, um für Sie unser Angebot zu erweitern und zwar mit Recruiting & Coaching, E-Learning, Lunch and Learn oder neuen Seminaren.
Entdecken Sie im Newsletter, welche innovativen Lösungsansätze unsere Partner gefunden haben, wie sie bei ihren Kunden die Effizienz steigern konnten und in welche Richtungen expandiert wird. Wir freuen uns, Ihnen heute wieder einen reichgefüllten Korb an Informationen überreichen zu dürfen und wünschen Ihnen viel Spass beim Lesen.
Signaletik: Wenn der Boden den Weg weist
Kautschuk-Beläge bieten Orientierung und setzen Gestaltungsakzente.
Wo geht es zur Notaufnahme, wo zur Fachabteilung oder zum Krankenzimmer?
Wer hat sich in Krankenhäusern nicht schon einmal bessere Orientierungshilfen gewünscht. Im Notfall können funktionierende Wegeleitsysteme sogar lebensrettend sein.
Quality by Design für Reinräume
Wie implementiere ich die Anforderungen bei einem Neubau für B/C Zonen?
Hersteller von Steril-Produkten sind beim flexiblen Design von Neubauten mit der Umsetzung des Zonen-Konzepts gefordert. Egal ob Spitalapotheke, Lohnhersteller oder Hersteller von Originalpräparaten, ein wichtiger Bestandteil in der Konzeptionierung ist...
Sporicidal Disinfection with User Acceptability
Ecolab’s New Sporicide Balances Effective Sporicidal Disinfection with User Acceptability
As it is an employer’s duty to protect the health, safety and welfare of their employees (EU Law on Occupational Health & Safety), the use of disinfectants in cleanrooms can present a significant challenge. This is especially true of sporicidal disinfectants which have a reputation for being aggressive and unpleasant to use.
Schnelle & einfache Identifikation von Prozesskomponenten
SAM EDOC - APP zur einfachen Bereitstellung von Produktinformationen
Heute ist die Durchgängigkeit von Prozessen und Wertschöpfungsketten von immenser Bedeutung. Diese Anforderungen führten unter anderem zur Entstehung der Forschungsunion Industrie 4.0.
Laborisolator SKANFOG® PURE
Geschlossenes Containment – bisher ein frommer Wunsch?
Viele Einrichtungen wie Labore und Spitalapotheken stehen vor einer Herausforderung:
Für den Umgang mit aktiven, zytostatischen Substanzen oder mit krankheitserregender Mikrobiologie wird das Arbeitsumfeld unter immer höhere Sicherheitsanforderungen gestellt.
Seminar Robotik in reinen Räumen
Am 8. Mai konnte Swiss Cleanroom Concept GmbH in Rheinfelden bei der Firma Kaiser Engineering AG erstmalig das Seminar «Robotik in reinen Räumen» durchführen. Das Thema stösst auf grosses Interesse. Der Trend ist klar ersichtlich: immer mehr kritische, vom Personal getätigte Arbeiten, die ein grosses Kontaminationsrisiko bergen, sollen neu mit dem Einsatz von Robotik reduziert werden.
Inhouse Schulung bei SKAN AG
Am 3. Mai 2019 durfte Swiss Cleanroom Concept GmbH den pharmazeutischen Dienst des Kinderspitals Zürich auf dem Gebiet „Richtiger Umgang mit CMR-Substanzen in der Aseptik“ im Rahmen einer Inhouse Schulung bei der Firma SKAN AG in Allschwil weiterbilden.
SKAN AG bietet hierfür ideale Schulungsräumlichkeiten mit vielen Laborgeräten und Sicherheitswerkbänken.
Reinräume Herausforderung "Bauen im Bestand"
Häufig handelt es sich beim Bau von Reinräumen um Erweiterungen oder Umbauten von bestehenden Gebäuden.
Das macht die Planung nicht einfacher – im Gegenteil: Bauen im Bestand erfordert eine fachübergreifende Planung und Erfahrung, um die Termine und die Kosten im Griff zu halten.
Rückblick auf das Basisseminar für Reinraummitarbeiter
Am 30. April fand in Rheinfelden das Basisseminar für Reinraummitarbeiter statt. Den 25 Teilnehmern wurden ein intensiver Einblick in den Reinraum und das proffessionelle Verhalten vermittelt.
Die Firma MBV war mit 3 Mitarbeitern dabei und Frau Corina Keller vermittelt ihnen kurz ihren Seminareindruck.
Wir suchen eine/n Senior Scientist Cleanroom
CSL Behring ist ein weltweit führendes Biotech-Unternehmen, das sich seinem Versprechen verpflichtet hat, Leben zu retten. In Bern entwickeln und vertreiben wir mit über 1500 Mitarbeitenden lebensrettende Therapien für Menschen mit schweren und seltenen Krankheiten weltweit.
16. Swiss Cleanroom Community Event
Am 8. April durften wir das 16. Swiss Cleanroom Community Event durchführen. Nahezu 200 Teilnehmer, die über 130 Firmen vertraten, folgten unserer Einladung.
Die tolle Stimmung und die vielen guten Gespräche hallen immer noch nach.
Luftauslass Partikelfilter für den MAS-100-NT
Der MAS-100 NT Luftkeimsammler der Firma MBV AG is spezifiziert für den Einsatz in Reinräumen der ISO Klasse 5 und GMP Grad A.
Konstruktion, Oberflächen und verbaute Komponenten sind von höchster Qualität und produzieren keine signifikanten Partikelmengen, welche die Umgebung kontaminieren.
Optimale Vermeidung von Barthaar
Optimale Vermeidung von «Barthaar» Kontamination in GMP und Reinräumen und dies ohne Beeinträchtigung des Wohlbefindens der Mitarbeiter
Immer mehr Männer tragen immer grössere Bärte!
Damit ist die Produktion in GMP und Reinräumen mit neuen Hygieneproblemen konfrontiert. Neue Hygienevorschriften fordern die bestmögliche Vermeidung von Haarkontamination. Der Haarschopf wird erfolgreich durch Hygienehauben geschützt, sodass eine optimale Vermeidung von Haarkontamination sichergestellt werden kann.
SCC Newsletter 1. Quartal 2019
Der Frühling erfreut uns mit Sonnenschein und zeigt sich schon in seiner Pracht.
Somit ist auch das 16. Swiss Cleanroom Community Event vom 8. April nicht mehr weit. Seien Sie gespannt auf die lehrreichen Referate und lassen Sie sich an den Ständen von unseren Ausstellern mit Ihrem vielfältigen Angebot überraschen. Wir freuen uns auf Ihren Besuch!
Proactive residue management for cleanrooms
Disinfectant residues impact many areas of the cleanroom. Additionally, increasing regulatory demands around residues mean life sciences cleanroom managers need to have a residue management strategy in place for their facilities
Geschäftsführungswechsel bei Enzler Reinigungen AG
Die Enzler Gruppe verfolgt mit vier Tochtergesellschaften die Strategie, Knowhow-Leader im Bereich Hygieneanwendungen und Reinigungen zu werden.
Mit 2700 Voll- und Teilzeitmitarbeitenden erwirtschaftet die Gruppe einen Umsatz von 100 Mio. SFr.
Nach 25 Jahren als Geschäftsführer der Enzler Reinigungen AG wird Karl Enzler seine...
Kennen Sie Ihre PDE Werte?
Am Seminar „Reinigungsvalidierung im GMP-Umfeld“ am 06.03.2019 in Rheinfelden behandeln wir unter anderem dieses Thema.
Wir haben noch 2 freie Seminarplätze.
Machen Sie Ihr Spital und Projektteam fit
Das Bundesgesetz über das elektronische Patientendossier (EPDG) verlangt, dass sich Gesundheitsfachpersonen in Spitälern bis 2020 und in Pflegeheimen bis 2022 am EPD beteiligen, indem sie sich einer Stammgemeinschaft anschliessen und alle behandlungsrelevanten Dokumente darin hochladen.
Robotergestützer Filterintegritätstest
Selbstständige Autos, autonome Staubsauger und Rasenmäher – Roboter vereinfachen unseren privaten Alltag. Auch in der Gesellschaft und Politik befasst man sich längst mit dem Thema.
Natürlich machen solche Entwicklungen nicht halt vor dem Reinraum. SKAN ist stets auf der Suche nach neuartigen Techniken und Lösungen, die für den Anwender eine Vereinfachung der Arbeitsprozesse bieten.
Optimale Reinigungs- und Desinfektionsergebnisse
Hygiene ist von höchster Wichtigkeit in pharmazeutischen Produktionsprozessen, in denen die Kontaminationskontrolle bei Oberflächen sowie Anlagen komplex ist und einen erheblichen Verbrauch von Ressourcen darstellen kann.
Die Produktreihe ClearKlens® von Diversey ist die effektivste Lösung, pharmazeutische Arbeitsabläufe und Effizienz zu beschleunigen, während die Abfallmenge und -kosten reduziert werden und leistet somit einen perfekten Beitrag zum Markenaufbau.
SCC Newsletter 4. Quartal 2018
Ein sehr heisses 2018 neigt sich dem Ende zu. Wir sind gespannt, was uns das neue Jahr alles beschert. Wird der neue Annex 1 erscheinen? In unserem Seminar GMP News 2019 erfahren Sie mehr darüber. Entdecken Sie jetzt im Newsletter, welche innovativen Lösungsansätze unsere Partner gefunden haben, wie sie bei ihren Kunden die Effizienz steigern konnten und in welche Richtungen expandiert wird.
Wir freuen uns, Ihnen heute wieder einen reichgefüllten Korb an Informationen überreichen zu dürfen, wünschen Ihnen viel Spass beim Lesen und einen guten Rutsch ins 2019.
Video zum 15. Swiss Cleanroom Community Event
Was für ein gelungener Anlass, das 15. Community Event vom 5. Nov. 2018! Nahezu 200 Personen aus der GMP- und Reinraumbranche trafen sich, um während der 9 Referate ihr Wissen auf den neuesten Stand zu bringen, an den 42 Ständen Antworten auf Fragen aus der Praxis zu erhalten und beim Apéro gemütlich ihr Netzwerk zu erweitern. Besonders eindrücklich war die positive, kollegiale, interessierte Stimmung. Überall waren lachende und zufriedene Gesichter zu sehen.
Qualifizierung und Validierung von Laborautoklaven
Wann müssen Sie als Betreiber Ihren Laborautoklaven Qualifizieren und einen Prozess Validieren? Was gibt es dabei zu beachten? Die Notwendigkeit einen Autoklaven zu qualifizieren und den Sterilisationsprozess zu validieren gehen unter Anderem aus dem Arzneimittelgesetz, dem Medizinproduktegesetz, dem Chemikaliengesetz, sowie der Biostoff- und Gentechnikschutzverordnung hervor.
Reinraum-Unterhaltsreinigung - just how?
Artikel #4
Was Sie bei der Implementierung der Reinraum-Unterhaltsreinigung beachten!
Im vierten Teil der Artikelserie erläutern wir die Implementierung der Reinraumreinigung, und somit die Umsetzung der Theorie in die Praxis.
Junior Account Manager für die Schweiz (m/w)
Initial Cleanrooms ist mit mehr als 35 Jahren Erfahrung im Dekontaminieren und Sterilisieren von Reinraum-Bekleidung der Markt- und Technologieführer für Reinraum-Mietlösungen in Europa.
Steigen auch Sie in unsere starke Mannschaft ein und bereichern Sie ab sofort unser Team als
Junior Account Manager für die Schweiz (m/w)
15. Swiss Cleanroom Community Event
Am 5. November durften wir das 15. Swiss Cleanroom Community Event durchführen. Nahezu 200 Teilnehmer, die über 130 Firmen vertraten, folgten unserer Einladung.
Die tolle Stimmung und die vielen guten Gespräche hallen immer noch nach.
VDI 2083 Blatt 19 - Kurzvorstellung
Dichtheit von Containments – Klassifizierung, Planung, Prüfung
Im August 2018 erscheint die endgültige Fassung bzw. der Weißdruck der neuen Richtlinie VDI 2083 Blatt 19. Hier ist - in diesem Umfang und Anwendungsbereich erstmalig - die Dichtheit von Containments beschrieben.
Seminar Umgang mit hochaktiven Substanzen bei SKAN
Hochaktive Substanzen in der pharmazeutischen Herstellung gewinnen immer mehr an Bedeutung. Bis zum Jahr 2022 wird jede zweite Substanz in der Bio – Pharmazeutischen Herstellung als hochaktiv eingestuft.
Dadurch gewinnt neben der aseptischen Herstellung der Produkte auch der Mitarbeiterschutz sowie die Anforderungen an Reinigung „Preventing Cross Contamination“ an Bedeutung.
GMP Sanierung & Aufstockung Roche Bau 41
Die Hoffmann-La Roche AG erweiterte an ihrem Hauptsitz in Basel den bestehenden Logistik- und Labor-Bau 41.
Die Energie-Ingenieure von Willers um Projektleiter Agron Asllani planten anspruchsvolle Klima- und Lüftungsanlagen und realisierten eine effiziente Energieversorgung für den GMP-qualifizierten Bau.
Welche Arbeitsdokumente erstelle ich für die Reinraum-Unterhaltsreinigung?
Im zweiten Teil der sechsteiligen Artikelserie «Reinraum-Unterhaltsreinigung – just how?» haben wir die qualitätssichernden Dokumente besprochen, die vor Beginn der Reinraum-Unterhaltsreinigung zu erstellen sind. Diese beruhen auf den Informationen des genehmigten Lastenheftes. Die weiteren Themen der Serie entnehmen Sie der Grafik am Ende des Artikels.
SCC Newsletter 3. Quartal 2018
Nach einem maximal sonnigen Sommer hält nun der Herbst mit goldenen Farben Einzug.
Während der letzten Monate hat sich unheimlich viel getan in der GMP- und Reinraum-Welt.
Entdecken Sie im Newsletter welche innovativen Lösungsansätze unsere Partner gefunden haben, wie sie bei Ihren Kunden die Effizienz steigern konnten, welche Jubiläen gefeiert werden und in welche Richtungen expandiert wird.
Wir freuen uns, Ihnen heute wieder einen reichgefüllten Informationskorb überreichen zu dürfen und wünschen Ihnen viel Spass beim Lesen.
Arbeitsstühle für reine Räume
DELTA erweitert sein Sortiment um Bimos Reinraumstühle. Diese werden in enger Kooperation mit Industrie und Forschung entwickelt und vom IPA Fraunhofer Institut auf ihre Reinraumtauglichkeit getestet und zertifiziert. Sämtliche Reinraumstühle bestehen aus versiegelten.
Polstern mit Hinterschäumtechnik, gekapselten Mechaniken sowie glatten, geschlossenen Flächen. Alle eingesetzten Materialien leiten elektrostatisch ab. Dies macht die Lösungen von Bimos zu Reinraummöbeln, die in der Praxis überzeugen.
Projektleiter für Hygiene und Reinräume gesucht!
Wir sind ein spezialisiertes Planungsbüro für Industriebauten.
Nicht nur unser konzeptioneller Ansatz unterscheidet uns von anderen Büros, auch dass das Unternehmen zu 100% den Mitarbeitenden gehört, macht uns anders.
Wir suchen Sie für die betriebliche Planung im Bereich der medizintechnischen, kosmetischen und pharmazeutischen Produktion.
Leistungsfähig unter Höchstbelastungen
Kautschukböden gewährleisten in den Reinräumen des Forschungszentrums CHyN erschütterungsfreies Arbeiten
Die Forschung mit allerkleinsten Teilchen erfordert allerhöchste Sorgfalt: In den Reinräumen...
Testo Industrial Services AG & Prozessvalidierung
DSM Nutritional Products AG vertraut auf Testo Industrial Services AG
bei Prozessvalidierung!
„Be sure“! – So kennt der Schweizer Markt den führenden Dienstleister für Qualitätssicherung Testo Industrial Services.
Reinraum Schuhe mit abnehmbarer Gamasche
Geeignetes Schuhwerk ist in vielen Produktionsbereichen ein wichtiger Bestandteil der persönlichen Schutzausrüstung.
Nicht nur der gute Tragekomfort ist hierbei wichtig, sondern dass die Schuhe die unterschiedlichen Voraussetzungen hinsichtlich der gewünschten Sicherheits- und Reinraumklasse entsprechen.
Ursachenanalyse mit dem Echtzeit-Luftkeimzähler BioTrak
Untersuchungen luftgetragener Keime in Reinräumen mittels herkömmlicher Techniken können bekanntlich keine definitive Grundursache identifizieren. Unabhängig vom Umfang der Untersuchung spielt bei der Identifizierung der oft schwer ermittelbaren Quelle, aufgrund der Beschränkungen der verfügbaren Werkzeuge, vor allem das Glück oft eine große Rolle.
Actemium LeitTec AG sucht Sie!
Für den Ausbau unseres Teams in der Business Unit Actemium LeitTec AG suchen wir in Wettingen oder Bern einen kompetenten und dienstleistungsorientierten Leittechniker/Steuerungstechniker.
Qualitätssichernde Dokumente für die Reinraumreinigung
Im ersten Teil der sechsteiligen Artikelserie «Reinraum-Unterhaltsreinigung – just how?» wurde die Ermittlung der Nutzeranforderungen, die Quellen für normative und gesetzliche Vorgaben und der Inhalt eines Lastenheftes für die ReinraumUnterhaltsreinigung besprochen. Die weiteren Themen der Serie finden Sie am Ende des Artikels.
Auszeichnung für TSI Facility Monitoring Software
TSI FMS Facility Monitoring Software ist jetzt OPC Foundation zertifiziert.
Um zertifiziert zu werden, hat das Produkt gründliche Funktions- und Leistungstests bestanden, um Endnutzern zu gewährleisten, dass das Produkt die Erwartungen hinsichtlich Compliance, Interoperabilität, Robustheit und Ressourceneffizienz erfüllt oder übertrifft.
Wie legt man die Basis für erfolgreiche Reinraumreinigung?
Eines vorweg - die grundlegenden Anforderungen an die Reinheit werden von Beginn an in das Reinraum-Konzept integriert, die Reinheit somit in die Reinraum-Anlage «eingebaut».
Das erfordert, dass die Reinheitsanforderungen bereits zu Beginn des Projektes bekannt sind und Eingang in die Reinraumplanung finden.
Berater (m/w) Qualitätssicherung Pharma / GMP
Genieß den Freiraum, beratungsintensive Projekte in Eigenregie abzuwickeln.
Die Weiterentwicklung Deiner Fachthemen treibst Du durch Deine eigenen Ideen voran.
Als Know-how-Träger hast Du Freude daran, Wissen weiterzugeben,
Expertise in Fachkreisen zur Verfügung zu stellen und Deine Reputation zu stärken.
SCC Newsletter 2. Quartal 2018
Wir sind schon fast wieder in der 2. Jahreshälfte angekommen. Haben Sie
auch das Gefühl, dass sich das Rad der Zeit immer schneller dreht?
Ich denke, es sind vielmehr die neuen Möglichkeiten zu kommunizieren
und die sich rascher verändernden Anforderungen an z.B. die Herstellung
von Arzneimitteln, die uns dies so erscheinen lassen.
Überwachungssystem viewLinc von Vaisala
Die Entwicklung von Medikamenten ist ein zeitintensiver und kostspieliger Prozess mit hohem Misserfolgsrisiko – vor allem in den frühen Phasen.
Die gesamte Medikamentenentwicklung steht unter den Richtlinien der „Guten Klinischen Praxis“ („Good Clinical Practice“, GCP).
Der internationale, ethische und wissenschaftliche Standard regelt die Planung, Durchführung, Dokumentation und Berichterstattung klinischer Prüfungen am Menschen.
Neues Impfstoff und Forschungszentrum Bioveta
Das neue Gebäude wurde für die Forschung an antiviralen Produkten und zur Impfstoffherstellung gebaut.
Das Gebäude wurde mit state of the art Ausstattung nach den neuesten GMP Regularien erstellt.
Großer Wert wurde auch auf eine angenehme Arbeitsathmosphäre gelegt.
SAMSON übernimmt SED
Seit dem 7. September 2017 gehört der Ventilspezialist SED Flow Control GmbH aus Bad Rappenau zu SAMSON.
Durch die Übernahme erweitert SAMSON seine Produktpalette um Ventile für die Märkte Pharma- und Biotechnologie sowie Lebensmittel und Getränke.
Staubbindematten optimal einsetzen
Der Einsatz von Staubbindematten an Eingängen und Schleusen zu kritischen Bereichen minimiert den Eintrag von Schmutz, Staub und Partikeln durch Mitarbeiter, Besucher und Transportgeräte.
Die klebende Oberfläche der Staubbindematte nimmt den Schmutz von Schuhsohlen und Wagenrädern auf und gibt ihn nicht wieder ab.
14. Swiss Cleanroom Community Event
Das 14. Swiss Cleanroom Community Event vom 16. April war mit über 180 Teilnehmern wieder sehr gut besucht.
Mehr als 40 Aussteller präsentierten sich. Neu wurde mit einem Expertenreferat und 8 Kurzreferaten die Community über Trends und Neuigkeiten informiert.
Swiss Cleanroom Concept hat neu über 100 SCC-Partner!
Über 100 SCC-Partner profitieren.
Kommen auch Sie hinzu!
Werden auch Sie SCC-Partner und kommen Sie in den Genuss unseres professionellen, persönlichen und preisgünstigen Angebots.
CRT Cleanroom-Technology AG wird Climet® Partner
Die CRT Cleanroom-Technology AG wird autorisierter Climet® Partner für Vertrieb und Kalibrierung von Partikelzählern in der Schweiz.
Nach zweijähriger erfolgreicher Zusammenarbeit der CRT Group als Vertriebs- und Kalibrierpartner für den traditionsreichen US-amerikanischen Messgeräte-Hersteller Climet® Instruments für die Regionen Deutschland, Österreich und Tschechien wird die Partnerschaft nun erweitert...
SCC Newsletter 1. Quartal 2018
Mit Rückenwind aus 2017 heissen wir Sie herzlich willkommen zum
1. Newsletter 2018!
Hier zeigen wir Ihnen noch einmal in Kürze, was sich in der GMP- & Reinraum Branche im letzten Quartal ereignet hat und wohin die Reise führt…
Wir suchen Objektleiter/in GMP- Reinraumreinigung 100%
Wir suchen eine Persönlichkeit vorzugsweise mit abgeschlossener technischer Ausbildung und Erfahrung in der GMP- und Reinraum- Reinigung. Zudem verfügen Sie über eine Weiterbildung in der Gebäudereinigung oder einige Jahre Berufserfahrung in ähnlicher Funktion. Führungserfahrung und ein ausgeprägter Sinn für Organisation sind neben Durchsetzungsvermögen, Sozialkompetenz und guten kommunikativen Fähigkeiten ebenso gefragt wie die Bereitschaft für flexible Arbeitszeiten. Sie arbeiten selbständig, speditiv und absolut zuverlässig.
Reinraum-Monitoring 4.0
Industrie 4.0 oder auch Digitalisierung 4.0 ist seit einiger Zeit ein vieldiskutiertes Thema in der Presse, in Vorträgen aber auch Unternehmen.
Es werden Projektgruppen gebildet um zu erarbeiten, wie sich Unternehmen dieser Herausforderung stellen können, um sich letztlich den „digitalen Nutzen“ zu eigen zu machen.
Gebäudeautomation im regulierten Umfeld
Die zentrale übergreifende Gebäudemanagementplattform Desigo CC erfüllt auch im regulierten Umfeld alle Anforderungen.
Reinräume, Labors und pharmazeutische Produktionsanlagen sowie kritische Lager werden unterstützt.
Desigo CC gelingt es den Spagat zwischen Effizienz und Sicherheit zu meistern.
Erfolgreiche Akkreditierung als Prüflabor für Reinraum-‎Qualifizierungsmessungen
Durch die Akkreditierung nach ISO/IEC 17025 als Prüflabor wurde die Kompetenz der Testo Industrial Services für Prüfungen im Bereich der Qualifizierung von Reinräumen bestätigt.
Die hochwertigen, metrologisch rückführbaren Prüfergebnisse wird durch qualifiziertes, branchenerfahrenes Personal und dem Einsatz des professionellen Messmittelparks sichergestellt.
Intensivseminar für Reinraum Quereinsteiger
Sie arbeiten neu im Reinraum oder sind neu für Reinraumbelange verantwortlich. Sie möchten Ihr Verständnis für diesen Bereich erhöhen. Grundkenntnisse und die Zusammenhänge verstehen.
Dann sind Sie am Intensivseminar für Reinraum Quereinsteiger richtig! Buchen Sie jetzt noch für den 24. und 25. Januar einen der letzten freien Plätze.
Novasina AG wünscht Ihnen Merry X-Mas
Sehr geehrte Kunden
Ein herausforderndes, interessantes und erfolgreiches Jahr neigt sich dem Ende zu. Wir von Novasina bedanken uns herzlich für Ihr Vertrauen im Jahr 2017 und wünschen Ihnen eine wunderbare Weihnachtszeit, glückliche Momente mit Ihrer Familie und Ihren Freunden sowie einen guten Start ins Jahr 2018. Anstatt nur eine "Merry Christmas e-card" zu verschicken, haben wir für Sie unsere persönlichen, recht lustigen Weihnachtsgrüße kreiert!
CLICK HERE!
Neu: desmanol® pure gel
Die Frage, ob ein flüssiges oder gelartiges Händedesinfektionsmittel zum Einsatz kommt, lässt sich pauschal nicht beantworten.
Um der Individualität und den persönlichen Vorlieben der Anwender/innen gerecht zu werden, führt schülke nun auch desmanol® pure Gel im Sortiment.
Es ist essenziell, über ausreichend Hygienewissen zu verfügen
Grundlegende Hygienemassnahmen, wie z. B. eine ordnungsgemässe Händereinigung und -desinfektion sind essentielle Bedingungen für einen sicheren Umgang mit Medizinprodukten. Durch die Tatsache, dass Hygiene bzw. richtiges und korrektes hygienisches Verhalten jeden betrifft, ist es essenziell, dass ausreichendes Wissen darüber verfügbar ist. In einer Praxis ist die Verantwortung für den hygienisch einwandfreien Betrieb einem Hygieneverantwortlichen zu übertragen.
Biohazardous Waste Decontamination in an Autoclave
Pharmaceutical and biotechnology manufacturing, laboratory and research facilities are required to decontaminate biological waste prior to disposal. In most cases, autoclaves (also referred to as steam sterilizers) are utilized to accomplish this task.
This article is meant to provide guidance and recommendations to ensure optimal and reliable performance of the decontamination process using autoclave steam sterilizers.
Hygiene in der Arztpraxis
Dem Wissen um grundlegende Hygienemassnahmen stehen mittlerweile hochkomplexe Prozesse im Umgang mit Medizinprodukten, oder immer neue Entwicklungen bei Mikroorganismen gegenüber. Insbesondere antibiotikaresistente Bakterien stellen uns vor enorme Herausforderungen.
nora überzeugt im Testverfahren für Reinräume
Biotest AG entscheidet sich beim Neubau ihres Produktionsgebäudes nach wissenschaftlicher Evaluation für Bodensysteme von nora systems. Weinheim, August 2017 – Werkstoffauswahl nach wissenschaftlich messbaren Kriterien – bei der Entscheidung über den Boden für ihr neues Produktionsgebäude Biotest Next Level (BNL) ist die Biotest AG in Dreieich ganz neue Wege gegangen.
Luft - sonst nichts
Ein neuer Auftritt für MBV
Mit dem Claim «Luft – sonst nichts.» unterstreicht die Firma MBV als Weltmarktführerin im mikrobiologischen Luftmonitoring ihren Fokus und Ambition.
Mit einem neuen inhaltlichen und visuellen Auftritt präsentieren wir uns ab sofort moderner und frischer.
Biohazardous Waste Decontamination in an Autoclave
Pharmaceutical and biotechnology manufacturing, laboratory and research facilities are required to decontaminate biological waste prior to disposal. In most cases, autoclaves (also referred to as steam sterilizers) are utilized to accomplish this task. This article is meant to provide guidance and recommendations to ensure optimal and reliable performance of the decontamination process using autoclave steam sterilizers.
Steam Sterilization: A Commentary on Air Removal and Verification
The presence of air in an autoclave sterilization cycle can adversely affect steam penetration and contact with materials being sterilized. It is best practice to perform daily air removal verification testing following the sterilizer manufacturer’s guidelines...
13. Swiss Cleanroom Community Event
Mit 180 Teilnehmern, die über 130 Firmen vertraten, konnte das 13. Swiss Cleanroom Community Event am 6. November die Besucherzahl um 20% steigern. Die Gäste informierten sich über die neuesten Entwicklungen in der Reinraumtechnologie.
36 Firmen gestalteten den Event mit informativen Ausstellerständen und interessanten Referaten.
Der gemütliche Apéro bot genügend Raum, um mit potenziellen Geschäftspartnern oder alten Bekannten ins Gespräch zu kommen.
SCC Newsletter 4. Quartal 2017
Mit Freude blicken wir auf einen schönen Sommer und ein erfolgreiches und intensives 1. Halbjahr zurück.
Für das 2. Semester haben wir für Sie mehr als 20 spannende, praxisorientierte Seminare zu aktuellen Themen in unserem Angebot. Hier geht es zur Seminarübersicht…
Speziell freut uns, dass die Frage nach Inhouse Schulungen stark gestiegen ist. Hier kommen Sie zu unserem vorgefertigten Inhouse Angebot.
Gerne stellen wir auch individuelle Inhouse Angebote zusammen.
Save the date 13. Swiss Cleanroom Community Event
Am Montag, 06. November 2017 trifft sich die Cleanroom Community in Pratteln!
Über 40 Firmen werden sich an diesem Event mit Kleinmesse-Charakter vorstellen. Bleiben Sie am Ball und erfahren Sie viel Wissenswertes über News, Trends, neue Produkte oder Leistungen in den 8 Kurzreferaten.
Wir erwarten wieder über 150 Teilnehmer. Die Besucher werden mit einem Imbiss und Getränken, wie gewohnt kostenlos, bewirtet.
Melden Sie sich jetzt kostelos an...
Profitieren Sie jetzt als SCC-Partner!
In unserer schnelllebigen Zeit ist es schwierig, den richtigen Ansprechpartner zu finden für die Produkte oder Dienstleistungen, die Sie verkaufen möchten. Mitarbeiter wechseln schneller die Stelle als früher. Unternehmensabteilungen werden öfter umstrukturiert.
Die Anbieter-Kunden Beziehung aufrecht zu erhalten, ist für beide Seiten eine grosse Herausforderung.
Die Lösung ist, Anbieter und Kunden zusammen zu bringen. Wie aber kann ein Kunde seine täglichen und/oder projektbezogenen Aufgaben schnell, effizient und kostengünstig erledigen?
Novasina AG sucht Sie!
Novasina AG, ein dynamisches Unternehmen mit Sitz in Lachen SZ, entwickelt, produziert und vertreibt hochwertige Messinstrumente für die Klimaindustrie sowie für die Qualitätssicherung und Entwicklung in der Pharma- und Lebensmittelindustrie.
Um unsere Leaderposition weiter auszubauen suchen wir für die Abteilung Verkauf & Marketing eine dynamische und kommunikative Persönlichkeit, die gerne im Team wie auch selbständig tätig ist als
Technische(n) Verkaufsberater(in) im Aussendienst
für unsere Feuchte-, Temperatur- und Druckmessgeräte
Die CRT Cleanroom-Technology AG sucht Sie!
Die CRT Cleanroom-Technology AG bietet Dienstleistungen für Betreiber von Reinräumen und Lieferanten der dort eingesetzten Technologien. Für unsere Kunden übernehmen wir Mess- und Instandhaltungsarbeiten, in deren Reinräumen, reinen Bereichen sowie in deren Lüftungstechnik.
Für den weiteren Ausbau des Schweizer Markts, suchen wir zum nächstmöglichen Zeitpunkt einen Servicetechniker / Messtechniker (m/w)
SCC Newsletter 3. Quartal 2017
Mit Freude blicken wir auf ein erfolgreiches und intensives 1. Halbjahr zurück. Für das 2. Semester haben wir für Sie mehr als 20 spannende, praxisorientierte Seminare zu aktuellen Themen in unserem Angebot.
Speziell freut uns, dass die Frage nach Inhouse Schulungen stark gestiegen ist. Lesen Sie auf Seite 22 den Bericht über unsere erfolgreiche Schulung in der Firma Padma AG in Wetzikon.
Wir wünschen Ihnen nun viel Spass beim Lesen der News und Trends unserer SCC Partner und einen schönen Sommer.
Ihr Swiss Cleanroom Concept Team Andrea und Frank Zimmermann
MILS das neue innovativen Reinraumbeleuchtungssystem
Die LUXIONA Group hat auf der Fachmesse Middle East Dubai zum ersten Mal das innovative M.I.L.S. (Medical Intelligent Lighting System) präsentiert.
Dabei handelt es sich um ein intelligentes System für Operationssäle, bei dem durch motorisierte LED Deckeneinbauleuchten das Licht punktgenau auf den jeweiligen Arbeitsbereich gelenkt werden kann.
Sysmex Suisse AG sucht Sie!
Für unsere Abteilung Safety Concepts suchen wir eine dynamische
und motivierte Persönlichkeit als
Techniker oder Technikerin für Laminar Flow-
und Isolatorenanlagen im Aussendienst (100%)
RMS - ROTRONIC MONITORING SYSTEM
Höchste Qualitätsansprüche in Forschung und Entwicklung, Produktion und Lagerung verlangen nach einem kontinuierlichen Überwachungssystem, das verschiedenste Messdaten zuverlässig zur Verfügung stellt. Das adaptive Rotronic Monitoring System RMS ist die perfekte Lösung für unterschiedlichste Anwendungen.
Unsere Produkte inklusive Software sind FDA-konform, werden nach GAMP5 Richtlinien entwickelt und sind validierbar.
NEU BEI STERIS - Laboratory Testing Services
STERIS Laboratories ist ein globaler Anbieter von Labortests und Validierungsdiensten für die Medizin- und Pharmaindustrie.
Durch ein Netzwerk von Laboratorien in Europa, Asien, Afrika und Nordamerika unterstützen wir unsere Kunden auf globaler und lokaler Ebene.
Wir bieten eine breite Palette an mikrobiologischen und analytischen Labortests an und verfügen...
CSV-Anforderungen der Life Science Industrie
Serviceausbau bei M+W Central Europe GmbH
Die CSV-Anforderungen der Life Science Industrie sind komplex, daher erwarten Kunden von einem kompetenten Partner sowohl umfassende Leistungen als auch Services zu speziellen, hochaktuellen CSV-Herausforderungen.
Druck messen ganz einfach…
Der Druck-Kalibrator TM40 ist in seiner Konzeption einzigartig.
Das Gerät ist komplett modular aufgebaut. Es stehen vier Einschub- Slots zur Verfügung, welche mit unterschiedlichen Modulen bestückt werden können. Der TM40 kann somit individuell auf seinen jeweiligen Einsatzzweck angepasst werden.
Willers - Reinraumtechnik hoch im Kurs
Für Pharmaindustrie, Labors und Spitäler ist die Reinheit von Produktionsbereichen, sterilen Werkbänken oder Operationssälen von grösster Bedeutung.
Die Reinraumtechnik gewährleistet die Einhaltung dieser spezifischen Anforderung. Der Bedarf an Reinräumen steigt stark an.
Davon profitieren nicht zuletzt die auf diese Branche spezialisierten Planungsbüros.
12. Swiss Cleanroom Community Event
Über 150 Teilnehmer am 12. Swiss Cleanroom Community Event am 03. April informierten sich über die neueste Entwicklungen in der Reinraumtechnologie. 36 Firmen gestalteten den Event mit informativen Ausstellerständen und interessanten Referaten.
Der gemütliche Apéro bot genügend Raum, um mit potenziellen Geschäftspartnern oder alten Bekannten ins Gespräch zu kommen.
SCC Newsletter 1. Quartal 2017
Der Frühling meldet sich zurück, die Temperaturen steigen wieder.
Wir freuen uns, Ihnen in unserem Newsletter des 1. Quartals wieder eine Fülle an Trends und Informationen von unseren SCC Partnern bieten zu können.
Im zurückliegenden Quartal konnten wir bereits über 200 Teilnehmer in unseren Seminaren und Inhouse Trainings schulen.
Wir wünschen Ihnen viel Spass beim Lesen, einen guten Start in den Frühling und ein buntes Osterfest.
Regulatorische Anforderungen in der Krankenhausapotheke
Aus der Praxis des Kantonsspitals in der Ostschweiz
Projektbericht
Regulatorische Anforderungen in der Krankenhausapotheke wurden durch ganzheitliches Reinraum Monitoring erfüllt. Folgender Artikel beschreibt die Umsetzung.
Die Spitalapotheke St. Gallen ist für die Versorgung der Kliniken und Institute der Spitalregion St. Gallen mit Arzneimitteln, Reagenzien, Chemikalien und Desinfektionsmitteln zuständig.
Kontaminationskontrolle mit weniger mehr erreichen
Erfahren Sie, wie Sie bei der Kontaminationskontrolle mit weniger mehr erreichen – mit der neuen Klercide PSS
Angesichts des zunehmenden Kostendrucks und den immer strengeren Compliance-Anforderungen ist die Pharmaindustrie darauf angewiesen, Kosten zu reduzieren, ohne dabei jedoch ihre Standards
zu senken. Das Klercide PSS-System erlaubt eine optimale Kontrolle Ihres Reinraums in sowohl großflächigen als auch schwer erreichbaren Bereichen und reduziert gleichzeitig die Bearbeitungszeit.
Von der Werkshalle bis zum Reinraum
Widerstandfähige Allrounder
Kautschukböden punkten in der Industrie
Die Anforderungen an Industrieböden sind extrem hoch: Sicherheit für hochentwickelte technische Geräte, äußerste Verschleißfestigkeit, Beständigkeit gegen Chemikalien, optimales Reinigungsverhalten, Ergonomie für die Mitarbeiter und vieles mehr. Gefragt sind in diesem anspruchsvollen Markt also besonders leistungsfähige Produkte wie die Kautschuk-Bodenbeläge von nora systems.
Dieter Conzelmann neuer Geschäftsführer bei Bizerba Busch
Dieter Conzelmann hat ab dem 1. Januar 2017 die Geschäftsführung der Bizerba Busch AG von Heinz Busch übernommen. Heinz Busch hat das Unternehmen im gegenseitigen Einvernehmen verlassen.
Dieter Conzelmann verfügt über langjährige und fundierte Branchenerfahrung. Der Diplom-Ingenieur und Master of Business Administration verantwortete seit dem Jahr 2000 als Director Industry Solutions den internationalen Geschäftsbereich industrielle Wäge-, Auszeichnungs- und Inspektionstechnik sowie Software bei Bizerba.
Intensivseminar für Reinraum Quereinsteiger
Sie arbeiten neu im Reinraum oder sind neu für Reinraumbelange verantwortlich.
Sie möchten Ihr Verständnis für diesen Bereich erhöhen. Grundkenntnisse und die Zusammenhänge verstehen.
Dann sind Sie in diesem Seminar richtig!
Kommen Sie am 24. und 25. Januar 2017 zu uns auf Rheinfelden zum Intensivseminar für Reinraum Quereinsteiger.
SCC Newsletter 4. Quartal 2016
Zuerst bedanken wir uns ganz herzlich für Ihr Interesse an unseren GMP Dienstleistungen und Seminaren sowie die gute Zusammenarbeit und freuen uns, auch im neuen Jahr mit Ihnen in Kontakt zu stehen.
Für 2017 wünschen wir Ihnen viel Erfolg, spannende Projekte und kreative Antworten auf die anstehenden Herausforderungen.
Bevor wir das neue Jahr schwungvoll starten, möchten wir Sie mit diesem Newsletter über Neuheiten und innovative Lösungen zu aktuellen Fragestellungen unserer Reinraumpartner informieren.
Mehr als 90 Jahre Miele AG Professional
Seit mehr als 90 Jahren bilden gewerblich eingesetzte Produkte eine weitere Erfolgsgrundlage der Miele & Cie. KG.
Waren es zu Beginn der Entwicklung grosse Waschmaschinen, kamen später Geschirrspüler und seit den 1960er Jahren die Medizinprodukte hinzu.
Seit dem Jahr 2000 hat sich Miele Professional vom reinen Produkthersteller hin zum Systemanbieter für gewerbliche Lösungen entwickelt.
Professionelle Reinigungsgeräte und top Fördertechniken
Seit über 100 Jahren engagiert sich Nilfisk weltweit für Sauberkeit und wird den sich ständig ändernden Bedürfnissen der Märkte und Kunden mit innovativen Produkten und Lösungen gerecht.
Die Industriesauger, pneumatischen Förderanlagen und Boden- pflegemaschinen erhöhen die Hygiene und Sicherheit, sowohl in pharmazeutischen Reinräumen wie auch in Produktionsstätten.
Das weltweit schnellste und genauste Laborlüftungssystem
Phoenix
Das weltweit erfolgreichste, schnellste und genauste Laborlüftungssystem.
Traccel für Forschungs-, Labor- und Reinräume.
Ideal für Räume mit variablen Luftvolumenströmen (VAV), in denen es wichtig ist, eine positive oder negative Luftmengenbilanz einzuhalten.
11. Swiss Cleanroom Community Event
Auf reges Interesse in der Reinraumbranche stiess die 11. Ausführung des Swiss Cleanroom Community Events am 24. Oktober Im Hotel Marriott in Pratteln fanden sich über 130 Teilnehmer ein, um sich über neueste Entwicklungen in der Reinraumtechnologie zu informieren. 30 Firmen gestalteten den Event mit informativen Ausstellerständen und interessanten Referaten. Der gemütliche Networking-Apéro bot genügend Raum, um mit potenziellen Geschäftspartnern oder alten Bekannten ins Gespräch zu kommen.
150 Anmeldungen zum 11. Swiss Cleanroom Community Event
Melden sie sich jetzt noch an!
Besuchen Sie uns
am 11. Swiss Cleanroom Community Event
vom 24. Oktober 2016 in Pratteln
und verschaffen Sie sich in gediegener Atmosphäre einen Überblick über aktuelle Themen und Innovationen im Reinraum- und GMP-Bereich.
Hier erfahren Sie mehr und können sich gleich kostenlos anmelden.
SCC Newsletter 3. Quartal 2016
Unsere SCC Partner waren überaus fleissig. Lassen Sie sich von der Fülle an Innovationen überraschen und stöbern Sie in unserem Newsletter.
Wir wünschen Ihnen einen schönen Herbst.
Ihr Swiss Cleanroom Concept Team
Andrea und Frank Zimmermann
GMP-konforme Arzneimittelherstellung in Krankenhäusern
Von der Layout-Findung bis zur Behördenabnahme.
Die Arzneimittelherstellung in Krankenhäusern, besonders auch an Universitätskliniken, wird heutzutage zunehmend so eingestuft wie die in Pharmaindustriebetrieben. Dies wird auch durch das erst kürzlich im Oktober 2015 in Kraft getretene Supplement 11.2 zur Schweizerischen Pharmakopöe untermauert. Die Pharmakopöe Helvetica 11 wird von der Swissmedic, dem Schweizerischen Heilmittelinstitut, in Anlehnung an EU PIC/S herausgegeben, welches die reguläre GMP-konforme Sterilproduktion in der Schweiz beaufsichtigt.
Änderungen der ISO-Norm 14644 für Reinräume
Die Änderungen der ISO-Norm 14644 für EU-GMP, PICS und USA cGMP wirken sich sowohl auf Reinraumqualifikation wie auch auf Luftpartikelzähler die für die tägliche Routineüberwachung eingesetzt werden aus.
Beckman Coulter Experten beraten die technischen ISO-Komitees um die Reinraumstandards neu zu definieren.
Sichern Sie sich jetzt noch einen Seminarplatz
Wir haben an unseren beiden Seminaren im September noch freie Seminarplätze. Sichern Sie sich jetzt noch einen Platz.
14. September GMP Aufbauwissen
Mehr erfahren...
und
15. September Anforderungen an die Dampfsterilisation
Mehr erfahren...
Wir freuen uns auf Sie!
PM1 - Feinstaub ist eine Gefahr für die Gesundheit
Die Luftverschmutzung ist weltweit für jährlich 5.5 Millionen vorzeitige Todesfälle verantwortlich.
Insbesondere fallen unsere Lungen dem PM1-Partikel zum Opfer.
Sind diese einmal eingeatmet, gelangen die Partikel in die tiefsten Bereiche der Lunge.
Übersichtlich und flexibles Informationsdisplay
Das Briem Informationsdisplay ermöglicht es Ihnen Monitoring Messwerte gebündelt, dezentral darzustellen. Verschiedene Messwerte aus dem Ganzheitlichen Reinraum Monitoring System können auf einer Übersichtsseite angezeigt werden.
Dadurch entstehen Informationszentralen, an denen sich die Mitarbeiter im Reinraum effizient über die Umgebungsparameter informieren können. So können z.B. die sieben Kühlschranktemperaturen einer Vorbereitung auf einem Display angezeigt werden.
Sauter Building Control Schweiz AG ist neuer SCC-Partner
Im Bereich der Life Sciences bieten wir unseren Kunden aus Industrien wie Pharma, Chemie, Healthcare, Food & Beverages sowie Bildung das Know-how für den Betrieb und die Überwachung spezieller Bereiche in ihren Gebäuden an.
Überall dort, wo besondere Raumkonditionen für Forschung und Entwicklung empfindlicher Produkte oder deren Produktion und Lagerung benötigt werden – oder wo besondere gesetzliche Vorgaben greifen –, finden sich spezialisierte Lösungen z.B. zur Laborabzugs- regelung, Raumdruckregelung oder Laborbelüftung von SAUTER.
LogicAir ist neuer SCC-Partner
LogicAir, ein innovatives Schweizer KMU Unternehmen mit Sitz in Saint-Aubin, wir sind ihr idealer Partner für Expertise in Engineering, Realisierung und Qualifizierung ihrer hohen Anforderungen an Reinräume.
Wir liefern seit 1996 schlüsselfertige, elegante Lösungen auf Kundenwunsch im Kleinst- und Grossformat in sämtlichen Reinheitsklassen (ISO-1 bis ISO-9, GMP A bis D).
HUBER INSTRUMENTE AG ist neuer SCC-Partner
HUBER INSTRUMENTE AG steht Ihnen mit seiner 40 jährigen Erfahrung im Bereich „Druck“,mit Rat und Tat in folgenden Bereichen zur Seite.
Wir bieten Ihnen Hand-Manometer, Mobile-Meteo-Stationen, Drucksensoren zur Festinstallation, Druck-Primär- / Referenz-Standards, Druck-Kalibratoren, SCS- und ISO-Kalibrier-Zertifikate, Laboreinrichtungen sowie Beratung und Schulung in den Bereichen Kalibrierung und Qualitäts-Management.
Die CAS Clean-Air-Service AG sucht Sie!
Die CAS Clean-Air-Service AG ist ein führender Dienstleister im Bereich Reinraummesstechnik mit Hauptsitz in Wattwil (SG) sowie Niederlassungen in Österreich und Deutschland.
Ausserdem sind wir Fachspezialisten für die Qualifizierung thermischer Prozesse.
Zur Ergänzung unseres Teams in Stein (AG) suchen wir per sofort...
Nachweis von Sauerstoff mittels Laser Headspace
Haben Sie auch Produkte in Ihrem Portfolio, bei denen die Verpackung ein kritischer Faktor ist? Zur Prüfung der Containerintegrität steriler Produkte bieten wir Ihnen bei der Labor L+S AG dafür nun die Laser-Headspace-Technologie an. Die Kapitel der United States Pharmacopeia (USP) mit 1000er-Nummern haben bekanntlich keinen bindenden Charakter, sie sind vielmehr als Guidelines zu verstehen. Im Rahmen dieser Richtlinien ist der gegenwärtige Stand der Technik aus Sicht der privaten Organisation USP zu verschiedenen Themen der pharmazeutischen Qualitätskontrolle dargestellt.
Reinraum Engineering für Pharma, Labore und Spitäler
Für Pharmaindustrie, Labore und Spitäler ist die Reinheit von Produktionsbereichen, sterilen Werkbänken oder Operationssälen von grösster Bedeutung. Die Reinheit bestimmt zu einem wesentlichen Anteil die Qualität der dort geleisteten Arbeit. Durch die Regulierung der Gesundheitsbehörden wird sichergestellt, dass beispielsweise die Anforderungen an die Produktion von Medikamenten unabhängig von Hersteller und Produktionsstandort identisch sind.
Reinigungsvalidierung &Toxikologie: Quo vadis?
Ein kleiner Wegweiser im Dickicht der toxikologischen Anforderungen aus dem neuen Annex 15 des EU GMP Leitfadens.
Der neue Annex 15 bringt nicht nur Neuerungen und Klarstellungen für Qualifizierungen von Geräten und Anlagen sowie Prozess- validierungen, sondern auch einige neue, nicht zu unterschätzende Anforderungen bei der Reinigungsvalidierung.
SCC Newsletter 2. Quartal 2016
Seit dem letzten Newsletter hat sich einiges getan. Neue Homepage und für das 2. Halbjahr 2016 haben wir einige Seminare mit neuen Themen für Sie zusammengestellt. Neu bieten wir auch Seminare in Deutschland an.
Ob das Thema, auf das Sie schon lange gewartet haben, dabei ist, erfahren Sie hier...
Auch unsere SCC Partner waren überaus fleissig. Lassen Sie sich von der Fülle an Innovationen überraschen und stöbern Sie in unserem Newsletter.
Luftreiniger City M sorgt für Wohlbefinden
Schlechtes Raumklima macht krank
Wenn man im Büro vor dem Bildschirm oder in der Schule im Klassenzimmer sitzt, sich nicht mehr konzentrieren kann und vielleicht auch schon der Kopf wehtut, dann ist oftmals die Luft im Raum Schuld. Viele Belastungen für das Raumklima entstehen durch die anwesenden Menschen und Tiere, durch Schadstoffausdünstungen von Wänden, Böden und Möbeln.
Industrie 4.0: Chancen, Herausforderungen und Grenzen
Mit Industrie 4.0 werden intelligente, vernetzte Systeme in die industrielle Produktion eingeführt. Kostengünstige, robuste Sensoren, effiziente Mikroprozessoren und leistungsfähige Protokolle zum Datenaustausch ermöglichen intelligente Anlageelemente. Diese können eigene Entscheidungen treffen, im Verbund kommunizieren, sowie Prozesse optimieren. Sie überwachen ihre eigene Funktionsfähigkeit und helfen die Ausschussquote zu reduzieren.
Mikrobiologische Abweichungen verstehen
Bei mikrobiologischen Abweichungen im Monitoring in der Pharma-, der Medizintechnik und der Biotechnik-Produktion wird von Mitarbeitern und im speziellen von Führungskräften erwartet, dass Sie diese Abweichung adäquat bewerten können.
Der Einfluss auf das produzierte Produkt muss rechtzeitig erkannt werden, so dass die Qualität erhalten bleibt und keine Fehlchargen produziert werden oder sogar der Patient gefährdet wird.
Gebrauchsfertige Vials für die Abfüllung steriler Arzneimittel
Entpyrogenisierte und sterilisierte Klarglasfläschchen.
Pall Life Sciences stellt seine Pyrofree Vials für die Abfüllung steriler Flüssigarzneimittel vor.
Die Klarglasfläschchen vereinfachen den Abfüllprozess in der biotechnologischen und der pharmazeutischen Produktion, in der Impfstoffherstellung und in Krankenhäusern.
10. Swiss Cleanroom Community Event
Auf reges Interesse in der Reinraumbranche stiess die 10. Ausführung des Swiss Cleanroom Community Events am 14. April. Im Hotel Marriott in Pratteln fanden sich über 130 Teilnehmer ein, um sich über neueste Entwicklungen in der Reinraumtechnologie zu informieren. 25 Firmen gestalteten den Event mit informativen Ausstellerständen und interessanten Referaten. Der gemütliche Networking-Apéro bot genügend Raum, um mit potenziellen Geschäftspartnern oder alten Bekannten ins Gespräch zu kommen.
CONNECTORS Verbindungstechnik AG ist neuer SCC-Partner
Führend in steriler Verbindungstechnik für die Pharma- & Biotech-Industrie
Als innovative Mitdenker, Planer und Partner befassen wir uns intensive mit den spezifischen Anforderungen unserer Kunden. Durch ständige Produktentwicklung, die auf entstandenen Bedürfnissen basiert, sind wir in der Lage, die bestmöglichen und wirtschaftlichsten Lösungen anzubieten.
Bardusch GmbH & Co. KG ist neuer SCC-Partner
Von der Beschaffung der Textilien über die speziellen Wasch- und Dekontaminationsprozesse bis zum Transport übernehmen wir das gesamte Bekleidungsmanagement. Die Reinigung der sensiblen Kleidung ist die Königsdisziplin der Textilpflege. Unser Qualitätsmanagement bietet eine zertifizierte und qualitätsgeprüfte Reinigung und Dekontamination nach ISO-Klassifizierung DIN EN 9001 und 14001.
SCC Newsletter 1. Quartal 2016
Der Frühling meldet sich zurück, die Temperaturen steigen wieder.
Wir freuen uns, Ihnen in unserem Newsletter des 1. Quartals wieder eine Fülle an Trends und Informationen bieten zu können. Im zurück liegenden Quartal konnten wir bereits über 250 Teilnehmer in unseren Seminaren und Inhouse Trainings schulen.
Wir wünschen Ihnen viel Spass beim Lesen und einen guten Start in den Frühling.
Ihr Swiss Cleanroom Concept Team
Andrea und Frank Zimmermann
Müller Cleaning Solutions AG - PDC Aufbau und Grundfunktionen
Wir entwickeln ganzheitliche Lösungen für Reinigungsprozesse in der Umgebung der Pharma-, Kosmetik- und Lebensmittelindustrie. Die Reinigungsanlagen funktionieren im Umwälzverfahren und sind selbstentleerend.
Referenzmessungen im Reinraum
Die richtigen Geräte für Ihr Qualifizierungsteam
Messgeräte können nur so genau sein wie die zur Justierung verwendete Referenz. Sie steht am Anfang der MSR-Kette und sollte sorgfältig ausgewählt sein.
Dabei sind Genauigkeit und Vielseitigkeit wichtige Kriterien. Novasina bietet für Klimaparameter wie Luftfeuchte und Differenzdruck mobile Messgerät an.
So sieht Sicherheit aus...
Da Vorschriften verlangen, dass Sie bei der Einführung von Komponenten in aseptische Bereiche sporizide Mittel verwenden, wird die Transferdesinfektion sowohl für Hersteller als auch für Endverbraucher gleichermaßen zu einer großen Herausforderung. Klercide Sporizider Alkohol, die neu patentierte* Formulierung von Ecolab, weist eine Reihe potenziell lebensrettender Eigenschaften auf, darunter eine kurze Ablüftzeit sowie eine sporizide Wirksamkeit in zwei Minuten (EN 13697**).
Das ideale Bodensystem für Reinräume
Traditionsreiche Apotheke setzt auf innovative Produkte von nora systems. Hier verbinden sich traditionelles Apothekerhandwerk und modernste Pharmaproduktion auf herausragende Weise: Die Ries-Apotheke im bayerischen Nördlingen, gegründet 1975, ist ein Familienbetrieb mit drei Apotheken, die Juniorchef Ralf Metzger zusammen mit seinem Vater Werner in der zweiten Generation führt. Zugleich investierte das aufstrebende Unternehmen in ein neues Herstellungsgebäude im Nördlinger Industriegebiet.
Reinstwasser ist immer wieder im Fokus bei Inspektionen
Wo Wasser ist, wachsen Keime. Gefährliche Biofilme können entstehen. Reines Wasser fördert die Entstehung von Rouging. Wie ist das Design Ihrer Wasser-Anlage bzgl. Materialauswahl konzipiert?
Welche Wasser-Qualität braucht Ihr Prozess? Was inspiziert ein Inspektor?
Welche Findings werden immer wieder beanstandet? Wo messen Sie den TOC und den Leitwert?
All diese Fragen werden Ihnen am Seminar "Reinstwasser im GMP Umfeld" am Mittwoch, 13. April 2016 in Aesch von 6 kompetenten Referenten beantwortet. Entdecken Sie im Praxisteil bei der Firma BWT AQUA an konkreten Beispielen, worauf Sie speziell achten müssen.
Melden Sie sich jetzt an. Hier gehts zur Anmeldung...
Neu auch GMP- und Reinraum - Seminare in Deutschland!
Die Swiss Cleanroom Concept GmbH erweitert ihr Seminarangebot und bietet neu auch GMP- und Reinraum-Seminare in Karlsruhe an.
Folgende Seminare finden im Novotel Karlsruhe City statt:
- Das ABC der Reinraumhygiene 18. Mai 2016 Mehr Infos…
- Basisseminar für Reinraummitarbeiter 16. Nov. 2016
Zertifizierte Spezialbeläge für Reinräume und GMP-Bereiche
Die nora flooring systems ag ist Anbieter von hochwertigen Bodensystemen aus Kautschuk mit Sitz in Thalwil am Zürichsee. Die besondere Kompetenz liegt im umfassenden Lösungsangebot für die Marktsegmente Gesundheitswesen, Bildungswesen, öffentlicher Bau und Industrie. Die außergewöhnlichen Produkteigenschaften machen die Kautschuk Bodenbeläge von nora auch in der Industrie in Bereichen wie Produktion und Montage, Laboren und Forschungseinrichtungen, aber auch in Büros und Verwaltungsräumen zur ersten Wahl. Nora bietet zertifizierte Spezialbeläge für Reinräume und GMP - Bereiche verschiedener Klassen.
Reinraumkleid mit Reissverschluss am Rücken
Die Reinraumbekleidung ist speziell geeignet für aseptische Tätikeiten. Die Overalls Absoluter Schutz PA® wurden entworfen, um ein rasches, einfaches und aseptisches Ankleiden zu ermöglichen.
Das Design ist dazu ausgelegt, um den Nutzern Komfort zu bieten und dabei gleichzeitig den Gebläse Effekt zu begrenzen (Ausstoß von Partikeln und Bakterien durch die Öffnungen).
Jedes Design unserer Overalls wird in der Body Box getestet, um ihre Wirksamkeit zu garantieren. Abgerundet durch unsere Partikel- dekontaminationsbehandlung und eventuell per Sterilisation können sie in Reinräumen und sterilen Umgebungen der Klassen ISO 4 bis ISO 8 oder A bis D eingesetzt werden.
Sehen sie im Video wie einfach das Ankleiden ist.
Duo komplett: Weiterer Feinstaubfilter von Camfil in "A+"-Qualität
Neue Hi-Flo Energy Saver Serie vereinigt bewährte Filterleistung, Stabilität und Einbauvorteile mit bislang unerreichter Energieeffizienz
COFELY wechselt den Namen zu ENGIE
Die Gruppe der Cofely AG hat den Namenswechsel von GDF SUEZ zu ENGIE bekanntgegeben. Anfang Mai 2016 wird auch Cofely den Namen übernehmen. Auslöser für diesen Namenswechsel sind tiefgreifende Umwälzungen auf den Energiemärkten der Welt hin zu einer CO2-armen, dezentralen, digitalen Wirtschaft.
Optimaler Einsatz von Bodenbeläge für Reinräume
In zahlreichen Industriebranchen ist eine Produktion ohne den Einsatz von Reinraumtechnik nicht mehr denkbar, denn globale Konkurrenz und steigende Qualitätsanforderungen seitens der Kunden, Verbraucher aber auch der Gesetzgeber erfordern eine stetige Verbesserung der Reinheitsbedingungen von Produktionsanlagen, -prozessen und -umgebungen.
Die nora flooring systems ag ist Anbieter von hochwertigen Bodensystemen mit Sitz in Thalwil am Zürichsee. Die besondere Kompetenz liegt im umfassenden Lösungsangebot für ...
Sehen Sie die neuen Kawasaki Robotern im Einsatz
Bei einem Apero können die beiden Robotermodelle am 18. Februar bei der Firma Kaiser engineering GmbH in Rheinfelden besichtigt werden. Ferner wird ein mobiler kollaborierender Zweiarmroboter zu besichtigen sein. Nähere Informationen entnehmen Sie bitte der Webseite von Kaiser Engineering.
Klicken Sie auf das Bild schauen Sie sich den Video an.
Kawasaki präsentiert 2 neue Robotermodelle für Medizin- und Pharmatechnik
Die Feinmotorik ist ergreifend, das Tempo immer gleich bleibend: Wer auf dezente bis sterile Mitarbeit in Forschung und Produktion setzt, kommt am MC004N und MS005N in Zukunft schwer vorbei. Die beiden neu entwickelten Robotermodelle von Kawasaki Robotics sind speziell für den Einsatz im Reinraum konzipiert worden – und damit für eine veritable Karriere in der Medizin- und Pharmatechnik prädestiniert. Vor allem Prozesse, die bisher nur manuell und ohne konstante Qualität realisiert werden konnten, werden dadurch ab sofort automatisierbar.
Die beiden Robotervarianten eignen sich insbesondere für das Handling von Proben und Tests sowie zum Erstellen individueller Arzneien.
SCC Newsletter 4. Quartal 2015
Zuerst bedanken wir uns ganz herzlich für Ihr Interesse an unseren GMP-Dienstleistungen und Seminaren sowie die gute Zusammenarbeit und freuen uns, auch im neuen Jahr mit Ihnen in Kontakt zu stehen. Für 2016 wünschen wir Ihnen viel Erfolg, spannende Projekte und kreative Antworten auf die anstehenden Herausforderungen. Bevor wir das neue Jahr schwungvoll starten, möchten wir Sie mit diesem Newsletter über Neuheiten und innovative Lösungen zu aktuellen Fragestellungen unserer Reinraumpartner informieren.Von uns können Sie 2016 wieder
• 30 spannende, lehrreiche Seminare
• massgeschneiderte Inhouse Schulungen
• die kontinuierliche Erweiterung unserer Plattform
• 2 ereignisreiche Community Events am 14. April und 24. Oktober 2016
• und ein voll motiviertes Team erwarten.
Wir wünschen Ihnen viel Spass beim Lesen und einen guten Start in ein wunderbares neues Jahr.
Ihr Swiss Cleanroom Concept Team Andrea und Frank Zimmermann
Gesucht: Reinraumreiniger/in

Für unser Team suchen wir ab sofort oder nach Vereinbarung eine dienstleistungsorientierte und motivierte Persönlichkeit als Reinraumreiniger/in.
gempex Schweiz: Neuer Niederlassungsleiter
Seit 2008 ist die gempex GmbH mit einer eigenen Zweigniederlassung in der Schweiz vertreten und begleitet dort Hersteller und Zulieferer bei der Einführung, Optimierung und Aufrechterhaltung von Qualitäts-sicherungssystemen. Schwerpunkte liegen hierbei in der Compliance Beratung, Qualifizierung, IT-Validierung und in der laufenden Betriebsunterstützung.
Produktneuheit Luftreiniger City M
Allergiker müssen geschützt werden. Deshalb rät aha! Allergiezentrum Schweiz nur F7 Luftfilter mit einem Schutzfaktor von mehr als 60% zu verwenden. Nebst dem Hi-Flo B 60+ ist jetzt auch der Camfil Luftreiniger City M mit dem aha Gütesiegel von Allergie Suisse ausgezeichnet worden.
Allergie Suisse publiziert die zertifizierten Produkte auf ihrer Homepage wo der Luftreiniger City M in kürze ebenfalls aufgeschaltet sein wird. Wir sind stolz, allergiegeplagten Menschen in der Schweiz, mit diesem hochwertigen Produkt zu helfen, indem wir dazu beizutragen, ihre Beschwerden zu lindern.
Actemium Schweiz AG ist zertifizierter OSIsoft EcoSphere Partner
Unsere langjährige Erfahrungen auf dem Gebiet der Speicherung von Prozessdaten in Echtzeit, die entsprechende Analyse und daraus folgende Prozessoptimierung werden hiermit bestätigt und konsolidiert.
Das PI System speichert notwendige Informationen über die Mess- stellen im Anlagenumfeld kontinuierlich in einer Prozessdatenbank ab.
gempex GmbH ist neuer SCC Reinraum-Partner
Seit 2002 unterstützt das Dienstleistungsunternehmen führende Firmen der Life Science Industrie sowie deren Zulieferer bei der Einführung, Optimierung und Aufrechterhaltung von Qualitätssicherungssystemen. Schwerpunkte liegen hierbei in der Compliance Beratung, Qualifizierung, IT-Validierung und in der laufenden Betriebsunterstützung.
Die gempex GmbH mit Hauptsitz in Mannheim und weiteren Standorten in Sisseln (Schweiz) und Guangzhou (China), hat sich auf die Umsetzung von GMP (Good Manufacturing Practice) spezialisiert.
Individuell Lösungen für Ihren Reinraum
Cleangrad Reinräume AG ist ein Anbieter von Reinraumlösungen für die Pharma-, Mikroelektronik- und Lebensmittelindustrie, sowie für das Spital- und Gesundheitswesen. Als Eigentümer-geführtes Unternehmen stehen Persönlichkeit in der Betreuung und Zufriedenheit unserer Kunden an oberster Stelle. Mehr als 13 Jahre Erfahrung im Reinraumbau erlauben es uns, nicht nur weitreichendes praktisches Knowhow und Erfahrung in die Projektabwicklung einzubringen, sondern gewährleistet unseren Kunden auch die Einhaltung sämtlicher gängigen nationalen und internationalen Reinraum-relevanten Standards und Regularien: VDI2083, GMP Guidelines, ISO 14644 und FDA.
Geballte Ladung Information am 9. Swiss Cleanroom Community Event
Bereits zum neunten Mal trafen sich Mitglieder der Reinraumbranche zum Community Event, organisiert von Swiss Cleanroom Concept. Über 150 Teilnehmer folgten den prägnanten Firmen-Kurzreferaten und besuchten beim anschliessenden Networking-Apéro die 30 Ausstellerstände um sich über neue Entwicklungen zu informieren. Ein Event mit Klein-Messe-Charakter.
9. Swiss Cleanroom Community Event
Geballte Ladung Information am 9. Swiss Cleanroom Community Event Bereits zum neunten Mal trafen sich Mitglieder der Reinraumbranche zum Community Event, organisiert von Swiss Cleanroom Concept.
Über 150 Teilnehmer folgten den prägnanten Firmen-Kurzreferaten und besuchten beim anschliessenden Networking-Apéro die 30 Ausstellerstände um sich über neue Entwicklungen zu informieren. Ein Event mit Klein-Messe-Charakter.
Über 200 Anmeldungen zum 9. Swiss Cleanroom Community Event
Den Swiss Cleanroom Community Event in Form einer Klein-Messe durchzuführen, hat sich bewährt und ist auf sehr positives Echo gestossen. Deshalb haben wir uns entschlossen, die Anzahl Ausstellertische von 20 auf 30 zu erhöhen. Bereits haben wir über 200 Anmeldungen zum 9. Swiss Cleanroom Community Event vom 3. November erhalten. Seien auch Sie Teil der Community und melden Sie sich jetzt zu diesem kostenlosen Event an.
Point-of-Use Tests von Single-Use Systemen
Die zunehmende Akzeptanz moderner Single-Use Technologien in der Formulierung und Abfüllung führt zu steigenden Anforderungen an die Robustheit und Validierung von Single-Use Systemen.
Aus der Perspektive des Risikomanagements ist die Durchführung von Point-of-Use Tests von Single-Use Systemen daher eine wichtige Vorgabe, um die Dichtigkeit dieser Systeme vor oder nach deren Einsatz zu bestätigen.
Agidens AG ist neuer SCC Reinraum-Partner
Über Agidens: Agidens; ein neuer Name für mehr als 70 Jahre Erfahrung. Als ehemalige Egemin Divisionen, bieten wir Ihnen eine breite Palette von Dienstleistungen für die Prozesse, Industrie und Infrastruktur. Unsere Schwerpunkte sind Prozesse sowie Anlagenbau, E & I, Steuersysteme, MES und Compliance Die Agidens AG mit Sitz in Muttenz hat sich auf die Beratung und Unter-stützung von Kunden der Life Science Branche im Bereich Qualifizierung, Validierung, Prozessautomation sowie Projekt- management spezialisiert.
Neues "EUROVENT- Energie Rating"
Der technische Fortschritt lässt sich nicht aufhalten, in allen Bereichen des Lebens und der Technik ist heute vieles deutlich besser als früher. Das gilt auch für Luftfilter. Es ist nicht sehr lange her, da war der effektive Wirkungsgrad oder Schutzfaktor eines Feinstaubfilters sehr bescheiden. Bei der Filterklasse F7 sind vor 15 Jahren tiefe Wirkungsgrade entladen unter 20% sehr weit verbreitet gewesen. Dank der neuen Prüfnorm EN 779:2012 ist jetzt eine Verbesserung auf wenigstens 35% Mindestwirkungsgrad/Schutzfaktor erreicht worden.
SCC Newsletter 3. Quartal 2015
Mit Freude können wir auf ein erfolgreiches 1. Halbjahr zurückblicken. Neue und bestehende Seminare haben unser Angebot für Sie auf 25 Seminare pro Jahr ansteigen lassen. Immer mehr sind unsere Inhouse Schulungen gefragt. Der Aufbau unserer neuen Page „Wer bietet was?“, auf der Sie die Angebote unserer über 75 Reinraum-Partner finden, kommt gut voran. Auch unser Shop wächst stetig. Schauen Sie doch mal rein. Den Swiss Cleanroom Community Event in Form einer Klein-Messe durchzuführen, hat sich bewährt und ist auf sehr positives Echo gestossen. Deshalb haben wir uns entschlossen, die Anzahl Ausstellertische von 20 auf 30 zu erhöhen. Wir freuen uns jetzt schon auf den 3. November und laden Sie ein, Teil der Community zu sein. Lesen Sie nun die News und Trends unserer Reinraum-Partner.
Exzellente Mess- und Überwachungslösungen für Reinräume und Labore
BRIEM Steuerungstechnik GmbH Ihr Partner für ganzheitliche Mess- und Überwachungslösungen. Von der Planung und Konzeption, über Qualifizierung und Montage bis zur jährlichen Wartung begleitet Sie BRIEM über den gesamten Anlagenlebenszyklus. 7 Gründe für eine Zusammenarbeit mit BRIEM:
7 Gute Gründe für BRIEM
• Qualität • Individualität • Komplettlösungen • Nachhaltigkeit
• Termintreue • Kompetenz
Bestair GmbH ist neuer SCC Reinraum-Partner
Bestair GmbH – unser Name steht seit 2002 für ein umfangreiches Filtersortiment in den Bereichen Fahrzeug- und Industrietechnik. Mit einem Produktprogramm von über 3.000 aktiven Artikeln unterschiedlicher Filtertypen haben wir für viele Anwendungen die richtige Filterlösung.
Herausforderungen in kritischen Umgebungen im Life Science Umfeld
Um näher auf die Herausforderungen in kritischen Umgebungen im Life Science Umfeld einzugehen, veranstaltet Siemens Schweiz am 23. Sep. 15 in Zug sowie am 2. Dez. 15 in Lausanne zwei Swiss Cleanroom Events. In spannenden Referaten erfahren die Gäste alles rund um Gesamtkonzepte für sichere, wirtschaftliche und komfortable Labore im F&E Umfeld, kostenoptimierte Projektabwicklungen, die neue Gebäudemanagment- plattform Desigo CC, sowie umfassende Gebäudetechniklösungen. Zusätzlich sind Live Demonstrationen an einem Labor, einem Wireless Monitoring System, sowie zu den einzelnen Disziplinen wie Energie-Effizienz Lösungen, Brand, Zutritt, Evakuation oder Video ausgestellt, wo die Teilnehmenden die jeweiligen Systeme direkt testen sowie sich mit den Experten austauschen können. In Zug wird das Programm durch eine Führung durch das Brand- und Total Building Solution-Labor abgerundet.
Haben Sie Haar-, Schuppen- und Fusselkontaminationen?
Haar-, Schuppen- und Fusselkontaminationen sind in der Pharmaproduktion höchst unerwünscht. Eine 100%ige Vermeidung wäre wünschenswert.
Die bisher eingesetzten Hauben und Gesichtsmasken aus Faservlies erfüllen die Erwartungen nicht. Als Alternative bieten sich Hauben und Gesichtsmasken aus Micromesh an. Micromesh wird aus feinsten Polyamidfäden (PA6 dtex22/1 halbmatt) hergestellt. Mittels Einsatz einer speziellen Wirktechnik erreicht man beim Micromesh eine sehr dichte Maschenstruktur. Die Dichte der Maschenstruktur kann den jeweiligen Hygieneanforderungen angepasst werden.
Schülke & Mayr AG sucht Sie!
Wir suchen für unsere Niederlassung in der Schweiz einen engagierten
Regional Sales Manager (m/w)
Sie verfügen über einen Studienabschluss in Naturwissenschaften oder Technik und bringen ein breites Produkt- und Anwenderwissen mit. Weiter besitzen Sie ein hohes Mass an unternehmerischem Denken und Handeln sowie ausgeprägte Dienstleistungsorientierung und Teamfähigkeit. Ihr Umfeld überzeugen Sie durch Ihr gewinnendes Auftreten und Ihre Begeisterungsfähigkeit.
Echtzeitüberwachung mit elproMONITOR
Täglich werden in Apotheken, Spitälern und anderen klinischen Zentren kritisch die vorherrschenden Umgebungsbedingungen in den Kühlschränken, Lagerräumen oder Produktionsräumen überprüft, in denen verschiedene medizinische Produkte gelagert sind oder hergestellt werden. Die Klimadaten werden dann entweder zeitaufwendig von Hand festgehalten oder lokal gespeichert. Dabei sind meistens mehrere Personen und Abteilungen in diesen Prozess involviert, was eine optimale Überwachung noch komplexer und anfälliger für Fehler macht und auch zu keiner klaren Übersicht führt.
Anforderungen an die Herstellung unsteriler Arzneimittel
Fortbildungsseminare fokussieren sich thematisch im Schwerpunkt meist auf Trainings für sterile Herstellungsbereiche in der Pharmazie.
Besagt dies, die Produktion von unsterilen Arzneimittel ist
- weniger wichtig?
- geringer im Aufwand nach GMP?
- risikoärmer gegenüber Kontaminationen?
- leichter in der Verantwortlichkeit?
Das Seminar am Mi 16. Sep. 2015 in Rheinfelden beleuchtet, prüft und diskutiert die wesentlichen Kriterien unsteriler Arzneimittelherstellung.
Actemium in einer Minute erklärt
Wollen Sie auch einen Beitrag zum Schutz der Umwelt leisten und die Lebensqualität Ihrer Kunden, Mitarbeiter und Familienangehörigen erhöhen?
Die Automationslösungen- und Dienstleistungen der Actemium Schweiz AG basieren auf einem langjährigen und breiten Fachwissen in den Bereichen Industrie- und Gebäudeautomation, welche Ihnen helfen werden dieses Ziel zu erreichen.
Komplettlösung für Ihr Umgebungsmonitoring
Entdecken Sie LABGUARD® 3D The next generation!
Labguard 3D ist die neue 360° - Komplettlösung für Umgebungs- monitoring von bioMérieux. Tragen Sie bei zur Sicherheit, Qualität und zur Erfüllung behördlicher Vorgaben mit der neusten Innovation Ihres Anbieters von Labor Umgebungsmonitoring Lösungen. Mit mehr als 15 Jahren Erfahrung auf diesem Gebiet entsprechen unsere Produkte selbst den höchsten qualitativen und behördlichen Anforderungen.
Erfahren Sie mehr in unserem Video
HUBERLAB. Safe
|
Sehr geehrte Damen und Herren Print-Katalog anfordern Ihr HUBERLAB.Team |
 |
Jobst Willers Engineering AG ist neuer SCC Reinraum-Partner
Planung für Pharma, Spital und Labor
Seit mehr als einem Vierteljahrhundert projektieren wir gebäude- technische Anlagen für Pharma, Spitäler und Labore:
• HVAC / Medien (HLKSE, MSRL, Reinmedien)
• GMP Upgrades und Qualifizierung
• Reinraum- und Laborplanung (Decken, Wände, Böden) mit Möblierung
Solida AG ist neuer SCC Reinraum-Partner
Mit ihren einzigartigen Micromesh Hauben hat Solida AG in der Schweizer Lebensmittelindustrie eine führende Position erreicht. Micromesh Hauben stellen nicht nur die hohen Anforderungen an Hygiene sicher, sie zeichnen sich auch aus durch hohen Tragkomfort, Luftdurchlässigkeit, Haltbarkeit und vorteilhaftes elektrostatisches Verhalten. Der Tragkomfort und das vorteilhafte Klima wirken sich sehr direkt auf die Leistung und die Motivation der Mitarbeitenden aus.
Das Micromesh Gewebe ist äusserst reissfest und bildet keine Fusseln. Die Randelastik ist sehr soft (man spürt sie kaum) und latexfrei, so dass keine Hautirritationen auftreten können.
SCC Newsletter 2. Quartal 2015
Der Sommer hat uns fest im Griff, da wünscht man sich die Temperaturen eines Reinraumes. Wir können mit Freude auf ein erfolgreiches 1. Halbjahr zurück blicken. Neue und bestehende Seminare haben unser Angebot für Sie auf 25 Seminare pro Jahr ansteigen lassen. Der Aufbau unserer neuen Page „Wer bietet was?“, auf der Sie die Angebote unserer über 70 Reinraum-Partner finden, kommt gut voran. Neu hat auch unser Shop ein neues Kleid bekommen. Analog „Wer bietet was?“ finden Sie hier spezifische Angaben zu den verschiedenen Themengebieten. Das neue Konzept der Swiss Cleanroom Community Events hat regen Anklang gefunden. Wir freuen uns bereits auf das nächste Event vom 3. Nov. 2015. Lesen Sie nun die News und Trends unserer Reinraum-Partner.
Wir wünschen Ihnen einen schönen Sommer.
Ihr Swiss Cleanroom Concept Team, Andrea und Frank Zimmermann
Notfall Dekontamination
Dekontamination von Räumen bei infektiösen und multiresistenten Keimen.
Die Ebola-Epidemie ist in Westafrika schnell vorangeschritten und erst jetzt greifen die Massnahmen in den betroffenen Ländern. Es sind allerdings bereits mehrere tausend Menschen infiziert worden und viele sind bereits verstorben. Zudem stellen multiresistente Keime das Gesundheitswesen vor immer grössere Herausforderungen. Welche Massnahmen gibt es, um eine Ausbreitung dieser Krankheitserreger zu verhindern?
Radioaktive Medikamente für Diagnostik und Therapie
Moderner Neubau am Inselspital in Bern
Die Produktion und Logistik radioaktiver Medikamente gleichen einem Wettlauf gegen die Zeit: Aufgrund ihrer geringen Halbwertszeit von einigen Stunden bis wenigen Tagen müssen die Medikamente schnellstmöglich verabreicht werden. Mit dem 25 Millionen Schweizer Franken teuren Neubau verfügt das Inselspital über eine hochmoderne Infrastruktur direkt auf dem Spitalareal. Sie deckt den Eigengebrauch und stellt Produktionskapazität für weitere Schweizer Spitäler bereit.
NNE Pharmaplan ist neuer SCC Reinraum-Partner
Über NNE Pharmaplan
NNE Pharmaplan ist ein internationales, auf Pharma Engineering fokussiertes Unternehmen. Wir helfen pharmazeutischen Unternehmen mit flexiblen, GMP-konformen und zukunftssicheren Lösungen, ihre Produkte auf den Markt zu bringen.
Wir beschäftigen bis zu 2.000 Fachkräfte, die mit globalem Wissen und bewährten Methoden unsere Kunden weltweit und an lokalen Standorten unterstützen.
Rotronic feiert erfolgreiches halbes Jahrhundert
50 Jahre Rotronic - mit Messgeräten zum Weltunternehmen
Am 14. Juli 1965 gründete der Diplom-Ingenieur Hans Speglitz die Rotronic AG in Zürich. Rotronic war der erste Auslandsdistributor der deutschen Firma Schroff, die drei Jahre früher als Hersteller von 19-Zoll-Schränken gegründet wurde. Nach der Bedeutung des Namens gefragt, meinte der inzwischen verstorbene Speglitz „ROTRONIC – das steht für ElekTRONIK – wir fanden den Namen einfach griffig und einprägsam mit diesem ROTen Logo“.
Trends in der Reinraumtechnik
Die Schweizer Reinraum Community, ein Konzept der Swiss Cleanroom Concept, dient dem Networking zwischen Experten, Anwendern und Anbietern zu Reinraumthemen. Über 100 Mitglieder der Community nahmen am 8. Community Event in Muttenz teil, um sich über neueste Entwicklungen in der Reinraumtechnik zu informieren und auszutauschen. Lesen Sie den Artikel der Fachzeitschrift Chemie plus.
Jetzt erhältlich.. der neue HUBERLAB. Katalog inkl. Reinraum-Sortiment!
Auf rund 1100 Seiten finden Sie alles, was es im Labor braucht! Sichern Sie sich jetzt Ihr Exemplar (Mail mit Ihrer Postadresse an info@huberlab.ch). Eine Auswahl aus über 1 Million Produkte mit neuer Gliederung in Themenbereiche folgen dem Ziel, Ihre Arbeitsabläufe zu optimieren sowie Arbeitsabläufe effektiver und einfacher zu gestalten. Die exzellente Qualität unserer bewährten und neuen innovativen Produkte wird Sie überzeugen.
Newsticker zum 9. Swiss Cleanroom Community Event am 3. Nov 2015
Das Interesse der Besucher und die Stimmung am letzten Swiss Cleanroom Community Event waren überwältigend und haben gezeigt, dass in der Region Bedarf an einem Informationsaustausch zwischen Firmen und Anwendern besteht. Dies hat uns dazu bewogen, das Event zu erweitern und nun insgesamt 30 Firmen eine attraktive Werbe- und Präsentationsplattform zu bieten. Schon kurz nach dem letzten Event waren die Plätze für Referate ausgebucht. Für Ausstellertische haben wir schon fast 20 Anmeldungen. Wenn Sie also mit Ihrer Firma präsent sein wollen, melden Sie sich jetzt hier an.
Sie möchten sich als Besucher in lockerer Atmosphäre einen Überblick über 8 spannende Themen aus Ihrer Praxis verschaffen, das Angebot von 30 Firmen kennenlernen und interessante Kontakte knüpfen? Dann reservieren Sie sich schon heute den 3. Nov. 2015 ab 16:30 Uhr und seien Sie Teil der Community. Wir freuen uns auf Ihren Besuch. Hier geht’s zur Anmeldung.
M+W Process Industries GmbH ist neuer SCC Reinraum-Partner
M+W Process Industries GmbH, ein Tochterunternehmen der M+W Group, ist ein internationaler Anlagenbauer. In der Schweiz ist die Firma seit vielen Jahren tätig – und unterstützt mit globalem Know-how Schweizer KMU dabei, noch besser zu werden.

Click here to request an appointment
Vollautomatisiertes Monitoring der Händehygiene
In Reinraumbereichen ist sorgfältige Händehygiene von besonderer Wichtigkeit. Mit dem OPHARDT Hygiene Monitoring System® können Sie objektiv messen, ob und wie häufig Seifen- und Desinfektions- mittelspender tatsächlich benutzt werden. Die vollautomatisierte Systemlösung besteht aus WiFi Desinfektionsmittelspendern, die ihre Nutzung registrieren und die Nutzungsdaten an ein zentrales Auswertungssystem senden.
Dabei wird für jeden Spender differenziert der genaue Zeitpunkt der Betätigung („Timestamp“) und die Entnahmemenge von Desinfektions- mittel oder Seife gemessen. Das Händehygieneverhalten kann so transparent gemacht und dank Echtzeit-Feedback zeitnah verbessert werden.
Reinstwasser im GMP Umfeld
In der Pharma- und Biotechindustrie sind die Reinstmedien, zu denen u.a. auch das Reinstwasser gehört, die wichtigsten und kritischsten Versorgungsmedien zur Aufrechterhaltung der Produktion. Aus diesem Grund unterliegen diese Anlagen, die bei der BWT Aqua AG am Standort in Aesch zentral gefertigt werden, besonders hohen Qualitäts- anforderungen. Diese Anforderungen werden als GMP (Good Manufacturing Practice) bezeichnet.
Erfolgreiche Personalführung im Reinraum Bereich
Kennen Sie die Situation? Wegen einer fehlerhaften Schichtübergabe, in der nicht alle Informationen korrekt übermittelt wurden, müssen Sie eine Deviation (Abweichungsbericht) schreiben. Die Produktqualität wurde möglicherweise gefährdet, der Verkauf der produzierten Menge ist fraglich. In reinen Räumen stellt der Mensch die grösste Verunreinigungsquelle dar. Fehlerhafte Eingriffe von Mitarbeitern haben eine hohe Tragweite auf die Produktqualität. Dieser Umstand führt einerseits zu vermehrtem Konfliktpotenzial, andererseits erhöhen sich die Anforderungen an die Mitarbeitenden.
Sie wollen etwas bewegen? Wir suchen Sie!
Als Pharmatechniker/in begleiten Sie Qualifizierungen von Reinraum-Monitoring Systemen bei Kundenprojekten in Deutschland, Österreich und der Schweiz. So betreuen die kontinuerliche Weiterentwicklung unserer Software im Bezug auf die Software Validierung nach GAMP 5. Sie pflegen das Qualitätsmanagementsystem. Als Spezialist für Regalarien beraten Sie nach GMP/FDA/GAMP Kunden und Partner von Briem Steuerungstechnik.
110 Teilnehmende am 8. Swiss Cleanroom Community Event
Noch immer sind wir begeistert von der tollen Atmosphäre am 8. Swiss Cleanroom Community Event vom letzten Donnerstag. 110 Teilnehmende und rund 20 Ausstellerfirmen haben dazu beigetragen. Wir bedanken uns ganz herzlich bei den Ausstellern, den Referenten und den Besuchern. Die vielen positiven Feedbacks bestätigen unser Konzept. Mit kleinen Anpassungen wollen wir den Anlass am 3. Nov. 2015 im gleichen Rahmen durchführen. Neu werden wir 30 Firmen die Möglichkeit geben, einen Ausstellerstand zu buchen.
8. Swiss Cleanroom Community Event
Noch immer sind wir begeistert von der tollen Atmosphäre am 8. Swiss Cleanroom Community Event vom letzten Donnerstag. 110 Teilnehmende und rund 20 Ausstellerfirmen haben dazu beigetragen. Wir bedanken uns ganz herzlich bei den Ausstellern, den Referenten und den Besuchern.
Bereits über 135 Anmeldungen zum 8. Swiss Cleanroom Community Event
Das neue Konzept der Swiss Cleanroom Community Events am 16. April 2015 bietet 8 Firmen die Möglichkeit, in Kurzreferaten von jeweils 15 Minuten News, Trends, Produkte- oder Leistungserweiterungen usw. vorzustellen. Weitere rund 10 Firmen nehmen mit einem Ausstellerstand teil. Im Anschluss an die Referate können die Besucher aktuell haben sich bereits 135 Teilnehmer angemeldet, die Ausstellerstände besuchen. Die Besucher werden mit einem kleinen Imbiss und Getränken, wie gewohnt kostenlos bewirtet. Zur Anmeldung....
Spiromed AG ist neuer SCC Reinraum-Partner
Die Spiromed AG mit Sitz in Gelterkinden BL, bietet Ihnen ein umfassendes Angebot rund um die Entsorgung und Transport jeglicher Abfälle aus der Medizin, der Chemie sowie der Pharma.
Seien es Zytostatika, schädliche Chemikalien oder Abfälle aus Labor und Medizintechnik, die Spiromed AG ist Ihr Partner für korrekte Entsorung und Recycling.
Anforderungen an Fertigspritzen
Fertigspritzen gewinnen in der modernen Medizin und Pharmazie immer mehr an Bedeutung. Wurden sie früher hauptsächlich zur Injizierung von Impfstoffen und niedermolekularen Herparinen verwendet, so wird ihr Anwendungsbereich heute durch die starke Zunahme biotechnologisch hergestellter Proteine als Therapeutikum stetig erweitert.
Aber auch die Vorteile für Patienten, wie die Reduktion von Dosierfehlern und der zusätzliche Sicherheitsgewinn gegenüber der konventionellen Spritze, lassen die Fertigspritze immer attraktiver erscheinen. Verbesserungen im Herstellungs- und Abfüllungsprozess tun ihr Übriges.
Erfahren Sie mehr über dieses Thema an unserem Seminar:
"Single Use im Reinraum-Bereich" am 07. Mai 2015 in Rheinfelden
BLOCK Technical AG ist neuer SCC Reinraum-Partner
Der Verband der Block® GROUP ist eine starke internationale Gruppe auf dem Markt von Lieferanten von Investmentanteilen. Block® GROUP bietet umfassende Dienstleistungen bei der Projektvorbereitung, Fertigung und dem Aufbau von Investitionsprojekten mit anspruchsvoller Technologie und qualitativ hochwertigen Umwelt (Reinraum). Für diese Einrichtungen wird auch Follow-up-Service und Validierung angeboten.
Sichere Dampfsterilisation kritischer Komponenten
Easy-Tear Beutel als ultra-reines Packungsmaterial.
Pall Life Sciences stellt seine NewformTM Easy-Tear CleansteamTM Beutel für die Dampfsterilisation kritischer Komponenten in der biopharma- zeutischen Herstellung vor.
Die ultra-reinen Beutel erfüllen kritischste Anforderungen an den Sterilisationsprozess. Sie eignen sich beispielsweise zur Sterilisation von Edelstahlausrüstung, Probefläschchen oder Spritzen.
Novasina AG ist neuer SCC Reinraum-Partner
Die Novasina AG ist seit mehr als 50 Jahren als Spezialist für die genaue und zuverlässige Bestimmung der relativen Feuchte in Luft und Material sowie Differenzdruckmessungen unterwegs.
Die digitale Sensorfamilie nSens erlaubt flexibelste Einsatzmöglichkeiten und ist zusammen mit dem Multisensorfähigen Quantadat Messumformer ein ideales Team für die zuverlässige und genaue Klimaüberwachung.
Cleankeys® für den professionellen Einsatz in reinen Räumen
GETT ist einer der führenden Anbieter für professionelle Bedientechnik "Made in Germany". Als Hardware-Spezialist realisieren wir hochwertige Produkte und Lösungen für die Bereiche Industrie, Gewerbe und Medizin. Unter unserer Eigenmarke "InduKey" entwickeln und produzieren wir sowohl Baugruppen als auch komplette, schlüsselfertige Bedienlösungen. Die Herstellung der Produkte erfolgt in der hauseigenen Fertigung, die den Charakter einer Manufaktur trägt.
Morath AG Edelstahl - Ihr Partner für GMP und Hygienic Design
Zuhause im Herzen der Life-Sciences-Region Nordwestschweiz, entwickelt und produziert die Morath AG Edelstahleinrichtungen für nationale und internationale Kunden aus den Bereichen Pharma und Biotech, Kosmetik und Lebensmittelindustrie.
Zum weiteren Kundenkreis zählen Spitäler, Kliniken und Pflegeheime. Darüber hinaus werden Edelstahlmodule für die Verfahrenstechnik produziert und Edelstahlerzeugnisse an Maschinenbauer in Europa, Asien und Übersee geliefert.
ASYS Reinraum für GEWO Feinmechanik
Auf einer Gesamtfläche von über 600 m² realisierte die ASYS Prozess- und Reinraum-technik Reinräume der ISO Klasse 5 bis 7 bei der Firma GEWO in Wörth/Hörlkofen. ASYS übernahm die komplette Planung und Realisierung der Reinräume inklusive Nebenräume und einer Teile-Vorreinigung. Die GEWO Feinmechanik GmbH nutzt die partikelfreie Umgebung für die Montage von Baugruppen sowie für die reinraumgerechte Verpackung von Endprodukten.
Neu im Leistungsspektrum der L+S AG: Ames-Test
Sie sind Hersteller von z.B. Arzneimitteln oder Industriechemikalien und benötigen für Ihr Registrierungs-, Bewertungs- und Zulassungsverfahren Unterlagen bei der Europäischen Chemikalienagentur (ECHA) noch eine Untersuchung auf genotoxische Eigenschaften unter GLP-Bedingungen? Dann ist die Labor L+S AG mit dem wieder eingeführten Ames-Test die richtige Anlaufstelle für Sie!
Schutzkleidung gegen Ebola von Kimberly-Clark
Kimberly-Clark Schutzanzüge, Handschuhe sowie Hand- und Oberflächendesinfektionsmittel sind zwar nicht speziell für den Schutz gegen das Ebolavirus getestet und zugelassen, die Produkte erfüllen jedoch die Schutzanforderungen die jüngst von Gesund- heitsorganisationen veröffentlicht wurden. Wir empfehlen Ihnen, regelmässig die Websites der Gesundheitsorganisationen zu besuchen, um sich in Bezug auf die Verfahren zur Infektionskontrolle auf dem Laufenden zu halten.
Erhöhte Energieeffizienz und Sicherheit Im Labor bei Dow Europe in Horgen
Dow ist eines der größten Chemieunternehmen der Welt mit dem Hauptsitz in Midland/USA. Die europäische Konzernzentrale liegt in Horgen, nähe Zürich in der Schweiz. Die Firma ist global führend in den Bereichen Forschung und Technologie für Chemikalien, Kunststoffe und Agrarprodukte.
Perfektion im Reinraumbau
Cleangrad veröffentlicht mit Stolz, dass wir wieder die Bestätigung, unserer konstanten Leistungen durch die ISO Zertifizierung, aufzeigen konnten. International Organization for Standardization –ISO, koordiniert die internationale Normung um eine weltweit einheitliche Qualität zu schaffen.
Die Zertifizierung bedeutet, dass unser Unternehmen den Aufbau eines Managementsystems, bzw. eines Qualitätsmanagementsystems im Sinne der ISO-Normenreihe erfolgreich erfüllt.
Single-Use Hochleistungsmischer für die Pharma
Aufarbeitung kleiner Volumina in der Pharmaproduktion Pall Life Sciences stellt seinen neuen AllegroTM 50 Liter Single-Use Mischer als weiteren Bestandteil seines wachsenden Portfolios an Single-Use Produkten und Services für die Arzneimittelherstellung vor. Er wurde als Scale-down Version der größeren Allegro Mischer (200-1000 Liter) zur Aufarbeitung kleiner Prozessvolumina (2-50 Liter) konzipiert.
Achtung, hochaktiv!
Nahezu 50 Prozent der marktgängigen Arzneimittel bestehen bereits aus hochaktiven Pharmawirkstoffen und aktuelle Schätzungen zeigen, dass der Anteil solcher Wirkstoffe künftig beträchtlich ansteigen wird. Doch was sind eigentlich hochaktive Wirkstoffe? Was ist im Umgang mit ihnen zu beachten? Dieser Artikel gibt Ihnen eine Einführung und zeigt auf, wie Verpackungsanlagen für solide Darreichungsformen und deren Umgebung ausgerüstet sein müssen, um einen adäquaten Personen und Umgebungsschutz zu bieten.
Schweizer Präzision auf höchstem Niveau!
Seit 1965 bietet ROTRONIC AG Lösungen für die Messung der Parameter Feuchte und Temperatur an. Um unseren Kunden ein Maximum an Genauigkeit und Flexibilität bieten zu können, entwickeln wir unsere Produkte kontinuierlich weiter, suchen aber auch ständig nach Produkterweiterungen. So haben wir unser Produktportfolio in den letzten Jahren um CO2- und Differenzdruckmessung ergänzt. Damit steht unseren Kunden ein immer grösseres Angebot an technologisch hochstehenden Messlösungen in den entsprechenden GMP Zonen zur Verfügung.
8. Swiss Cleanroom Community Event am 16. April 2015
Das neue Konzept der Swiss Cleanroom Community Events steht unter dem Motto :
Starke GMP- und Reinraumpartner vor Ihrer Haustür. Nutzen Sie diese Kompetenz für Ihren Erfolg!
Es bietet 8 Firmen die Möglichkeit, in Kurzreferaten von 15 Minuten News, Trends, Produkte- oder Leistungserweiterungen etc. vorzustellen. Weitere 5 bis 10 Firmen nehmen mit einem Ausstellerstand teil. Das Hotel Mittenza mit seinem Kongresszentrum bietet ideale Verhältnisse für diesen Anlass sowie genügend gratis Parkplätze und eine gute Anbindung an den öffentlichen Verkehr.
Chemgineering Technology GmbH sucht Sie!
Die Chemgineering Group ist ein international agierender Beratungs- und Ingenieurdienstleister mit Niederlassungen in der Schweiz, Deutschland, Österreich und Serbien. Als Spezialisten für effiziente Abläufe konzipieren und realisieren wir anspruchsvolle Projekte für Industrien aus den Bereichen Pharma, Biotechnologie, Feinchemie, Medizintechnik, Kosmetik, Vitamine, Diagnostika und Lebensmittel.
Für unsere Abteilung „Energy & Infrastructure“ suchen wir aktuell an unserem Standort in Wiesbaden eine/n Gruppenleiter/in Lüftungs- und Reinraumtechnik für folgende Tätigkeiten:
Risikomanagement in der Pharmaindustrie
Kennen Sie den Life Cycle Approach? Darunter versteht man den Lebenszyklus eines Arzneimittels in Begleitung eines Risikomanagement-Systems. Die überarbeitete und erweiterte 2. Auflage der vorliegenden ptj-Ausgabe bietet Ihnen umfassende Informationen zu ausgewählten Aspekten eines Risikomanagements in der pharmazeutischen Praxis.
Anforderungen · Methoden · Praxisbeispiele
Lernen Sie von den regulatorischen Vorgaben und Tools über die praktische Anwendung das Risikomanagement bei Ausgangsstoffen, bei der Herstellung von pharmazeutischen Wirkstoffen sowie Arznei-trägerstoffen kennen. Der risikobasierte Ansatz ermöglicht schließlich die Entwicklung begründeter Prozessparameter und Spezifikationen.
laminar GmbH ist neuer SCC Reinraum-Partner
Die Firma LAMINAR GMBH ist ein schweizerisches Unternehmen und besteht seit 2007. Unsere Tätigkeiten bewegen sich im Bereich: Reinraumtechnik, Lüftungstechnische Qualifizierung, Instandhaltung und Wartung an Lüftungstechnischen Anlagen, HLK und dem dazugehörigen Engineering.
Firmenvideo von Cleangrad Reinräume AG
Cleangrad’s Produktion und Verwaltung liegt in Ljutomer, Slowenien. Die Region im Nord-Osten Sloweniens, nahe der österreichischen und ungarischen Grenze, wird auch als “Herz von Prlekija” bezeichnet. Cleangrad’s Produktionsstätte umfasst 4500m2 und zeichnet sich durch modernste Maschinen und einen ISO-zertifizierten Produktionsprozess aus. Durch den Einsatz neuester Technologien und einer mehr als 10-jährigen Erfahrung in der Fertigung von Reinräumen, garantieren wir höchste Qualität unserer Reinräume.
Cleangrad Reinräume AG ist neuer SCC Reinraum-Partner
Cleangrad’s langjährige Zusammenarbeit mit etablierten europäischen Kunden zeugt von Zuverlässigkeit und Vertrauen. Cleangrad bietet technologisch fortgeschrittene Reinraumlösung an, welche nachhaltig zur Wettbewerbsfähigkeit unser Kunden beitragen.
Gegenseitiger Respekt und gemeinsamer Erfolg bilden die Basis für Cleangrad’s Geschäftstätigkeit – und auch die Basis für Cleangrad’s nachhaltiges Wachstum.
Cleangrad’s Produkte entsprechen allen international gängigen Standards, insbesondere GMP- und FDA. Cleangrad ist stolz darauf, eine umfassende Kundenliste mit treuen und international bekannten Namen zu führen.
5 Jahre Swiss Cleanroom Concept GmbH
Wir freuen uns, Ihnen anlässlich unseres 5 jährigen Firmenjubiläums als Dankeschön für Ihre Treue einen Gutschein über 50.- CHF zu überreichen. Diesen Gutschein können Sie oder einer Ihrer Mitarbeitenden an einem unserer Seminare einlösen. Bitte geben Sie dafür bei Ihrer Online Buchung den Vermerk "Gutschein" ein. Der Gutschein ist gültig bis zum 10. Januar 2015. Einen Überblick auf die aktuellen Seminare finden unter:
https://www.swisscleanroomconcept.ch/de/seminare/programm
Wir freuen uns, Sie an einem unserer Seminare begrüssen zu dürfen und wünschen Ihnen ein erfolgreiches und gesundes Jahresende.
Ihr Swiss Cleanroom Concept Team Frank und Andrea Zimmermann
CCSTEC Cleanroom Control ist neuer SCC Reinraum-Partner
Wir sind spezialisiert auf Partikelmesstechnik.
Die Firma Lighthouse bietet eine komplette Produktlinie für Reinraumüberwachung an. Wir die Firma CCSTEC sind Distrubutor der Golighthouseprodukte für mehrere Länder. Das Lieferprogramm umfasst Laserpartikelzähler (Handheld- und Remotegeräte) und komplette Monitoringsysteme. Als ein Marktführer in der Partikelmessung und bei Monitoringsystemen bürgt die Firma LIGHTHOUSE für innovative Technologie und hohe Qualität.
Leistungsverzeichnis 2015 der Labor L+S AG abrufbar
Download steht ab sofort zur Verfügung!
Das Leistungs- und Preisverzeichnis 2015 der Labor L+S AG, einem der führenden europäischen Auftragslabore für die Pharma-, Kosmetik- und Medizintechnikindustrie, steht zum Download im Passwort geschützten Bereich auf der Homepage für Sie bereit. Gerne können Sie die Zugangsdaten bei uns anfordern. Einfach E-Mail an Ihren Vertriebsansprechpartner Alexander Pfülb (alexander.pfuelb@labor-ls.de) und Sie erhalten Ihren persönlichen Zugangscode.
Rund 100 Teilnehmer am 7. Swiss Cleanroom Community Event
Das 7. Swiss Cleanroom Community Event hatte am 25. September für die Besichtigung des Projektes „Sanierung und Erweiterung OP-Ost“ eingeladen. Rund 100 Teilnehmer aus mehr als 60 verschiedenen Firmen strömten in das Universitätsspital Basel und liessen sich dieses interessante Event nicht entgehen.
Frank Zimmermann, Geschäftsführer von Swiss Cleanroom Concept GmbH begrüsste die Teilnehmer im Hörsaal-Nr. 6 des Universitätsspitals Basel.
Reinraumreinigung im Kantonsspital St. Gallen
Ein Aspirin gegen Kopfschmerzen, ein Nasenspray gegen den lästigen Heuschnupfen, ein Hustensaft gegen das Kratzen im Hals. Wer hat nicht schon zum Medizinschrank gegriffen, um sich Erleichterung zu verschaffen. Doch haben Sie sich schon einmal überlegt, in welcher Umgebung diese Medikamente entstehen?
Medikamente, wie wir sie in unserem Alltag benutzen, aber auch hochkomplexe Medikationen, die in der Dosierung genau auf den Patienten abgestimmt sein müssen, werden in Reinräumen produziert, die höchste Ansprüche an die Reinigung und Desinfektion stellen.
Integrierte Lösungen für effiziente und sichere Reinräume und Labore
Reinräume und Labore stellen grosse Herausforderungen dar, besonders was die Optimierung der Betriebskosten, Ansprüche an die Qualität, der Verfügbarkeit und die Sicherheit betrifft. Hinter den Prozessen, die in diesen Umgebungen ablaufen, stecken beträchtliche Vorinvestitionen, wie es die hohen Forschungskosten in der Life Science Industrie aufzeigen. So ist es nur folgerichtig, dass in diesen Umgebungen Lösungen eingesetzt werden, die auf intelligenter Gebäudetechnologie basieren, welche die Anforderungen und Richtlinien zur Qualitätssicherung erfüllen können. Als Beispiel von dedizierten Lösungen die Compact Monitoring Technologie und die Laborlösung von Siemens.
Betriebshygiene: Ergebnisse innerhalb von Sekunden
Bei der MALDI TOF-Massenspektrometrie werden geringe Mengen einer Probe in eine niedermolekulare Matrix gegeben. Laserbeschuss und Absorption der Laserstrahlung ermöglichen dabei die Anzeige von ribosomalen Proteinen und deren Darstellung als „Fingerabdruck“.
Die so erhaltenen Massenspektren werden von der Datenbank automatisch ausgewertet, die Ergebnisse aufgeführt. Die MALDI TOF-Methode (Matrix-assisted Laser/Desorption Ionisation Time Of Flight) bietet im Vergleich zu herkömmlichen biochemischen oder molekularbiologischen Methoden zur Identifizierung eine Reihe von praktischen Vorteilen. An erster Stelle steht hier der Faktor Zeit: Nach Eingabe der vorbereiteten Probe in das Gerät liegen die gewünschten Ergebnisse innerhalb von Sekunden vor.
Verfahren in der TOC Messung
In der pharmazeutischen Industrie sind die Qualitätsvorgaben für das in der Produktion eingesetzte Wasser besonders hoch. Um die Qualität des verwendeten Reinstwassers jederzeit zu garantieren, setzen immer mehr Arzneimittelhersteller auf eine automatisierte und kontinuierliche Überprüfung der Aufbereitungsanlagen und der Reinstwasserkreisläufe.
Die Einführung des TOC-Gehalts (Total Organic Carbon, Gesamtgehalt des organischen Kohlenstoffs) als Spezifikation für Reinstwasser 1998 im Arzneibuch der USA war ein wichtiger Schritt in dieser Entwicklung. Ähnlich der Vorgabe für die anorganische Belastung des Wassers (Leitfähigkeit) konnte nun auch die organische Belastung mit Hilfe eines Summenparameters nach gewiesen werden.
Temperatur Mapping - eine sichere Sache!
Falsche Lagertemperaturen können zu erheblichen Schäden an den gelagerten Produkten führen. Dies gilt es unter allen Umständen zu vermeiden und den finanziellen und produktspezifischen Schaden zu verhindern! Aus diesem Grund, verlangen die GxP – Regulatoren diverser Länder den dokumentierten Nachweis, dass die verwendeten Einrichtungen für die Lagerung von pharmazeutischen Produkten geeignet sind. Wird dieser Nachweis nicht erbracht, müssen die Hersteller, Verteiler oder Lagerbetreiber allenfalls mit strengen Sanktionen rechnen. ROTRONIC bietet einen den Standard entsprechenden Temperatur Mapping Service an – kontaktieren Sie uns noch heute für detailliertere Informationen.
Schweisstechnische Beratung & professionelle Videoendoskopie
Liebe Kunden und Geschäftspartner
Gerne informieren wir Sie darüber, dass wir im Bereich Werkstofftechnik und Schweissnahtbeurteilungen verstärkt tätig sind. Verantwortlich für diesen Bereich sind unser Schweissfachingenieure, Herr Gunter Blumhofer und Herr Frank Eitel, die Ihnen gerne weiterhelfen. Dazu bieten wir auch endoskopische Untersuchungen mit einem modernen Videoendoskop an. Testen Sie uns, wir freuen uns darauf!
7. Swiss Cleanroom Community Event
Das 7. Swiss Cleanroom Community Event hatte am 25. September für die Besichtigung des Projektes „Sanierung und Erweiterung OP-Ost“ eingeladen. Rund 100 Teilnehmer aus mehr als 60 verschiedenen Firmen strömten in das Universitätsspital Basel und liessen sich dieses interessante Event nicht entgehen.
Einladung zum 7. Swiss Cleanroom Community Event
Das Universitätsspital Basel lädt Sie in Zusammenarbeit mit Cofely AG Basel ein, die Umsetzung des Projektes Sanierung und Erweiterung OP-Ost zu besichtigen.
Das Projekt umfasst unter anderem die folgenden Umbauten bzw. Sanierungen wir werden uns auf die HLK Umbauten und die Operationssäle fokussieren und natürlich besichtigen. Melden Sie sich jetzt an.
Wir haben bereits mehr als 110 Anmeldungen erhalten!
BOOMERANG Monitoring System - Neue Version mit WLAN
Wir freuen uns, Ihnen die vielen, praxisbezogenen Neuerungen unseres Boomerang Monitoring Systems vorstellen zu können.
Auf Kundenwunsch haben wir das Benutzer-Handling vereinfacht und die Performance unserer Software signifikant gesteigert.
Nebst verbesserter Überschaubarkeit können die Benutzer der Benutzergruppen nun ganz einfach zu den Sensoren und den Alarmen gelangen.Neu bieten wir auch einen Hochpräzisions-Temperatursensor mit unserem Boomerang Monitoring System an. Dieser ist speziell für die genaue Temperaturüberwachung in Inkubatoren geeignet.
Abfüllanlagen für die Pharma-Industrie
Von der kleinen halbautomatischen Füllstation bis zur vollautomatischen Abfüllhalle für flüssige und pastöse Produkte - mit kompletten Abfüllanlagen zum Lagern, Fördern, Abfüllen, Palettieren und Abfördern.
Jede Baugruppe, jedes Einzelmodul ist beliebig zu kombinieren, individuelle Konstruktionen, Material- und Anpassungswünsche realisieren wir in Zusammenarbeit mit der Feige GmbH Abfülltechnik für Sie.
ELPRO-BUCHS AG zieht um
Die ELPRO-BUCHS AG wird in Kürze ihr neues Gebäude beziehen! Aufgrund des Umzugs ist das Büro am Donnerstag, 11.Sep.2014, 16.00 Uhr bis Montag, 15.Sep.2014, 07.30 Uhr geschlossen. Die ELPRO-BUCHS AG entschuldigt sich für allfällige Unannehmlichkeiten während dieser Zeit. Der neue ELPRO Hauptsitz wird von der Langaeulistrasse 62 an folgende neue Adresse verlegt:
Schenken Sie Wachstumskontrollen mehr Beachtung
Wachstumskontrollen dienen vor allem der Überprüfung der Nährmedien und biete nmehr Sicherheit und eine verbesserte Prävention.
Wachstumskontrollen – ja oder nein
Stets entscheidet der Auftraggeberselbst, ob diese durchgeführt werden sollen. Da sie vor allem der Überprüfung des verwendeten Nährmediums auf ausreichende Enthemmung dienen, sieht er darin möglicherweise nur die erhöhten Aufwendungen und die damit verbundenen Mehrkosten.
Filtration für die Pharma- und Medizinbranche
Die Inbetriebnahme eines Reinraums eröffnet neue Möglichkeiten um weiterund vertiefter in den Pharmasektor und den medizinischen Bereich vorzudringen – Neue Dienstleistungen erschliessen neue Märkte.
Vor 5 Jahren herrschten wirtschaftlich rauhe Zeiten in denen so manche Firma im Land eine abwartende Position einnahm. Nicht so Peter Hirschi, Inhaber und Geschäftsführer des heute rund 70 Mitarbeitende zählenden Unternehmens Lanz-Anliker AG in Rohrbach im Kanton Bern.
6. Swiss Cleanroom Community Event
Die Swiss Cleanroom Community traf sich zu einem Informationsrundgang und zu einem Apéro in den Räumen der Gastgeberfirma SKAN in Allschwil. SKAN, Spezialist für Sicherheit im Labor, informierte die Teilnehmer des Community Events bezüglich Anlagen für den Produkte-, Personen- und Umgebungsschutz. Zu diesem Anlass hatte die Swiss Cleanroom Concept GmbH gemeinsam mit SKAN geladen. Einen Community Event der etwas anderen Art erlebten die 60 Besucher am 3. Juli 2014.
Reinraummesstechnik für den Anwender in Theorie und Praxis am 17. Sep.
Am 17. Sep. 2014 organisiert die Firma Swiss Cleanroom Concept GmbH bereits zum 4. Mal das Seminar „Reinraummesstechnik für den Anwender“ in den Seminarräumen der Firma CAS Clean-Air-Service AG in Wattwil.
Melden Sie sich jetzt hier an.
Rückblick auf das Seminar vom 5. Feb. 2014. Rund 20 interessierte Personen aus unterschiedlichen Branchen fanden den Weg ins Toggenburg. Mit dem Referat „Qualifizierung eines Reinraumes“ führte Herr Andreas Bächler, Leiter der Qualitätssicherung bei CAS, in die Thematik ein.
Sind Sie fit für den Reinraum?
Melden Sie sich jetzt hier für das Seminar Hygiene, korrektes Verhalten und Reinigung im Reinraum vom 24. Sep. 2014 in Rheinfelden an.
Rückblick auf das Seminar vom 19. Februar. Mit einer Mischung aus Theorie und Praxis konnten die Teilnehmer effektiv alles Wichtige über Hygiene, korrektes Verhalten und Reinigung im Reinraum lernen. Der Morgen begann mit einer Einführung zum Thema Kontaminationsquellen. Sehr anschaulich wurde den Teilnehmern erläutert, wie Bakterien den Körper eines Menschen besiedeln und wie sie weiter gegeben werden.
Neu BioBall MultiShot 108Bacillus subtilis ATCC® 19659
Die Firma bioMérieux bietet Ihnen neu mikrobiologische Referenzstämme in Form von wasserlöslichen Bällchen, die mit einer genau definierten Anzahl lebensfähiger Zellen oder Sporen hergestellt werden und somit als quantitative Referenz eingesetzt werden können.
Anwendungsbereiche
o Eingangskontrollen nach EP/USP für Nährmedien
o Methodenvalidierungen
o Konservierungsmittel-Belastungstests
Sicherer Steriltransfer großer Fluidvolumina
Neue Sterilkonnektoren für die biopharmazeutische Herstellung.
Pall Life Sciences erweitert sein Portfolio an Sterilkonnektoren. Mit Einführung der neuen KleenpakTM II Sterilkonnektoren stehen nun einfach handhabbare und robuste Single-Use Konnektoren auch für den sterilen Transfer großer Fluidvolumina im Upstream Processing und im Downstream Processing zur Verfügung.
Reinraum Strömungssimulationen
Im Reinraumbereich spielt die Qualitätssicherung eine wichtige Rolle. Vor allem in der Pharma-, der Lebensmittel- und der Futtermittelindustrie müssen die Produkte vor Verunreinigungen geschützt werden. Dabei kann eine gute Klimalösung den Luftbedarf und damit die Installations- und Betriebskosten wesentlich reduzieren. Mit Strömungssimulationen beantworten wir Ihnen unter anderem folgende Fragen: Wie ist die Luftströmung im Raum? Ist die Zu- und Abluft optimal? Wie verteilen sich freigesetzte Partikel? Werden Reinheitsklassen eingehalten?
Neues innovatives, neutrales Derougingmedium
Die Beratherm AG bringt ein innovatives, neutrales Derougingmedium der neuesten Generation auf den Schweizer Markt. BERA-DR NT zeichnet sich durch folgende Vorteile aus:
• Höchst effektives universelles Breitband Spektrum
• Keine Stickstoffüberlagerung notwendig
• Kein Materialangriff
• Einfache Entsorgung
Lanz Anliker innovative Filterherstellung für die Medizin und Pharmaindustrie
Die zunehmende Anzahl Anfragen der chemischen und pharmazeutischen Industrie hat uns dazu veranlasst, in unsere Filtrationsabteilung einen Reinraum zu integrieren. Wir freuen uns, Ihnen mitteilen zu können, dass die Firma Lanz-Anliker AG über einen Konfektionsraum für die Filterherstellung unter Reinraumbedingungen verfügt. Der Filterkonfektionsraum entspricht der Reinraumklasse 7 nach ISO EN 14644-1 oder der Klasse C nach Pharma Guide. Erfahren Sie mehr über uns in unserem Firmenvideo.
6. Swiss Cleanroom Community Event
Einen Community Event der etwas anderen Art erlebten die 60 Besucher am 3. Juli 2014 in den Räumlichkeiten der Skan AG. Um Interessierte und Kunden bezüglich Anlagen für den Produkte-, Personen- und Umgebungsschutz auf dem neuesten Stand zu halten und Lösungen für kundenspezifische Anwendungen zu präsentieren, organisierte Skan gemeinsam mit der Swiss Cleanroom Concept GmbH diesen Community Event. An acht Stationen, sogenannten Produktinseln, wurden die Gäste in Gruppen hautnah über Trends und Neuheiten informiert.
AFC ab 01. Juli 2014 neu im Technopark Zürich
Wir freuen uns Ihnen mitzuteilen, dass unser Wunsch nach mehr Platz endlich in Erfüllung gegangen ist. Vom 27. Juni bis 30. Juni 2014 werden wir unsere alten Räumlichkeiten an der der Weinbergstrasse und der Scheuchzerstrasse verlassen und in unser neues Firmendomizil im Trendquartier Zürich-West ziehen.
Im repräsentativen TECHNOPARK beziehen wir in der 5. Etage im Trakt Darwin rund 580 Quadratmeter Bürofläche. Wir freuen uns sehr darauf, in diesem innovativen Umfeld tätig sein zu dürfen sowie Sie in unserem neuen AFC-Zuhause begrüssen, beraten und begeistern zu dürfen.
Aktuelle Dienstleistungspalette der Imtech-Steri AG auf einem Blick
Wir sind Ihr kompetenter Partner. Profitieren Sie von unseren Erfahrungen.
Wartung und Fehlerbehebung Wir bieten die Wartung von Autoklaven in verschiedensten Grössen und Fabrikate von allen Herstellern an und leisten schnelle, flexible und unkomplizierte Hilfe bei Störungen und Pannen jeglicher Art. Auf Kundenwunsch erhalten Sie von uns einen 24-Stunden Support an 7 Tagen in der Woche.
Umbau Als Umbauspezialisten passen wir Ihre alte Anlage, egal welchen Fabrikats und Alter, an die aktuell geltenden Sicherheitsvorschriften und -Normen an und bringen sie gleichzeitig auf den neusten Stand der Technik, z.B. Installation einer neuen SPS-Steuerung oder von rostfreien Rohrleitungen.
Qualifizierung /Validierung Unsere Valdierungstechniker qualifizieren / requalifizieren die zu prüfenden Anlagen mit dem Validierungs-System der Firma Kaye oder mit dem drahtlosen Data Logger-System von Ellab. Zudem führen wir auch Kalibrierungen von Temperatursonden und Druckmess- umformer, sowie die Qualifizierung des Dampfes für Sie durch.
Bereits mehr als 80 Anmeldungen zum 6. SCC Event vom 3. Juli
Es haben sich bereits schon mehr als 80 Personen zum 6. Swiss Cleanroom Community Event am 3. Juli 2014 bei der Firma SKAN AG in Allschwil angemeldet. Wir werden die Möglichkeit haben, uns an 8 verschiedenen Stationen hautnah über Trends und News zum Thema Hygiene und Arbeitssicherheit im Labor zu informieren. Sicherheitswerkbänke, Isolatoren, Personenschutz, Dekontamination sind nur einige der Punkte, die an diesem kostenlosen Abend geboten werden.
Beim anschliessenden Apéro können Sie Ihr Netzwerk pflegen und ausbauen. In Diskussionen mit den Referenten oder Teilnehmern den Stoff vertiefen, Problemstellungen erörtern und vieles mehr. Es hat noch Plätze frei. Melden Sie sich jetzt hier an.
Zusammenschluss der Unternehmen Ateco Services AG und AP Tobler AG
Die Eigentümer der Ateco Services AG und der AP Tobler AG haben sich entschieden, die Geschäftstätigkeit beider Unternehmen zusammen- zulegen. Seit dem 1. April firmiert die fusionierte Unternehmung unter dem Namen ATECO TOBLER AG. Beiden Unternehmen ergänzen sich ideal. Der Zusammenschluss ermöglicht es den Kunden als Mehrwert ein grösseres Produkteportfolio und somit mehr Lösungen und Dienstleistungen anbieten zu können.
Mikrobiologisches Keim-Messsystem für Isolatoren
Der CLiMET CI-99 ist da!
- Mikrobiologisches Keim-Messsystem für Isolatoren
- 100 Liter pro Minute Durchflussrate
- Kontinuierliches Monitoring- Status LED
- Ethernetschnittstelle- Verwendbar mit 90 mm StandardPetrischalen
- EU GMP Annex 1 kompatibel
Zu wenig Personal oder zu geringe Kapazitäten?
Die Labor L+S AG steht Ihnen bei der Durchführung von Media Fills zur Seite. Als Dienstleistungslabor steht Ihnen die Labor L+S AG auch hier als Partner zur Verfügung. Die Leistungspalette umfasst dabei standardmäßig:
• Erstellung von Prüfplänen
• Inkubation und Auswertung der Proben
• Identifizierung bei positiven Befunden
• Durchführung von Wachstumskontrollen und
• Aufnahme Ihrer Hauskeime in die Stammsammlung.
Bizerba Schweiz und Busch-Werke AG fusionieren
Bizerba Schweiz und Busch-Werke AG fusionieren zum Schweizer Marktführer für industrielle Wäge- und Fördertechnik.
Die Bizerba (Schweiz) AG, hundertprozentige Tochtergesellschaft der Bizerba GmbH & Co. KG, und die Busch-Werke AG bündeln ihre Kompetenzen und bedienen ab sofort unter dem Namen Bizerba Busch AG als gemeinsames Unternehmen den Schweizer Markt. Heinz Busch, der bisherige Geschäftsführer der Busch-Werke AG, leitet das Unternehmen, das seinen Sitz mittelfristig nach Trimmis verlegen wird, in der Funktion des CEO.
Automatisierte TFF-Systeme für die Pharmaherstellung
Pall Life Sciences stellt seine neuen vollautomatisierten CentrasetteTM TFF-Systeme für die Pharmaherstellung vor. Die Anlagen mit Membranflächen zwischen 0,2 m² und 4,0 m² eignen sich hervorragend für Mikrofiltrations- und Ultrafiltrationsanwendungen im Pilot- und Produktionsmaßstab unter GMP-Bedingungen. Das modulare Design (Optionen für pH-Messung, Leitfähigkeitsmessung oder UV-Messung) sorgt für eine hohe Flexibilität der Systeme, die gemäß Anwenderspezifikation konzipiert werden.
Modernisierung und Erweiterung ohne Betriebsunterbrechung
Eine sichere und effiziente Arbeitsumgebung ist einer der wichtigsten Faktoren,um den langfristigen Erfolg eines Unternehmens zu garantieren. Keine Branche wird stärker reguliert als die Pharmaindustrie. Aufsichts- behörden richten ihr besonderes Augenmerk auf die Kontrolle der Arzneimittelqualität, um die Gesundheit von Menschen zu schützen. Aus diesem Grund wird Compliance bei Johnson & Johnson groß geschrieben. Mit ihrer breitgefächterten Erfahrung und ihrem umfangreichen Know-how hilft Siemens dem Pharmakonzern Johnson & Johnson im schweizerischen Le Locle, alle regulatorischen Auflagen einzuhalten.
Reinigungsanlagen für die pharmazeutische Produktion
Strategischer Umzug der Müller AG Cleaning Solutions an den Hauptsitz der Müller-Gruppe in Münchenstein BL – Modernste Fabrikation und Testständeam neuen Standort. Am Hauptsitz in unmittelbarer Nähe zu den Schwestergesellschaften bezieht die Müller AG Cleaning Solutions ein neues Büro- und Produktionsgebäude. Es bietet genügend Platz für die weitere Expansion des Unternehmens und für die Abwicklung von Grossaufträgen.
vali.sys gmbh ist neuer SCC Reinraum-Partner
Die Firma vali.sys gmbh ist ein innovatives KMU-Unternehmen. Das Team besteht aus Informatik- und Verfahrenstechnikspezialisten und hat fundiertes Know-How aus Anwendungsbereichen wie Reinraumtechnik, Pharma- und Medizinaltechnik, Medienaufbereitung, Gebäudeleittechnik und IT-Technologie. Das Unternehmen ist somit primär in den Bereichen Industrielle Automatisation und Monitoring-Systeme tätig.
Regeneriermittel für hygienisch saubere Wasserenthärtungsanlagen
BWT SANISAL P wurde speziell zur Regenerotion von Wosserenthärtern im Pharmabereich entwickelt.BWT SANISAL P isl ein Regeneriersolz mit einer wirkungsvollen Reinigungskomponente in Tablettenform mit hervor- ragender Hygienewirkung. SANISAL P mit 2 in 1 Funktion bietet Regeneration und Sanitisierung in einem Schritt
- Ideale Alternative zu teuren thermischen / chemischen Sanitisierung
- Sanitisierung automatisch bei ieder Regeneration
- lntegrierter Schutz des Salztanks
- Höhere Betriebs- und Produktionssicherheit
- Geringere lnvestilions- und Energiekosten
H. Lüdi+Co. AG ist neuer SCC Reinraum-Partner
Die Marktstärke der H. Lüdi+Co. AG besteht darin, richtungsweisende Entwicklungen in der Laborwelt zu realisieren und dadurch dem Kunden optimale Produkte zu bieten. Wir spüren den Puls der Zeit und sehen es als unsere Aufgabe, die jeweils besten Technologien für unsere Kunden erlebbar zu machen. Dazu gehören innovative Ideen sowie die ständige Bereitschaft, sich neu zu erfinden und zu verbessern.
gut+madörin lüftung ag wird zu gisiger madörin ag
Zum 50-jährigen Jubiläum stellen wir uns neu auf:gut+madörin lüftung ag wird zu gisiger madörin ag.
Sehr geehrte Damen und Herren
Die gut+madörin lüftung ag feiert ihren 50. Geburtstag! Seit 1964 erbringen wir mit grosser Freude und hohem Engagement für unsere Kunden qualitätsbewusste Leistungen in den Bereichen Lüftung, Heizung, Klima, Kälte und Reinraum.
Kabelloses Handschuh-Prüfsystem "WIRELESS GT"
Wireless GT, das fortschrittlichste und vollautomatische Handschuh-Prüfsystem für Isolatoren und RABS in der pharmazeutischen Industrie. Die Bedienung ohne Schläuche und Kabel ist einfach. Alle notwendigen Funktionen, um einen verlässlichen Handschuhtest durchzuführen, sind in dem Akku-betriebenen Gehäuse integriert. Das Testprinzip ist die Fähigkeit, der Handschuheinheit am Isolator, dem Überdruck standzuhalten, der vom Testgehäuse über einen bestimmten Zeitraum erzeugt wird.
MHRA GUIDANCE SUPPORTS STERISHIELD DELIVERY SYSTEM
Ecolab Contamination Control has welcomed recently published guidance from the MHRA (Medicines and Healthcare products Regulatory Agency) regarding dispensing systems for disinfectants in cleanrooms.
It emphasises the need to reduce the potential for contamination of the contents during preparation and manufacture by using a protective closed system, defined as one which is not exposed to the atmosphere.
Pharmagerechte Edelstahlmöbel im Reinraum nach GMP
Stähli Industrieberatung GmbH bietet Ihnen mit seinen Partnern Edelstahlmöbel für Reinräume. Diese sind leicht zu reinigen, wartungsarm, hygienisch einwandfrei, keimabweisend und beständig auch bei extremen Temperaturen. Weitere Vorteile sind: Sie werden Ihnen nach Ihren individuellen, räumlichen Gegebenheiten erstellt.d.h. passgenaue Fertigung. Komplett in Edelstahl 1.4301. Herstellung nach GMP/FDA Richtlinien. Kein Schwarzmaterial im Bereich der Edelstahlfertigung. Abnahmeprotokoll für jedes Möbelstück. Design für leichtes und problemloses Reinigen. Konsequent geschlossene, doppelwandige Bauweise.
Einladung zum 6. Swiss Cleanroom Community Event am 3. Juli
Wir freuen uns, Sie am 3. Juli 2014 zum 6. Swiss Cleanroom Community Event bei der Firma SKAN AG in Allschwil einladen zu dürfen. Wir werden die Möglichkeit haben, uns an 8 verschiedenen Stationen hautnah über Trends und News zum Thema Hygiene und Arbeitssicherheit im Labor zu informieren. Sicherheitswerkbänke, Isolatoren, Personenschutz, Dekontamination sind nur einige der Punkte, die an diesem kostenlosen Abend geboten werden.
Beim anschliessenden Apéro können Sie Ihr Netzwerk pflegen und ausbauen. In Diskussionen mit den Referenten oder Teilnehmern den Stoff vertiefen, Problemstellungen erörtern und vieles mehr. Wir erwarten 60 bis 80 Teilnehmer aus rund 50 Firmen. Wir freuen uns auf Sie!
Seminar Sicherer Umgang mit Zytostatika 7. Mai / Es hat noch freie Plätze!
Die Kunst des korrekten Umgangs mit Zytostatika, ist eine Perle pharmazeutischer Fertigung. Hochaktive Wirkstoffe, mit vorhandenem Gefahrenpotential für die eigene körperliche Unversehrtheit, gepaart mit der Pflicht zu aseptischer Herstellung, stellen höchste Anforderungen, an das Geschick des Durchführenden.
Die Einsicht in definierte Handlungsweisen, sowie das Verständnis gegenüber Arbeitssicherheit und Guter Herstellungspraxis, ist das Ziel dieses Seminars.
ICU Scandinavia Schweiz GmbH ist neuer SCC Reinraum-Partner
Die ICU Scandinavia Schweiz GmbH ist ein im Jahr 1996 gegründetes, ISO 9001- und ISO 13485-zertifiziertes Ingenieurbüro und Dienstleistungsunternehmen für Elektronik- und Software-Anwendungen. Wir sind vorwiegend im Bereich Medizinaltechnik tätig und entwickeln kundenspezifische Lösungen. Nebst dem Hauptsitz in Schweden hat die ICU Niederlassungen in Polen und Dänemark. Mit dem Boomerang Monitoring System hat die ICU ein Produkt auf dem Markt, welches in verschiedenen Industriezweigen (Labor, Pharma, Lebensmittel) eingesetzt und weltweit vertrieben wird.
Mit Raumdekontamination die bestmögliche Hygiene sichern
Mikrobiologische Kontaminationen von stark frequentierten, hochsensiblen Räumen und Anlagen können eine Gefahr für Mensch und Umwelt darstellen. Die Behebung erfordert profundes Knowhow und ein perfektes Zusammenspiel aller Projektpartner. In hochsensiblen Bereichen von Produktion und Forschung wie etwa in Reinräumen, Labors und der Lebensmittelproduktion gelten strenge hygienische Vorschriften.
ECOLAB benennt SHIELD MEDICARE Abteilung um
Ecolab hat den Namen seiner Shield Medicare-Abteilung in Ecolab Contamination Control geändert.
Andy Newsome, Vizepräsident von Global Contamination Control, sagte: „Seit der Übernahme von Shield Medicare im Jahr 2006 sind wir Schritt für Schritt zu dem neuen Namen übergegangen. Dieser Name unterstreicht unsere Produkte und Dienstleistungen jetzt noch besser, während auch die Verbindung zur Ecolab-Marke verstärkt wird.“
AFC erhält die Auszeichnung "C2E - Committed to Excellence"
Auf dem Weg zur Business Excellence. Die AFC Air Flow Consulting AG erhält als erstes Unternehmen für Brandschutz und Bauklimatik in der Schweiz die Auszeichnung „Verpflichtung zur Excellence“ (Committed to Excellence) der EFQM. Im Rahmen einer kleinen Feier übergibt Frau Maria Maier, Assessorin der Stiftung Esprix, die Urkunde.
Die AFC Air Flow Consulting AG erhält von der EFQM (European Foundation for Quality Management) als erstes Schweizer Ingenieurbüro Unternehmen in dem Bereich Brandschutz und Bauklimatik, das begehrte Qualitätssiegel “Committed to Excellence“.
Lanz-Anliker AG ist neuer SCC Reinraum-Partner
Die Lanz-Anliker AG hat sich in der technischen Konfektion seit ihrer Gründung 1919 bis heute zu einem bedeutenden, national und international tätigen Unternehmen entwickelt. Heute werden über 70 Mitarbeitende beschäftigt. Am Anfang stand eine Sattlerei als reiner Handwerksbetrieb. Heute wird die Herstellung anspruchsvollster technischer Produkte durch eine effiziente Produktion mit modernstem Maschinenpark erreicht. Die Entwicklung technischer Textilien ist unsere Stärke!
Flexible Reinraumlösungen und Trockenlagersysteme
Unsere hochwertigen Produkte und Dienstleistungen spielen eine Schlüsselrolle bei der Qualitätssicherung und Optimierung industrieller Produktionsprozesse unserer Kunden. Die ASYS Prozess- und Reinraumtechnik GmbH sorgt seit 1997 als eigenständiges Unternehmen innerhalb der ASYS Group für innovative Lösungen aus den Bereichen Reinraumtechnik, Laminarflowsysteme, Trockenlager- systeme, Lagerliftsysteme und Sonderlösungen.
Warum ist die Auswahl von Mitarbeitern im Reinraum so wichtig?
Es hat nur noch wenige Plätze am Seminar Erfolgreiche Personalführung im Reinraum Bereich vom 12. Februar 2014 frei. Melden Sie sich jetzt noch an. Zur Anmeldung...
Laut VDI 2083 Blatt 15 gilt der Mitarbeiter als grösste Verunreinigungsquelle für das im Reinraum hergestellte Produkt. Deshalb wurden arbeitsmedizinische Eignungskriterien für Reinraum Mitarbeitende erarbeitet. Medizinische Eignungskriterien schliessen z.B. Erkrankungen der Haut, der Lungen, der Bronchien oder des Magen-Darm-Traktes aus.
Gute Hygiene Praxis
Die Einhaltung strenger Hygienemaßnahmen und -kontrollen spielt für die Sicherstellung der Qualität pharmazeutischer und verwandter Produkte eine entscheidende Rolle. Dies gilt sowohl für Forschung und Entwicklung als auch für Produktion, Abfüllung und Verpackung. Bei behördlichen Inspektionen entfällt ein bedeutender Anteil der Beanstandungen auf Hygienefehler.
![]() Teilnehmer des Seminars "Reinraumhygiene" vom 19. Februar 2014 in Rheinfelden können das Buch "Gute Hygiene Praxis" zum Vorzugspreis von 75.00 CHF statt 89.50 CHF beziehen.
Teilnehmer des Seminars "Reinraumhygiene" vom 19. Februar 2014 in Rheinfelden können das Buch "Gute Hygiene Praxis" zum Vorzugspreis von 75.00 CHF statt 89.50 CHF beziehen.
Neues QM- und GMP-Office in St. Gallen
Die Testo Industrial Services AG eröffnet im Februar 2014 ein ausgelagertes GMP- und QM-Office für Qualitätssicherung in der Ostschweiz (St. Gallen).
Dort kümmern sich Experten um die Optimierung Ihrer GMP- und Qualitätsmanagementmassnahmen sowie um die Erstellung, Optimierung, Pflege und Verteilung Ihrer Q-Dokumente.
IE Industrial Engineering Zürich AG sucht Sie!
Die IE Industrial Engineering Zürich AG sucht für die Medizinaltechnik- und Pharma-Industrie eine(n)
ProzessplanerIn / VerfahrenstechnikerIn
Ihr Aufgabengebiet
Sie projektieren und realisieren als Fabrikplaner komplexe Industrie- bauten. Sie arbeiten eng mit unseren Architekten und Bauspezialisten zusammen und gewährleisten als Branchenspezialist, dass die Kundenbedürfnisse vollumfänglich umgesetzt werden.
Vermietung und Reinigung von Mops
Seit 1968 ist SNDI der Experte auf dem Markt für die Miete / Pflege von Berufsbekleidung und Zubehör für Reinräume und beherrschte Umgebungen. Zu den Dienstleistungen gehört neu auch die Vermietung und Reinigung von Mops. Die folgenden Vorteile bieten Ihnen diese Mops:
- geeignet für Reinräume mit ISO 5 bis 8 oder A bis D Klassifikation
(gemäss ISO Standard 14644-5)
- Anpassungsfähig: Die Mops können zur Reinigung von Böden, Decken
und Wänden benutzt werden
- Grosse Reinigungsmenge: Ein Mop kann 20m2 reinigen
- Kleiner Verbrauch von Putz- und Desinfektionsmittel:
110ml für Desinfektionen und 70ml für Reinigungen
Unabhängig Medien automatisiert herstellen
Aufbauend auf eine über 30 jährige Erfahrung in der Herstellung von Kulturmedien Präparatoren hat AES CHEMUNEX (ein Unternehmen von bioMérieux) wahrscheinlich die zuverlässigste automatisierteste Aufbe-reitungsanlage für Medienbereiche entwickelt.“
Neue PEEK Einwegnadeln für die Abfüllung
Die neue PEEK Einwegnadel für Abfüllungen erweitert das Produkt- spektrum mit einer neuen Dimension.
AllegroTM Single-Use Abfüllnadeln sind eine sofort einsatzbereite Lösung für die finale Abfüllung von Flüssigarzneimitteln. Sie vermeiden Kreuzkontaminationen und machen eine zeitaufwändige Reinigungs-validierung überflüssig.
Im Reinraum gibt es keinen Platz für Risiken
Im Reinraum gibt es keinen Platz für Risiken. Unsere Process Match Garantie hilft, diese zu eliminieren. Die Klercide Produktpalette von Ecolab besteht aus voll validierten Produkten für die Kontaminations- kontrolle.
Hergestellt im Reinraum für die Verwendung im Reinraum. An unserem maßgefertigten Produktionsstandort stellen wir sterile Produkte nach GMP Standard her - genau wie unsere Kunden.
Schwebstofffilter-Luftdurchlass mit abklappbarem Luftdurchlasselement
Durrer-Technik AG führt im Sortiment den Puri -… - Schwebstofffilter-Luftdurchlass neu als universelles Modulbausystem. Das Filteraufnahmegehäuse lässt sich, als Abklappvariante, mit verschiedenen Luftdurchlässen kombinieren.
Die Reinraumklassen 6 bis 8 nach DIN EN ISO 14644-1 bzw. C und D nach EU-GMP werden im Allgemeinen durch die turbulente Mischlüftung erzielt. Einer Lüftungsform, bei der die in den Raum eingebrachte reine Zuluft durch Induktion mit der Raumluft – möglichst intensiv – vermischt wird.
News zu Hach Company - Particle Counting Division
Wir freuen uns Ihnen mitzuteilen, dass sich Hach Company – Particle Counting Division und Beckman Coulter Life Sciences zusammenschließen.
Durch die Integration des Produktportfolios der Markenprodukte MET ONE und HIAC in Beckman Coulter Life Sciences, maximieren wir die Synergien zwischen den sich ergänzenden Fachbereichen.
Unisept Filtergehäuse mit optimiertem Innenleben
Das Unisept-Filtergehäuse für den Einbau eines endständigen Schwebstoff-Filters ist mit allen, der Sicherheit dienenden Kontrollmöglichkeiten ausgestattet. Es lässt sich einfach in jede Decken- oder Wandkonstruktion integrieren.
Das Filtergehäuse der Unifil AG wird aus verzinktem Stahlblech (weiss RAL 9010, beidseitig einbrennlackiert) oder aus rostfreiem Stahl gefertigt und ist in 7 Grössen für Luftmengen von 150 bis 1200 m3/h lieferbar.
Seminarangebote 2014
Ein entscheidender Faktor zur Sicherstellung der Qualität von Produkten ist qualifiziertes Personal. Die Forderung nach regelmässigem Training und entsprechendem Bildungsnachweis für Mitarbeitende findet sich daher in allen Qualitätsrichtlinien.
Swiss Cleanroom Concept GmbH ist Ihr kompetenter Partner für erfolgreiche Weiterbildung im GMP Bereich.
Wählen Sie aus grundlegenden Basistrainings, Seminaren zu top-aktuellen Themen oder Intensivtrainings zur Schulung von Soft-Skills.
SCC Newsletter 4. Quartal 2013
Das Jahr 2013 verabschiedet sich langsam. Es ist Zeit, für den Newsletter des 4. Quartals. Wir freuen uns, Ihnen wieder viel Wissenswertes und Interessantes unserer Reinraumpartner bieten zu dürfen. Seien Sie gespannt auf die innovativen Lösungen zu aktuellen Fragestellungen.
Wir bedanken uns an dieser Stelle ganz herzlich für Ihr Interesse an unseren GMP-Dienstleistungen und Seminaren und freuen uns, auch im nächsten Jahr mit Ihnen in Kontakt zu sein.
Fungizide Wirkung von QAV Desinfektionsmitteln
Quartäre Ammoniumverbindungen (QAV) sind hervorragende Wirkstoffe in Produkten zur Desinfektion, da sie eine geringe Toxizität, eine gute Reinigungsaktivität und eine bakterizide Wirksamkeit aufweisen. Leider sind viele der heute auf dem Markt erhältlichen QAV-Produkte unverträglich mit einigen Sterilisationsmethoden und weisen eine unzureichende fungizide Wirkung auf. Diese Nachteile können dazu führen, dass der Einsatz von QAV-Desinfektionsmitteln in Reinräumen nach ISO-5 vermieden wird.
Erfolgsfaktoren für die Auswahl eines Monitoring-Systems
Egal ob Zytostatika Apotheke in der Ostschweiz oder Herstellung von Produkten für sterile Anwendungen unter Reinraumbedingungen in der Zentralschweiz. Reinraum-Monitoring ist in den unterschiedlichsten Bereichen nötig um die Personen- und Produktschutzziele zu erreichen. Ob GMP (Good Manufacturing Pratice) oder FDA und Co. es gelten immer strengere Vorschriften und Regelungen, deren Einhaltung im Rahmen des QM-Systems überwacht werden muss. Ein wichtiges Werkzeug hierfür ist ein auf die speziellen Anforderungen zugeschnittenes Monitoring-System.
Auch rostfreier Edelstahl will gepflegt werden
Die Silbe „Edel“ im Wort Edelstahl impliziert wie bei Edelmetallen Unvergänglichkeit, Reinheit und dauerhaft saubere Oberflächen. Leider ist dem aber nicht so, im Gegenteil.
Gerade bei Neuanlagen oder neu eingebauten Anlagenteilen, die den Einflüssen des Fertigungs-Alltags ausgesetzt waren, verlangen Edelstahloberflächen in Anlagen der Pharmazie, Chemie, Lebensmittelindustrie oder Medizin besondere Aufmerksamkeit. Die rostfreien bis rostträgen Legierungen sind noch mit Trennmittelrückständen, Ölfilm, Staub, Abrieb etc. verschmutzt und haben noch keine ausreichende Schutzschicht ausgebildet. Sie entsprechen daher noch nicht den chemischen und vor allem hygienischen Anforderungen, die an solche Anlagen gestellt werden.
ABSOLUTE TM Neuer starker Markenname von Camfil
ABSOLUTE TM – Neuer starker Markenname von Camfil
Absolute ist ein HEPA-Filter, der keine Kompromisse kennt. Und so soll es auch sein, denn schliesslich geht es hier um den Schutz Ihrer Gesundheit. Das System leistet aber ausserdem Schutz bei empfindlichen Verfahren, bei denen keine gefährlichen Partikel in der Luft schweben dürfen.
Der erste Absolute Filter wurde vor vielen Jahren in unserem eigenen Forschungslabor mit dem Ziel höchste Qualität zu bieten produziert. Nun soll eine neue Generation eingeführt werden. Informieren Sie sich auf unserer Website www.camfil.ch über die besten Absolute Filter, die je hergestellt wurden:
Testo Industrial Services AG eröffnet neues Service Center in Kaiseraugst
Die Testo Industrial Services AG mit Sitz in CH 8132 Egg bei Zürich, verbessert ihren Service und ihre Leistungen mit noch mehr Kundennähe durch die Eröffnung eines ersten Service-Centers und Service Stützpunktes in der Schweiz am Standort in Kaiseraugst bei Basel.
Die stark wachsende Anzahl von Kunden und Aufträgen im Grossraum Basel sowie in den angrenzenden Gebieten erfordern mehr Präsenz und Kundennähe von unserem Onsite Team vor Ort. Dadurch können kurzfristige Anfragen und Projekte besser und kundenorientierter koordiniert und umgesetzt werden.
Neu: Zusammenarbeit mit dem Editio Cantor Verlag
Die Swiss Cleanroom Concept GmbH hat sich spezialisiert auf die Vermittlung von Wissen an Personen und Firmen im GMP und Reinraumbereich. Dies tun wir hauptsächlich durch Seminare.
Weiterbildung in Form von Seminaren ist ein wichtiger Baustein im Geschäftsleben. Der GMP und Reinraumbereich ist stark reguliert. Deshalb wird gerne auf fundierte Nachschlagewerke zurückgegriffen.
Um Ihnen auch in diesem Bereich behilflich sein zu können...
Seminar "Anforderungen an Barriere Systeme"
Am 24. Oktober 2013 fand in den Seminarräumlichkeiten der Firma Skan in Allschwil das Seminar Anforderungen an Barriere Systeme statt. Rund 20 Personen konnte Swiss Cleanroom Concept GmbH dazu begrüssen. Gestartet wurde mit einem unterhaltsamen Vortrag von Wolf Dieter Wanner über die Reinigung in reinen Bereichen. Christian Scherrer von Skan folgte mit seinem Referat der kleinste Laborisolator für CMR.
5. Swiss Cleanroom Community Event
Am 17. Oktober 2013 traf sich zum 5. Mal die Swiss Cleanroom Community zum Austausch bei Vorträgen und einem Apéro in den Räumen der Firma HUBERLAB. in Aesch BL. Die Firma HUBERLAB. als Gastgeberin des Events lud in ihre neuen Geschäftsräume im Gewerbegebiet von Aesch ein. Die ca. 50 Teilnehmenden trafen sich bei wunderbarer Abendstimmung auf der Terrasse. Hier bot sich ein erstes Mal Gelegenheit, neue Kontakte zu knüpfen und bestehende zu vertiefen.
HUBERLAB. neuer Reinraum-Partner
HUBERLAB. ist eines der führenden Schweizer Laborfachhandelsunternehmen mit Fokus im Bereich Life Science, Laboreinrichtung und Spitalbedarf. Das inhabergeführte Familienunternehmen ist seit Jahrzehnten wirtschaftlich erfolgreich und unabhängig.
Der Name HUBERLAB. steht für 45 Jahre Erfahrung und Kompetenz im Labor. HUBERLAB. verfügt über ein weltweites Netz an Geschäftspartnern, Herstellern und Lieferanten. Die Kunden in den Bereichen Chemie, Pharma, Lebensmittelherstellung, Gesundheitswesen, Hochschulen und Laboratorien aller Art profitieren davon. Die neuesten Produkte und Services werden eingesetzt, damit sich HUBERLAB. Kunden auf Ihre Kernaufgaben konzentrieren können. Der Verkauf von qualitativ hochstehenden Produkten und eine begleitende Fachberatung ist HUBERLAB.'s Kernkompetenz. Weitere Infos www.huberlab.ch
4. Swiss Cleanroom Community Event
Mit grosser Freunde denken wir an das 4. Swiss Cleanroom Community Event zurück. Wir möchten uns ganz herzlich für Ihre Teilnahme und Ihren Beitrag zu einem gelungenen Event bedanken. Besonderer Dank gebührt unserem Gastgeber ELPRO-BUCHS AG für die Bewirtung und die interessanten Referate zu aktuellen Themen.
Mit Strömungssimulation zum optimalen Reinraumdesign
Der Einsatz rechnergestützter Engineering Werkzeuge ist aus der modernen Produktentwicklung nicht mehr wegzudenken. Ebenfalls in der Planung von Reinraumanlagen und ganzen Reinräumen ist der Einsatz der Strömungssimulation heute bereits weit verbreitet. AFC Air Flow Consulting AG bietet integral und umfassende Dienstleistungen für CAE (Computer Aided Engineering), insbesondere CFD (Computational Fluid Dynamics) für die Gebäude- wie auch die Verfahrenstechnik und die Produktentwicklung an. Die ganzheitliche Unterstützung hilft bei Entwicklung und Design von Reinräumen den Planungszeitraum zu beschleunigen, die Planungsrisiken zu minimieren und gleichzeitig bessere Lösungen zu erarbeiten.
Die Anforderungen an die Produktion in reinen Umgebungen werden immer höher, die Projektführung wird immer schwieriger. Nur integrierte und automatisierte Lösungen aus einer Hand sind erfolgsversprechend, um komplexe CAE-Fragen in der Reinraumtechnik effizient bearbeitet zu können.
150 Jahre TROX HESCO Schweiz AG
Am 19. Oktober 1863 legte Rudolf Hess mit einer Schlosserwerkstatt für Baubeschläge und Eisenwaren den Grundstein zur heutigen Firma TROX HESCO Schweiz AG in Rüti ZH. Durch kontinuierliche Weiterentwicklungen, Adaption des Produktsortimentes und Anpassung an die Marktgegebenheiten konnte sich das Unternehmen bis heute stets als führender Marktteilnehmer behaupten.
Mittlerweile ist die Firma Kompetenzführer für hochwertige Komponenten, Systemlösungen und Dienstleistungen in der Lüftungs- und Klimatechnik.
Seit ihrer Gründung hat sie immer wieder Unternehmergeist, Voraussicht und ein hohes Mass an Innovation bewiesen und darf in diesem Jahr ihren 150. Geburtstag feiern. Dieses ganz besondere Jubiläum wird mit diversen Anlässen gewürdigt, unter anderem lädt die Firma TROX HESCO Schweiz AG am 7. September 2013 zum Tag der offenen Tür ein.
ELSE Automation neu eine BU der Actemium Schweiz AG
Nachdem die Controlmatic AG bereits 2004 dem Actemium Netzwerk der VINCI Gruppe beigetreten ist, folgen ab den 1.Januar 2013 die Gesellschaften ETAVIS Engineering AGund ELSE Automation AG.
Hierzu werden alle drei Gesellschaften mit Ihrem 4 Business Units (BU's) in eine neue, gemeinsamen Gesellschaft überführt.
Innovative Lösungen für bessere Energieeffizienz in Reinräumen
In kritischen Umgebungsbedingungen haben Personen- und Produktschutz oberste Priorität. Zu jedem Zeitpunkt muss gewährleistet werden, dass es zu keiner Verunreinigung des Produktes durch Querkontamination kommt und dass keinerlei aktiver oder toxischer Substanzen kontrollierte Bereiche verlassen.
5 Jahre Testo Industrial Services AG in der Schweiz
Kürzlich konnte Herr Wolfgang Hähnel, Geschäftsführer der Testo Industrial Services AG in Egg bei Zürich, mehr als 40 Teilnehmer, sowohl Kunden als auch Kooperationspartner, zur Feier des 5-jährigen Bestehens des Dienstleistungs- unternehmens im festlich geschmückten Gemeindesaal in Egg begrüssen.
Neues Firmen Video von der Firma SNDI suisse
In diesem neuen Video der Firma SNDI suisse sehen Sie wie die Reinraumkleider in mehreren Arbeitsschritten professionel auf Beschädigungen kontrolliert, gewaschen, dekontaminiert, getrockent, gefalltet, verpackt und auf Partikelabgabe kontrolliert werden. Nach der Gamma Sterilisation erfolgt die Auslieferung an den Kunden.
3. Swiss Cleanroom Community Event
Am 6. November 2012 traff sich im Seminarhotel Mittenza in Muttenz zum 3. Mal die Swiss Cleanroom Community zum Austausch bei Vorträgen und Apéro. Die Firma Siemens präsentierte mit ihrer Live Demo mit dem Thema Sicher, effizient, konform Reinraum- und Laborlösungen aus einer Hand
einen sehr interessanten Vortrag.
Rotronic AG neuer SCC Reinraumpartner
Die Rotronic wurde 1965 gegründet, befindet sich in privater Hand und wird von der Unternehmerfamilie Schroff geführt. Das Unternehmen positioniert sich als ein international ausgerichtetes Handels- und Produktionsunternehmen und bietet die unterschiedlichsten Lösungen für Händler- und Industrie-Kunden an. Ihre Geschäftsfelder umfassen Produkte für die Messung von Feuchte, Temperatur und ...
STERIS Corporation neuer SCC Reinraumpartner
STERIS Corporation ist ein führender globaler Hersteller und Anbieter von Produkten, Technologien und Dienstleistungen im Bereich Infektions-prävention, Kontaminationskontrolle, Dekontamination, Keimverminderung und Unter-stützung der chirurgischen und intensivmedizinischen Versorgung, die in der Wehrtechnik, im staatlichen Sektor, im Katastrophenschutz, Gesund-heitswesen, in der Pharmaindustrie und in Forschungseinrichtungen in der ganzen Welt zur sicheren und effektiven Prävention von Kontamination und Bekämpfung von Infektionskrankheiten eingesetzt werden.
Briem Steuerungstechnik GmbH neuer SCC Reinraumpartner
Die Firma Briem Steuerungstechnik GmbH ist ein mittelständisches Unter-nehmen mit ca. 25 Mitarbeitern mit dem Sitz in Baden-Württemberg in der Nähe von Stuttgart.
Beginnend mit dem Schwerpunkt in der Luft- und Klimatechnik haben uns die gestiegenen Marktanforderungen und unsere innovativen Lösungen zu einem kompetenten Partner für die Produktbereiche Reinraumtechnik und Anlagentechnik geformt, was sicherlich auf Flexibilität, Einfallsreichtum und einen hohen Qualitätsstandard zurückzuführen ist.
Partikelvalidierung eines neuen Sprühkopfsystems
Das neue SteriShield Delivery System sichert die anhaltende Sterilität des Sprühflascheninhalts durch die Beseitigung von Risiken, die mit dem Ansaugen von Außenluft verbunden sind. Das Ansaugen von Außenluft in die Sprühflasche, wie es bei herkömmlichen Sprühflaschen vorkommt und wodurch es zur Kontamination des Flascheninhalts kommen kann, wird sicher verhindert.
Seit seiner Einführung wurde das SteriShield Delivery System weltweit erfolgreich eingesetzt, um die Unversehrtheit von sterilen Alkoholen, Bioziden und neutralen Reinigungsmitteln in Sprühformaten aufrecht zu erhalten.
Die Validierungsstudie untersucht das potentielle Risiko eintretender Kontamination, welche durch den Sprühkopf, als einzig mögliche Eingangsstelle in das System gelangen kann. Die Studie vergleicht die Anzahl eintretender 0.5μm und 5μm Partikeln an verschiedenen Sprühköpfen, einschließlich des neuen SteriShield Delivery System Sprühkopf, um während der Anwendung eine quantifizierte Bewertung der Risiken des Ansaugens der Außenluft darstellen zu können.
Trends & News in der Reinraummesstechnik in Wattwil
Der 19. und 20. September 2012 standen im Reinraum- und OP-Show-Raum der Firma CAS in Wattwil ganz im Zeichen der beiden Seminare
„Messtechnik für den Anwender“
und
„Druck- und Prozessluftmessung“.
Herr Frank Zimmermann, Geschäftsführer von Swisscleanroomconcept begrüsste die je rund 20 Personen herzlich im Toggenburg und freute sich über das grosse Interesse an den Themen.
Accugenix, Inc. Now a Part of Charles River Endotoxin & Microbial Detection
To our valued customers
We are pleased to inform you that Accugenix, Inc., a global leader in cGMP-compliant contract microbial identification testing, is now owned by Charles River Laboratories International, Inc. This acquisition further strengthens the Charles River Endotoxin and Microbial Detection portfolio of products and services by providing clients with state-of-the-art microbial detection and identification for manufacturing in the biopharmaceutical, medical device, nutraceutical and consumer care industries. Furthermore, it marks the coming together of two industry leaders focused on providing exceptional QC testing solutions to you, our customer.
Reinstwasser im GMP-Umfeld
In der Pharma- und Biotechindustrie sind die Reinstmedien, zu denen u.a. auch das Reinstwasser gehört, die wichtigsten und kritischten Versorgungsmedien zur Aufrechterhaltung der Produktion. Aus diesem Grund unterliegen diese Anlagen, die bei der BWT Pharma & Biotech am Standort in Aesch zentral gefertigt werden, besonders hohen Qualitätsanforderungen.
Maximale Prozesswirtschaftlichkeit in der Sterilfiltration
Als kosteneffizienteste Lösung für die Sterilfiltration von Bioprozessflüssigkeiten ergänzt der neue Supor EX ECV Membranfilter (0,2 µm) das Pall Sterilfilterportfolio. Eine sichelförmige Anordnung der Membranfalten ("Laid-over-Pleat") und ein Innenstützkörper mit kleinem Durchmesser ("Narrow Core") bedeutet eine gegenüber anderen kommerziell verfügbaren Polyethersulfon-(PES)-Sterilfiltern vergrößerte Filterfläche von 1,04 m² pro 10-Zoll Element.
Darüber hinaus weisen Supor EX ECV Filter, die anströmseitig eine asymmetrische machV Membranlage besitzen, einen hervorragenden Wasserflusswert aus. Er liegt bei 100 mbar Differenzdruck oberhalb von 17 l/min pro 10-Zoll Element.
Die Kombination aus großer Fläche und hoher Flussleistung erlaubt die Auslegung sehr kompakter Systeme für maximale Prozesswirtschaftlichkeit in der Sterilfiltration hinsichtlich der anfallenden Kosten pro Liter prozessierter Flüssigkeit.
Die Drei Schritte das DDE System von Shield Medicare
Ihr Shield Ansprechpartner zeigt Ihnen, wie Sie sich vor einem Produktrückruf aufgrund von Reinigungsrückständen schützen, dabei Fehlchargen vermeiden, sowie Zeit und Geld sparen können.
Das moderne Labor: sicher, wirtschaftlich und komfortabel
Laborgebäude sind zentrale Infrastrukturen für die Forschung und Entwicklung. So wirken sich die Umgebungsbedingungen im Labor direkt auf die Personensicherheit und die Forschungsqualität aus. Strenge Richtlinien und Vorschriften sollen...
Keine störenden Ladungen beim Wägen und Hantieren mit Substanzen
Beim Wägen und Hantieren mit Substanzen in Pulverform, kann es durch elektrostatische Ladungen zu fehlerhaften Messungen und/oder Problemen beim Umfüllen kommen.
Der Spengler DC-Ionisierstab Typ AF, integriert in den Handlauf der Kabine, stellt sicher, dass durch das Hantieren keine störenden Ladungen entstehen...
Schwebstoff-Filter, wenn H10 zu E10 wird?
Die Norm für Schwebstoff-Filter EN1822 wurde im Jahre 2009 revidiert. Inzwischen ist die deutsche Übersetzung erstellt worden und damit die Norm auch hierzulande in Kraft getreten.
Die Revision 2009 wurde wiederum massgeblich von Schweizer Filterexperten mitgeprägt. Sie enthält…
Das Unsichtbare sichtbar machen
Die Faszination steckt im Detail. Schnelle Bewegungsabläufe lassen sich in Einzelsequenzen analysieren. Zudem bietet unsere Photron SA2 Highspeedkamera eine Auflösung von 2048 x 2048 Px.
Das revolutionäre Design für die Luftkeimsammlung
Eine ist sicher! - die einzigartige neue LockSure® Platte. Dieses Plattenformat wird für die 3P™ Angebotspalette* von Gamma bestrahlten Nährmedien für die Luftkeim-sammlung produziert.
Das revolutionäre Design wurde entwickelt, um nach der Probennahme in aseptischen Umgebungen und kritischen Reinräumen in Produktionsbereichen die größtmögliche Sicherheit zu gewährleisten.
Reinraumtaugliche Gebäudekonzepte
Der Produktion im Reinraum gehört die Zukunft. Die Anforderungen sind klar definiert: Das Gebäudekonzept erlaubt die Integration von autonomen Reinraumzellen, die zwar den betrieblichen Abläufen angepasst sind, aber bei veränderten Rahmenbedingungen mit wenig Aufwand angepasst werden können.
Schleusensteuerungen optimiert
Die Anforderungen an Steuer- und Regelfunktionen in Reinräumen sind sehr hoch. Die technische Umsetzung ist äusserst anspruchsvoll, da eine sehr hohe Regelgüte zum Schutz der Produkte im Innern der Reinräume garantiert werden muss.
Kostenlose Zustandskontrolle Ihrer Lüftung
Gutschein
Für eine kostenlose Zustandskontrolle Ihrer Lüftung
Neues Bedienpanel für Reinraum Monitoring
Sensoren für Monitoringsysteme in Reinräumen müssen besonders hohe Anforderungen erfüllen. Neben den Konstruktions- und Materialvorgaben für den Einsatz in steriler oder ultrareiner Umgebung werden Signalfunktion, Kompaktheit, sowie Montage- und Servicefreundlichkeit vorausgesetzt. Das neue Sensorpanel von ELPRO für den Reinraum erfüllt eben diese Bedingungen. Die Transmitter für Druck, Temperatur und Luftfeuchte sind ebenso wie eine Alarmhupe und deren Quittierung in eine reinraumgerechte Edelstahlfront eingebaut. Die Anzeigeinstrumente für die massgeblichen Grössen verfügen über eine Hintergrundbeleuchtung in grün (ok), gelb (Warnung) und rot (Alarm).
pH Neutral Derouging with Diruneutra
pH Neutral Derouging with Diruneutra - Environmentally friendly - all waste can go down the drain. Achieve spectacular results in a much shorter time then conventional passivation procedures. So easy to use, your own maintenance personnel can perform the service. Visit www.ultracleanep.com for more information.
Identifizierung von Mikroorganismen
Die Genauigkeit und damit die Qualität der mikrobiellen Identifizierung hängen ab von:
1) der Relevanz der Datenbank, ihrem Umfang und ihrer Validität
2) der qualitativen Bewertung der generierten Daten,
3) der Datenassemblierung und der daraus resultierenden phylogenetischen Distanz,
4) sowie der Interpretation der Identifizierungsergebnisse.
Drahtlose Temperatur- und Feuchtemessung
Das Zentrale Monitoring System von ELPRO übermittelt Ihre Messwerte sicher und zuverlässig und stellt Ihnen die Daten in Ihrem bestehenden LAN-Netzwerk zur Verfügung. Das System setzt sich aus Datenloggern, die Ihre Messwerte aufzeichnen sowie bei Bedarf automatisch einen Alarm auslösen und über das LAN-Netzwerk weitergeben sowie aus Sensoren, die die Werte messen, zusammen.
Sparen Sie Zeit und Geld bei Temperature Mappings
Die Einhaltung von korrekten Lagerkonditionen ist bei temperatursensitiven Produkten von zentraler Bedeutung und gerät aus diesem Grund immer häufiger in den Fokus der Auditoren.
Luftfilter richtig vergleichen!
Endlich haben es alle Käufer von Luftfiltern einfach, den richtigen Filter zu finden. Dank Eurovent.
Eurovent hat eine neutrale Energieeffizienz-Klassifizierungauch für Luftfilter geschaffen.
Unterwegs für saubere Luft und bessere Filterung
Camfil Farr befindet sich jetzt auf EuropaTournee.
Unsere Ziele sind: das Bewusstsein für die Bedeutung der Raumluftqualität schärfen, die Vorteile einer effektiven Luftfilterung aufzeigen, und erläutern, wie eine nachhaltige Raumluftqualität und ein geringerer Energieverbrauch mit der richtigen Filterauswahl verwirklicht werden können.
Partikelvalidierung des neuen Sprühkopfsystems
Für Desinfektionsmittel die zur Dekontaminierung in Reinräumen benutzt werden ist es notwendig, dass sie keine Kontamination in die Reinraumumgebung bringen. Die GMP gibt vor, dass „Desinfektionsmittel, die in den Bereichen A und B eingesetzt werden sollen, vor dem Einsatz steril sein müssen.“ Es ist jedoch auch wichtig, dass die Unversehrtheit des Desinfektionsmittels während der Verwendung aufrecht gehalten wird.
2. Swiss Cleanroom Community Event
Am 16. April 2012 traf sich im Seminarhotel Mittenza in Muttenz zum 2. Mal die Swiss Cleanroom Community zum Austausch bei Vorträgen und Apéro. Gemeldet waren 81 Teilnehmer von 45 Firmen.
1. Swiss Cleanroom Community Event
Am 31. Oktober 2011 fand sich in der Kägenstrasse 2 in Reinach die Schweizer Reinraumszene zu Ausstellung, Vorträgen und Networking ein.
Im geräumigen Foyer der Gastgeber Endress Hauser (E H) präsentierte sich beim anschliessenden Apéro die Firmen Chemgineering, VWR und Ecolab an den Ausstellertischen mit ihren aktuellen Produkten.